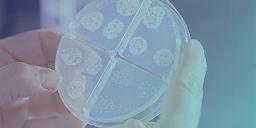

24. L’Ospedale Luigi Sacco si rinnova per una sanità più integrata e sicura [di Giovanna Serranò]
26. Qualità dei servizi ospedalieri: strategie e strumenti secondo Markas [di Giovanna Serranò]
28. RUP, il capro espiatorio perfetto [di Giovanni Coco]
32. Parità retributiva in dirittura d’arrivo: come adeguarsi? [di Simone Finotti]
34. Soft Facility Management, un nuovo standard per il monitoraggio [di Carlo Ortega]
38. Aggressioni in ospedale, servono approcci sistemici [di Giuseppe Fusto]
42. Dagli ospedali ai pronto soccorso: il presidio di sicurezza firmato Istituto di Vigilanza Coopservice [di Giovanna Serranò]
46. Rating di legalità: gli effetti del nuovo regolamento AGCM nel settore sanitario [di Massimiliano Brugnoletti]
48. Dalle Alpi alla Sicilia, il procurement sanitario fa rete [dalla Redazione]
52. Exposanità 2026: sfide e opportunità della sanità digitale italiana [dalla Redazione]
54. Dermatite da Pyemotes, difficoltà diagnostiche e implicazioni nel pest management [di Lorenzo Donati]
58. TTR vs TNT, uno studio li mette a raffronto [di Umberto Marchi]
62. Quel rischio invisibile e (a volte) letale [di Simone Finotti]
66. Non solo automazione: il ruolo strategico della pulizia manuale in sanità [di Simone Finotti]

Casa Editrice
Direzione, Amministrazione, Redazione e Pubblicità: EDICOM srl info@gsanews.it - www.gsanews.it
Sede legale: Via Zavanasco, 2 20084 Lacchiarella (MI)
Sede operativa: Via Alfonso Corti, 28 - 20133 Milano Tel 02/70633694
Direttore Responsabile: GIOVANNA SERRANÓ
Redazione: ANDREA BARRICA, CHIARA CALATI, SIMONE FINOTTI, ANTONIA RISI
Segreteria: BARBARA AMORUSO - Diffusione: GIOVANNI MASTRAPASQUA
Sviluppo e pubblicità: ANDREA LUCOTTI, MARCO VESCHETTI
Progetto grafico: IPN Milano - Composizione, grafica e impaginazione: STUDIO GOMEZ
Copia 2,58 Euro - Abbonamento annuo € 70.00 - CCP 38498200
Fotolito: STUDIO GOMEZ - COLOGNO MONZESE (MI)
Stampa: Centro Poligrafico Milano
Autorizzazione del Tribunale di Milano n° 633 del 19/10/1996. La pubblicità non supera il 50% del numero delle pagine di ciascun fascicolo della rivista. La Casa editrice declina ogni responsabilità per possibili errori ed omissioni, nonché per eventuali danni risultanti dall’uso dell’infor-mazione contenuta nella rivista. Le opinioni espresse dagli autori negli articoli non impegnano la direzione della rivista. Parimenti la responsabilità del contenuto dei redazionali e dei messaggi pubblicitari è dei singoli. “Ai sensi delle regole deontologiche relative al trattamento dei dati personali nell’esercizio dell’attività giornalistica, si rende nota l’esistenza di una banca-dati personali di uso redazionale presso la sede di Via Alfonso Corti, 28 - Milano. Gli interessati potranno rivolgersi al responsabile del trattamento dei dati sig.ra Barbara Amoruso presso la sede di Milano, Via Alfonso Corti, 28 per esercitare i diritti previsti dal Regolamento EU 2016/679
ASSOCIAZIONE NAZIONALE EDITORIALE DI SETTORE
EDICOM srl - Milano

Irobot di pulizia si stanno rapidamente diffondendo in vari settori (industria, logistica, alberghi, palestre …) in quanto eseguono attività ripetitive su ampi spazi od in zone non accessibili, con o senza la presenza dell’uomo. Per applicazioni in ambito sanitario, a questi vantaggi comuni a vari settori, dobbiamo aggiungerne un secondo: il soddisfacimento di esigenze specifiche, qui indicate: Tracciabilità delle operazioni eseguite: nella sanità, importante non è “semplicemente pulire”, ma occorre anche dare evidenza dell’attività svolta (certificazione importante per raggiungimento sistemi di qualità e per dimostrare l’esecuzione in caso di contenziosi).
Separazione del compito pulizia da quello di sanificazione: l’attività di pulizia semplice con prodotti tradizionali deve essere seguita da un processo di sanificazione che richiede competenza ed attenzione, non sempre assicurate dal personale incaricato; il robot CC1 esegue perfettamente ed in modo affidabile questo compito, distribuendo il prodotto idoneo (battericida, sanificante …) nelle dosi prescritte, ovunque, fornendo evidenza scritta e inattaccabile.
Possibilità di lavorare quando non ci sono persone, ad esempio, di notte: immaginate un reparto ospedaliero nel quale le pulizie dei corridoi o delle sale sono eseguite di notte, quando i pazienti dormono e non c’è movimento di personale; un robot silenzioso ed autonomo lavora per


voi e vi farà trovare al mattino tutto pulito e sanificato. Non immaginiamo una fantasia, ma una concreta realtà applicabile con una spazzatrice MT1.
Chi opera in ambito sanitario non ha da gestire soltanto strutture di ricovero, ma anche reparti industriali ove vengono preparati medicinali, dispositivi o sterilizzate attrezzature. In questo caso il contesto è una sala bianca dove l’igiene va garantita (certificata, vedi sopra!) ma in cui l’ingresso e l’uscita comportano vestizione (perdita di tempo e costi). Ebbene i robot si muovono in questi contesti senza problemi, ecco alcuni casi di successo: Sala bianca di azienda che produce prodotti medicali per dialisi. Un robot “MT1 Vac” pulisce ogni due ore il pavimento, confinato nella sala senza contaminazioni dell’esterno; Trasporto materiale da linee produttive in sala bianca all’esterno. Un robot T300 prende i carrelli a fine linea e li porta all’uscita della sala, apre le due porte automatiche e scarica su una rulliera “sul confine”, ritornando all’interno; Lavaggio di pavimenti in una ditta che produce materiale sterile per sale operatorie. Il robot “CC1 pro” (senza bisogno di cuffie, sovrascarpe e mascherine) lava ogni tre ore il pavimento col disinfettante prescritto ed indugia su zone
più sporche, per garantire il livello richiesto (la zona di manutenzione quotidiana del robot si trova in un ingresso tra le due porte).
Una esigenza di tutti gli operatori che lavorano in contesti sanitari è garantire sempre un servizio continuo ed è nato come invece le macchine ed ovviamente anche i robot possono guastarsi. Proprio per questa ragione in VHIT Robotics è stato strutturato un servizio di assistenza con sostituzione del robot in tempi rapidi per non lasciarvi mai in difficolta. L’azienda offre una prova presso le vostre strutture, per farvi scoprire come il robot di pulizia possa essere il vostro più sicuro, affidabile ed economico alleato per vincere le prossime sfide. www.vhitrobotics.com
Prima ancora che “green” diventasse di moda, Falpi iniziava un percorso di “produzione sostenibile” che prosegue tuttora, con immutata convinzione.
Oltre ai numerosi prodotti CAM/GPP, infatti, è ampia la gamma di carrelli che vantano l’etichetta Epd che determina l’impatto ambientale dei prodotti sull’intero ciclo di vita, certificati recentemente anche sull’impronta climatica secondo la norma UNI EN ISO/TS 14067 (Carbon Footprint).
Estesa è anche la gamma di articoli certificati ReMade in Italy, consci del fatto che Falpi è stata la prima azienda del settore ad ottenere questa certificazione; e ampia è anche la gamma di panni e frange che hanno conseguito l’etichetta Ecolabel, costituendo un precedente di grande importanza, perché, anche in questo caso, Falpi è stata pioniera, e oggi può garantire la massima compatibilità ambientale possibile su una vasta selezione di prodotti tessili e in particolare sulle frange di lavaggio in microfibra.
Oggi “sostenibilità ambientale” è un mantra che accompagna ogni comunicazione aziendale, per questo il motto di Falpi è “Ecological Unbreakable Beauty”. Non ci sono aziende manifatturiere o imprese di servizi che non esaltino comportamenti virtuosi nei confronti dell’ambiente o non evidenzino il carattere “green” della propria produzione.


Si insegue l’obiettivo dell’economia circolare, nuovo traguardo da raggiungere, per quanto non a tutti sia chiaro il percorso da intraprendere e a volte si equivochi: adottare politiche di riduzione dei rifiuti, di abbattimento dei livelli di inquinamento, di incremento della durabilità dei prodotti, sono solo piccoli passi, a volte solo degli alibi. Ma è indispensabile esibire una patente ecologica, perché gli allarmi sulle condizioni del pianeta non sono più solo allarmismi, ma evidenze di un male che rischia di diventare incurabile.
Falpi è nata ecologista, perché il rispetto per l’ambiente da sempre è inscritto nel suo DNA e, da sempre, da quando è sorta, oltre trent’anni or sono, ha perseguito una politica verde, coniugata con un profondo rispetto sociale, che significa trasparenza di comportamenti e ricerca costante di una innovazione che fosse anche arricchimento culturale per tutto il settore.
Da tempi non sospetti, quando parlare di qualità, di ambiente, di ecologia era considerato per lo meno eccentrico, Falpi ha intrapreso percorsi pionieristici, con tenacia, determinazione, convinzione, certificando processi, prodotti, sistemi, in un continuum di attenzione all’uomo e all’ambiente, che non ha mai avuto battute d’arresto, e che
continua ancora oggi, con immutato entusiasmo. Non solo, in un mondo dove si cerca sempre più di delocalizzare la produzione in Paesi a basso costo di manodopera, Falpi ha scelto di essere fedele alla qualità del vero Made in Italy, difendendo il valore della produzione italiana perché la filosofia dell’azienda è approntata a un’etica da perseguire in ogni fase, dal progetto alla realizzazione, al post-vendita. www.falpi.com


La salute e la sicurezza sul lavoro sono obblighi normativi fondamentali, tutti devono rispettarli, e proprio per questo spesso vengono percepiti come meri adempimenti burocratici. Per molti lavoratori, le regole sono una lista di controlli da completare, senza un reale impatto sulla quotidianità.
Markas però ha scelto un approccio diverso. Con oltre 10.000 collaboratori solo in Italia, la gestione della salute e sicurezza non può limitarsi al minimo necessario, ma può e deve diventare un valore che coinvolge tutti i livelli dell’azienda e si estende anche agli appalti più piccoli.
La Safety Week: formazione, ascolto e digitalizzazione Al centro della strategia di Markas c’è la Safety Week, un’iniziativa periodica che unisce formazione, ascolto e strumenti operativi digitalizzati. I preposti utilizzano checklist digitali per pianificare e monitorare le attività, riducendo il rischio di dimenticanze e semplificando la gestione quotidiana della sicurezza. Complessivamente, per la prima edizione del 2026, sono stati coinvolti più di 500 appalti e inviate 323 checklist, ciascuna corrispondente a un luogo di lavoro, permettendo così di avere un controllo capillare e puntuale su tutte le strutture.
Durante questa settimana, che si ripete più volte durante l’anno, l’ufficio HSE affianca fisicamente i collaboratori negli appalti, osserva le attività, risponde a domande e raccoglie suggerimenti. Nell’ultima edizione, 9 appalti sono stati affiancati concretamente, contribuendo a consolidare comportamenti sicuri e a diffondere
una cultura condivisa. L’ascolto dei collaboratori è centrale. Brevi questionari e momenti di confronto permettono di comprendere le esigenze di chi opera sul campo e introdurre miglioramenti concreti. La digitalizzazione supporta questo processo, rendendo più efficace la raccolta dei dati e il monitoraggio delle azioni correttive, in un ambito tradizionalmente visto come puramente normativo. L’iniziativa coinvolge tutti i lavoratori e, complessivamente, più di 2000 figure con un incarico legato al sistema salute e sicurezza aziendale.
Vantaggi concreti per clienti e persone
Il beneficio per i clienti si traduce in servizi più affidabili e senza interruzioni. Un’organizzazione che mette la sicurezza al centro riduce non solo i rischi operativi, ma anche possibili inefficienze e imprevisti. Gli operatori, lavorando in ambienti più sicuri e supportati da strumenti digitali, sono più sereni e motivati, con un conseguente aumento della qualità del servizio.
Anche i collaboratori traggono vantaggio da un approccio concreto alla sicurezza: affiancamenti sul campo, momenti di ascolto e formazione mirata consolidano comportamenti sicuri e aumentano la consapevolezza individuale, rafforzando la cultura aziendale a tutti i livelli.
In sostanza, ciò che per legge è un obbligo diventa per Markas uno strumento tangibile di valore. Proteggere le persone garantisce continuità ai clienti e contribuisce a costruire un servizio più efficace. www.markas.com
Nel settore della distribuzione per il cleaning professionale continua a prendere forma uno dei progetti industriali più interessanti degli ultimi anni: il percorso di integrazione tra Socaf, Bottoni e Tecno Clean, tre realtà che stanno convergendo in modo sempre più strutturato verso un modello comune.
Dopo l’annuncio della fusione, inizialmente prevista per il 1° gennaio 2027, ci si è resi conto come il progetto stia procedendo più velocemente di quanto si pensasse, con un’evoluzione che sta superando le previsioni iniziali: le tre aziende, infatti, stanno già lavorando in modo sempre più integrato e coordinato, tanto che la nascita della nuova società unica potrebbe avvenire anche prima della data inizialmente indicata, in funzione dell’avanzamento delle attività comuni.
di come il gruppo stia iniziando a operare sempre più come un’unica organizzazione integrata, pur mantenendo formalmente tre società distinte fino al completamento effettivo della fusione e del processo societario. Questo processo di integrazione progressiva consente di costruire con calma, gradualità e solidità il nuovo assetto industriale, testando sul campo le sinergie tra le diverse strutture
la convinzione che questa unione rappresenti una grande opportunità non solo per le imprese coinvolte, ma anche per l’intero mercato del cleaning professionale, che potrà beneficiare di un operatore più strutturato e integrato.
L’obiettivo è quello di creare una realtà capace di unire la solidità e l’esperienza di tre storie imprenditoriali importanti, diverse nei settori di specializzazione e per questo pronte ad un arricchimento reciproco senza precedenti, con una visione moderna del settore che punta su più integrazione, più servizi, maggiore efficienza logistica e una relazione sempre più consulenziale e continuativa con i clienti.

Ma soprattutto, la fusione non è più soltanto un progetto sulla carta: le sinergie operative sono già realtà e si esprimono nella quotidianità attraverso un importante e continuo processo di integrazione, che coinvolge diversi ambiti strategici e organizzativi: dalla selezione di un nuovo gestionale unico - che costituirà la piattaforma digitale centrale della futura società - alla razionalizzazione e armonizzazione dei rapporti con i fornitori, fino all’avvio di una gestione sempre più coordinata e strutturata delle attività logistiche. In diversi casi sono già partite operazioni condivise tra loro, con ritiri dai fornitori e consegne ai clienti gestiti in modo coordinato e congiunto, secondo logiche operative sempre più uniformi. Un segnale concreto
e migliorando progressivamente i processi operativi prima della nascita ufficiale della nuova società, in un’ottica di affinamento continuo.
Questa caratteristica operazione societaria è unica nel panorama del nostro settore, sia per le dimensioni di fatturato degli attori coinvolti, che portano l’aggregato direttamente alle prime posizioni in termini di quota di mercato, sia perché si è potuto pianificare con attenzione il tempo necessario alla integrazione dei sistemi di gestione, senza pressioni esterne o fattori che costringano all’urgenza o a scelte accelerate.
L’entusiasmo all’interno delle tre aziende è molto forte e diffuso a tutti i livelli organizzativi.
Soci, manager e collaboratori condividono
La nuova società che nascerà da questa fusione non sarà semplicemente una struttura più grande, ma un progetto industriale pensato in modo organico e strategico per affrontare le trasformazioni del mercato della distribuzione nel cleaning professionale nei prossimi anni. Il percorso è ormai avviato e in costante sviluppo. E mentre si avvicina il momento in cui le tre aziende diventeranno ufficialmente un’unica realtà, Socaf, Bottoni e Tecno Clean stanno già dimostrando concretamente che collaborare e fare sistema può essere il vero motore dell’innovazione nel settore.

La gestione dei rifiuti a rischio infettivo è un’attività silenziosa ma strategica, che richiede attenzione, rapidità e competenze. Le strutture sanitarie devono mantenere in equilibrio un sistema complesso, tra normative severe, flussi delicati e costi in crescita. Quando le procedure si complicano, tutto rallenta: operatori più esposti e reparti meno efficienti. In questo contesto, il modello tradizionale di trasporto e smaltimento esterno mostra i suoi limiti. I rifiuti sanitari pericolosi richiedono un trattamento immediato e rigoroso, con trasporto ADR, un’impronta ambientale rilevante e un forte carico di responsabilità. Un meccanismo fragile, costoso e rischioso.
E se tutto potesse diventare più semplice, più sicuro, più sostenibile? Con SWS – Steril Waste System, la divisione di So.Ge.Si. S.p.A. dedicata alla sterilizzazione on-site, questo scenario è già realtà. Grazie al suo know-how So.Ge.Si. Spa, storica azienda italiana attiva da anni nei servizi integrati per la sanità e le aziende, porta con SWS un nuovo modello negli ospedali: la sterilizzazione direttamente dove il rifiuto nasce. SWS – Steril Waste System unisce triturazione e sterilizzazione in un unico ciclo, trasformando i rifiuti infettivi (CER 18.01.03 e 18.02.02) in rifiuti urbani indifferenziati (CER 20.03.01).
Un cambio radicale
Il vero vantaggio si vede nella quotidianità. I reparti hanno meno procedure da gestire, il rischio per gli operatori diminuisce e l’organizzazione interna si semplifica. Le strutture registrano una riduzione dei costi fino al 50% e un taglio delle emissioni di CO₂ fino al 70% grazie all’eliminazione dei trasporti, degli imballaggi monouso e del ricorso all’incenerimento.
FOCUS CENTRALE SWS – Steril Waste System
Installazione flessibile
ideale anche in spazi ridotti o in unità mobile
Percorsi sicuri area sporca e pulita separate da Air Lock
Sterilizzazione avanzata
vapore saturo secco + trituratore interno
Ambiente controllato trattamento aria e condense, pompa a secco a basso consumo
ROT in economia circolare tunnel di disinfezione e asciugatura
Massima sicurezza
sterilizzazione SAL 10-6, disinfezione ROT SAL 10-4
Tracciabilità totale software proprietario + cloud conforme UNI 10384
Inoltre, con la sterilizzazione in situ si riduce in modo sostanziale la responsabilità del produttore, il presidio sanitario e la sua direzione: una volta sterilizzati e declassati a rifiuti urbani, il materiale esce dal regime dei pericolosi e non richiede più gli adempimenti e gli obblighi legati al trasporto ADR. Per la direzione sanitaria significa minori oneri normativi e un perimetro di rischio molto più contenuto.
La centrale SWS, installabile anche in spazi ridotti o in unità mobile, è progettata con flussi materiale e personali sicuri per gli operatori e per il contenimento ambientale: area sporca e area pulita sono separate da un Air Lock che evita contaminazioni incrociate. Le sterilizzatrici a vapore saturo secco e con trituratore interno, il sistema di trattamento aria e condense, il tunnel di disinfezione (SAL 10-4) e asciugatura dei ROT riutilizzabili, la pompa a secco a basso consumo, creano un ecosistema efficiente, tracciato da un software cloud proprietario conforme alla UNI 10384, derivato dalle centrali di sterilizzazione dello strumentario chirurgico.
Adottare la sterilizzazione in situ non significa solo ottimizzare un processo: significa scegliere un modello più sicuro, più sostenibile, efficiente ed economico, capace di rispondere alle esigenze di una sanità più moderna. SWS permette alle strutture di lavorare con meno pressioni, meno rischi e maggiore serenità per chi, ogni giorno, ha la responsabilità della salute delle persone.
So.Ge.Si. Spa, con la divisione SWS – Steril Waste System e la tecnologia avanzata dei dispositivi SMI Medical, della quale è partner esclusivo, offre l’unica soluzione completa e sicura per la gestione e la sterilizzazione dei rifiuti sanitari pericolosi a rischio infettivo. Contatti: Tel. (+39) 075 599 0396 - info@sogesispa.it

Icoguanti Spa, leader nei dispositivi di protezione individuale e parte del gruppo Dipped Products Plc (DPL), tra i primi 5 produttori di guanti al mondo, con oltre 2.500 collaboratori, presenza in 70+ Paesi e 8 stabilimenti, presenta il programma DPL Pulse. Il percorso integra le aspirazioni ESG al 2030, definendo strategie e azioni per rigenerare il pianeta, promuovere il progresso reciproco e valorizzare l’ecosistema di partner e comunità, segnando un passo chiave verso la sostenibilità.
ESG è un acronimo che sta per Environmental (Ambiente), Social (Sociale), Governance (Gestione aziendale) e identifica i tre pilastri fondamentali utilizzati per valutare la sostenibilità, l’etica e l’impatto a lungo termine di un’azienda, andando oltre le sole performance finanziarie.
“È con questa convinzione - sottolinea Andrea Certusi, CEO Icoguanti SpA - che presentiamo la nostra Roadmap ESG, DPL Pulse, incarnazione del nostro spirito e della nostra missione. DPL Pulse segna un passo importante nel nostro impegno verso la tutela ambientale, la crescita inclusiva e una governance solida, promuovendo una cultura della sostenibilità e coinvolgendo tutti gli stakeholder.
L’integrazione di questi principi garantirà una creazione di valore sostenibile e ci aiuterà ad affrontare sfide globali, cogliendo anche le opportunità emergenti.
I nostri obiettivi sono allineati agli SDG delle


Nazioni Unite, con indicatori chiari per monitorare i progressi, comunicati annualmente in un Rapporto aggiornato regolarmente”. Entrando nel dettaglio, sono state individuate cinque aree ESG prioritarie che si ritiene possano avere un impatto significativo sulla capacità aziendale di generare valore.
AMBIENTE, ottimizzando l’utilizzo delle risorse naturali nei processi aziendali e riducendo al minimo gli impatti negativi sull’ambiente.
PRODOTTO, promuovendo la circolarità lungo tutto il ciclo di vita, a partire dalle fasi di progettazione e di innovazione.
PARTNER, orientando le relazioni con fornitori e clienti e coinvolgendo le comunità nella sostenibilità verso un commercio equo.
PERSONE, sensibilizzandole e orientandole, a partire da tutti i collaboratori del Gruppo, a comportamenti sostenibili, inclusivi e di benessere.
GOVERNANCE, coordinando e valorizzando le quattro precedenti aree con piena rispondenza alla normativa, con misurazioni e reporting accurati, con la promozione di etica e cultura eco-sostenibile.
In qualità di produttore, l’azienda si impegna ad integrare questi principi nelle proprie pratiche. È un’azione di responsabilità verso un contesto sociale e ambientale in profondo cambiamento e sempre più soggetto a molteplici rischi di destabilizzazione, a partire da quelli economici, geopolitici, sociali, ambientali e tecnologici. Chi è in una posizione di leadership ha infatti il dovere di valutare il contesto in cui opera e agire per mitigare il rischio, valorizzando le risorse disponibili e tramandandole alle future generazioni. Per maggiori dettagli o se volete ricevere il Rapporto Annuale non esitate a contattare Icoguanti SpA. info@icoguanti.it
All’interno di ospedali e RSA, la pulizia rappresenta la prima linea di difesa contro le Infezioni Correlate all’Assistenza (ICA). È essenziale adottare protocolli che assicurino la massima rimozione dei patogeni senza gravare sull’ambiente. TTS si impegna quotidianamente in questa sfida offrendo soluzioni in grado di rendere la pulizia più efficace ed efficiente, integrando microfibre ad alte prestazioni e sistemi di controllo avanzati per garantire igiene clinica e tutela ambientale.
Infallibili contro i microrganismi
Nella pulizia professionale l’igiene non ammette distrazioni negli ambienti ad alto rischio. Le microfibre TTS sono progettate per pulire in profondità, ben oltre lo sporco visibile, grazie a un’azione meccanica ad alta capacità di raccolta. Tra le soluzioni più indicate si distinguono i ricambi Microblue, Microred e Microsafe e il panno semi-monouso Exon. Test di laboratorio condotti da un ente esterno hanno mostrato risultati eccellenti nella rimozione dei microrganismi anche senza detergenti: eliminano il 99,99% dei batteri Staphylococcus aureus, Enterococcus hirae e Pseudomonas aeruginosa, oltre al fungo Candida albicans. Prove specifiche indicano un’efficacia comprovata anche contro il Coronavirus 229E, con una riduzione del 99,9% per Microblue e Microred e del 99% per Exon. Una raccolta così efficace permette di ridurre quantità e aggressività del chimico necessario a garantire l’igienizzazione, limitando il rischio di favorire batteri resistenti ai disinfettanti.
Sostenibilità certificata e basso rilascio di microplastiche
L’elevato potere assorbente di queste microfibre aumenta l’autonomia di lavaggio e contribuisce al risparmio d’acqua ogni giorno.
Numerosi ricambi hanno inoltre ottenuto la prestigiosa certificazione Ecolabel UE, che ne attesta la sostenibilità lungo tutto il ciclo di vita, la resistenza nel tempo e l’assenza di sostanze nocive per la salute. A ulteriore tutela dell’ambiente e della catena alimentare, i panni


manuali Allice Eco, i fronte-retro Tri Wet 1 e i ricambi Microblue, Microred, Soft Band, Microsafe e Ultrasafe hanno superato specifiche analisi classificandosi a basso rilascio di microplastiche in fase di lavaggio.
Prevenzione della contaminazione: Dosely e Pockety
Per abbattere il rischio di contaminazione crociata tra i reparti è decisiva la corretta gestione dei ricambi. Con l’impregnazione “on demand” della stazione Dosely si prepara il panno poco prima dell’uso, regolando il dosaggio da 50 a 350 ml in base alla zona da trattare. In questo modo si preparano solo i panni realmente necessari, assicurando la massima efficacia del disinfettante ed evitando sprechi. La stazione è inoltre totalmente meccanica, non richiede energia elettrica o batterie. Il ciclo si chiude in totale sicurezza con Pockety, il sistema innovativo che permette lo sgancio touch-free del panno, evitando all’operatore qualsiasi contatto con le fibre sporche. Infine, il rigoroso utilizzo del codice colore aiuta a separare nettamente le aree di rischio, rendendo le procedure sanitarie più rapide, intuitive e infinitamente più sicure.

www.ttsystem.com
Nell’ultimo anno si parla sempre più frequentemente dei controlli relativi ai servizi di pulizia e disinfezione, in particolare in ambito sanitario. Tuttavia, molta meno attenzione viene dedicata alle modalità con cui tali controlli dovrebbero essere condotti e ai parametri effettivamente oggetto di valutazione. Tra gli indicatori di qualità rientrano innanzitutto gli aspetti organizzativi e procedurali. In questo ambito si valutano il rispetto dei piani di pulizia programmati, la verifica dei processi operativi e delle procedure applicate, l’utilizzo corretto dei prodotti detergenti e disinfettanti, il rispetto delle diluizioni previste e dei tempi di contatto, la formazione e l’addestramento degli operatori, nonché la tracciabilità delle attività svolte e della corretta esecuzione del servizio. La qualità igienica delle superfici viene invece generalmente valutata attraverso diverse metodologie di monitoraggio, tra cui l’ispezione visiva, i test di bioluminescenza ATP, che consentono una valutazione indiretta della contaminazione organica, e le analisi microbiologiche, effettuate mediante tamponi superficiali e processate presso laboratori accreditati. Tuttavia, è necessario interrogarsi sull’effettiva rappresentatività dei controlli effettuati. Nella pratica operativa, infatti, l’ispezione visiva e i tamponi di bioluminescenza ATP, interessano generalmente una quota estremamente limitata delle superfici presenti in una struttura, spesso inferiore allo 0,01% della superficie totale trattata. Ne deriva che la grande maggioranza delle superfici rimane, di fatto, non direttamente verificata nell’ambito dei controlli di routine, sono dei punti ciechi. Questo aspetto assume particolare rilevanza se si considera che le comunità microbiche organizzate in biofilm tendono a svilupparsi preferenzialmente in aree difficilmente accessibili alle operazioni di pulizia, quali fessure, giunzioni, superfici irregolari o zone soggette a minore attenzione operativa. Di conseguenza, proprio le aree meno frequentemente oggetto di verifica possono rappresentare potenziali serbatoi di contaminazione microbiologica, con possibili implicazioni per l’efficacia complessiva delle procedure di sanificazione. I biofilm non crescono dove è facile pulirli. Crescono dove nessuno guarda. Ecco perché FMSpecialist, quale esclusivista

per l’Italia nel Settore sanitario, propone l’utilizzo della tecnologia BioDtex Lamp UV-A che evidenzia istantaneamente i contaminanti, come biofilm, agenti patogeni sulle superfici in tempo reale, rendendolo un sistema di monitoraggio ideale per i team tecnici, di qualità e igiene per aiutare a migliorare i sistemi di pulizia e disinfezione per eliminare i biofilm e migliorare gli standard di igiene delle superfici utilizzando interventi mirati. BioDtex Lamp UV-A è dotato di LED appositamente progettati per rilevare i microrganismi sulle superfici. I microrganismi emettono una fluorescenza distinta. La funzione di acquisizione delle immagini della lampada BioDtex migliora i controlli fornendo una chiara registrazione visiva delle superfici, aiutando a identificare le aree ad alto rischio e garantendo il continuo rispetto degli standard di sicurezza. Progettato per i professionisti, BioDtex Lamp UV-A è intuitivo e richiede una manutenzione minima, facilitando il monitoraggio e la gestione delle ispezioni. BioDtex Lamp UV-A non aumenta il carico di lavoro. Riporta l’attenzione a dove risiede effettivamente il rischio. Meno casualità. Più controllo. www.fmspecialist.eu

WeItalia è una società di consulenza e distribuzione di prodotti, servizi e sistemi di Pulizia Professionale. Rappresenta una vasta rete distributiva presente su tutto il territorio nazionale, e fa parte di DHYS, grande gruppo europeo di professionisti del pulito. Le attività di We Italia sono guidate dallo sviluppo sostenibile. Grazie alla capillarità sul territorio, si limitano le emissioni di CO2, garantendo al contempo la tempestività di consegne, consulenza, assistenza e formazione. L’ampia gamma di prodotti a marchio We Italia è frutto della ricerca e dell’esperienza dei più grandi produttori nazionali e internazionali. Tra le linee già affermate: i disinfettanti PMC We Clean DES, i detergenti per ogni ambiente We Clean e Fast&Go, i super concentrati We Mix, gli articoli in carta We Soft e Tissue, le microfibre We Cleaner, la linea cortesia Feel Wellness.
Oltre alla gamma di prodotti a marchio, l’offerta di We Italia è completa e trasversale: macchinari, chimici, monouso, carta, attrezzature. I servizi includono noleggio e assistenza per macchinari di tutte le tipologie – lavatrici industriali, lavastoviglie, lavasciuga… Tra i principali vantaggi per i clienti con più sedi di consegna in Italia, sono da elencare: un unico referente commerciale per prodotti e servizi uniformi su tutto il territorio; la possibilità di fornire ai clienti reportistica e analisi per ciascun centro di costo; consulenza e formazione in loco costanti, la possibilità di incrementare il rating ESG.
Nel contesto sanitario attuale, caratterizzato da una crescente complessità gestionale e da standard qualitativi sempre più elevati, le strutture come RSA, cliniche private e realtà ospedaliere sono chiamate a evolversi rapidamente. In questo scenario, We Italia si propone come partner strategico affidabile, con una case history di successo basata sulla collaborazione con alcune delle realtà più importanti del settore. I tecnici commerciali provvedono a sopralluoghi per ogni singola struttura, al seguito dei quali compilano report dettagliati in cui, in base alla situazione rilevata, indicano tutte le soluzioni di servizio e di prodotto da proporre.
Particolare attenzione è dedicata ai protocolli di igiene e sanificazione per ogni singolo

ambiente all’interno delle strutture, in ottemperanza alle normative vigenti. Le soluzioni proposte integrano prodotti certificati, sistemi di dosaggio controllato e procedure operative studiate per garantire elevati standard igienici, e per ottimizzare tempi e risorse del personale. Questo e tanti altri servizi di consulenza e formazione sono ricamati su misura per ogni sede sul territorio italiano. Grazie all’approccio orientato all’innovazione e alla qualità, We Italia supporta le organizzazioni nella gestione efficiente delle attività quotidiane, contribuendo al miglioramento dei servizi offerti a pazienti e ospiti.
Collaborare con We Italia significa scegliere un partner che accompagna le strutture in un percorso di crescita e miglioramento continuo. Un interlocutore unico, capace di semplificare la gestione e creare valore nel tempo.
We Italia sarà presente per la prima volta a Exposanità, all’interno del Padiglione Terza Età. Sarà possibile toccare con mano le nuove soluzioni per il settore Ospedaliero/ RSA e non solo, partecipare alla prova dei prodotti, ricevere omaggi e tante altre novità. PADIGLIONE 22 STAND C41 www.we-italia.it


è il sistema integrato di noleggio, ricondizionamento e tracciabilità di mops e panni tecnici proposto da LIM in tutta Italia.
Avvalersi di LIMOP significa:
• Rispettare il Decreto del 29 Gennaio 2021, istitutivo dei Criteri Ambientali Minimi per l’affidamento dei servizi di pulizia di edifici e ambienti sia ad uso civile che sanitario.
• Rispettare il Decreto del 9 Dicembre 2020, istitutivo dei CAM per l’affidamento dei servizi di lavanolo del materiale tessile.
• Disporre delle informazioni e delle certificazioni ormai richieste di prassi dalla magistratura, nelle indagini sulla responsabilità della contrazione di Infezione durante un intervento chirurgico o ricovero presso un ospedale o casa di cura.
• Disporre delle informazioni necessarie al controllo di gestione analitico per commessa o cantiere e per la redazione del bilancio ambientale.
Mops e panni vengono forniti al cliente:
• in quantità e con una frequenza concordate;
• asciutti e pronti all’uso, pre-impregnati a secco col principio attivo detergente, da riattivare mediante immersione in sola acqua prima dell’utilizzo;
• veicolati con attrezzature, uomini ed automezzi di LIM;
• sempre tracciati e rendicontati per quantità ricevute e per prodotti consumati in fase di ricondizionamento ed impatto ambientale.
Il processo di ricondizionamento è praticato nel rispetto dei parametri stabiliti dalla norma UNI EN 14065, la quale definisce il sistema RABC (Risk Analysis and Biocontamination Control) per le lavanderie industriali. È dunque garantita la qualità microbiologica dei tessili trattati, prevenendo la biocontaminazione, aspetto imprescindibile in ambito sanitario.
L’approccio RABC, basato sull’analisi dei rischi e il controllo della biocontaminazione lungo tutto il processo - dalla raccolta alla riconsegna - si pone l’obiettivo di assicurare igiene costante, prevenire infezioni e differenziarsi sul mercato.



Con LIMOP, il personale dell’impresa di pulizia rivolge il proprio impegno soltanto alla sanificazione delle superfici ed a riporre i dispositivi tessili usati in un sacco, garantendo a se stessi, agli operatori ospedalieri ed ai pazienti, ambienti puliti a regola d’arte, con la sicura consapevolezza di potersi avvalere di prodotti certamente puliti, perché trattati medianti processi consolidati e controllati. Limop, un passo avanti nella giusta direzione. www.limlavanderia.it
Lastorica linea di carrelli multiuso Alpha festeggia vent’anni all’insegna dell’innovazione. Nata dall’intuizione di creare un sistema modulare “su misura”, in due decenni Alpha ha ridefinito gli standard del cleaning professionale. Nelle strutture sanitarie, dove la prevenzione delle infezioni correlate all’assistenza e le rigorose condizioni igieniche sono priorità assolute, Alpha risponde alle delicate sfide cliniche con versioni studiate appositamente per gli ospedali. Per il controllo del rischio infettivo, spicca l’eccellenza dei carrelli Alpha A-B Plus, realizzati con speciali componenti in plastica antibatterica. Questo trattamento protegge

le superfici dalla proliferazione di batteri, funghi e muffe, garantendo ad operatori e pazienti il massimo livello di igiene. La sicurezza si estende alle aree cliniche più delicate con Alpha Metal Free. È il primo carrello multiuso al mondo progettato per essere totalmente privo di componenti metalliche: 100% in plastica, fino alla componentistica più minuta come viti e perni. Questa straordinaria innovazione consente l’accesso in totale libertà nelle camere di risonanza magnetica, eliminando qualsiasi interferenza con le apparecchiature. Il principio base per una corretta sanificazione in corsia è usare un panno sempre pulito per ogni stanza. La gamma Alpha soddisfa questo standard supportando due sistemi d’eccellenza. Il sistema Top-Down,


tramite l’uso di secchi ermetici da 20 litri, consente la pre-impregnazione “a monte” dei panni, assicurando una profonda igiene. In alternativa, l’innovativo dosatore meccanico Equodose permette l’impregnazione “on demand” direttamente sul carrello. Equodose eroga la precisa quantità di soluzione detergente (da 50 a 350 ml) solo sui panni effettivamente necessari, contrastando la contaminazione crociata e azzerando gli sprechi.
L’elevato livello di sicurezza per i degenti è rafforzato dalla struttura stessa di Alpha grazie a un vero salto di qualità: il sistema di chiusura automatica. Completamente integrato nel carrello, consente di bloccare in
automatico porte e anelli centrali semplicemente chiudendoli, impedendo l’accesso ai prodotti chimici a persone non autorizzate. Un solo gesto è sufficiente: chiudendo la porta o abbassando il coperchio, il meccanismo si attiva all’istante, senza procedure complesse o interventi manuali aggiuntivi. Solo il personale autorizzato può accedere all’interno dei vani grazie alla chiave universale fornita, assicurando praticità e rapidità in ogni situazione.
L’eccellenza tecnologica di Alpha si sposa, infine, con una profonda responsabilità ecologica. I carrelli sono realizzati impiegando plastiche da riciclo certificate PSV (Plastica Seconda Vita). Filmop, inoltre, quantifica sistematicamente l’impronta climatica dei propri prodotti, sostenendo progetti internazionali volti alla compensazione della CO2. www.filmop.com
Adistanza di 7 anni due studi LCA sul medesimo ambito di servizio di pulizie professionali attestano i risultati raggiunti in termini di drastico abbattimento dell’impatto ambientale.
Ottenuto contestualmente alla conformità ISO 14067 per la rendicontazione della carbon footprint di prodotto, il recente rinnovo della certificazione EPD dei servizi di pulizia e sanificazione in ambienti ospedalieri costituisce l’occasione per attestare il percorso di trasformazione dei servizi di cleaning professionale di Coopservice in direzione della sempre maggiore sostenibilità, grazie ai risultati raggiunti in termini di drastica riduzione dei consumi idrici ed energetici, nonché di abbattimento delle emissioni di CO2 e della produzione di rifiuti
Si tratta di dati oggettivi e compiutamente verificabili in virtù del fatto che, nell’ambito di un intervallo temporale significativo, Coopservice è in condizione di mettere a confronto i risultati di due diversi studi sul Life Cycle Assessment (LCA) di uno specifico servizio all’interno della medesima struttura (Ospedale Fracastoro San Bonifacio, Verona): il primo risale al 2018, il secondo è del 2025. Essendo frutto di innovative modalità gestionali ormai consolidate, i livelli di ottimizzazione dell’impronta ecologica raggiunti sono interamente replicabili in qualsiasi contesto analogo in cui venga richiesta la progettazione di servizi di cleaning professionale a minimo impatto ambientale.
Con ciò, pertanto, Coopservice si trova oggi in una posizione particolarmente ‘caratterizzata’ nell’ambito panorama italiano dei servizi di pulizia, potendo presentare 7 anni di trasformazione ambientale attraverso dati misurati, verificati e comparabili. Perché la storia che emerge dalla comparazione degli indicatori riportati nei due studi di Life Cycle Assessment (LCA) condotti a distanza di quasi un decennio è quella di un servizio che cambia pelle, diventando progressivamente più efficiente, più leggero in termini di risorse consumate e sempre più vicino ai principi dell’economia circolare. Il confronto tra i due studi funziona come una lente sul tempo: mostra cosa accade quando innovazioni tecnologiche, scelte di acquisto responsabili e riorganizzazioni operative procedono per anni nella stessa direzione dandosi come obiettivi la riduzione dei consumi energetici ed idrici, il maggior ricorso a materiali riciclati e il significativo abbattimento dei rifiuti prodotti. Nello specifico, emerge una valutazione ‘prima-dopo’ degli effetti prodotti dall’introduzione progressiva di tecnologia a maggiore efficienza energetica ed idrica, di sistemi di dosaggio automatico, di attrezzature a basso consumo, di materiali riutilizzabili e di contenuti di materia riciclata, nonché di strategie operative finalizzate all’ottimizzazione delle risorse impiegate. Così, in riferimento alla medesima unità funzionale il confronto tra i due studi evidenzia, prima di tutto, una significativa riduzione dei fabbisogni energetici complessivi del servizio. In particolare, si constata una rilevante diminuzione del ricorso all’energia primaria non rinnovabile (-31%) e dell’energia totale consumata per l’erogazione delle attività: risultati direttamente riconducibili all’impiego di macchinari più efficienti, alla riduzione dei cicli di

lavaggio superflui, all’ottimizzazione delle modalità di ricarica delle attrezzature elettriche e all’organizzazione dei turni operativi.
Allo stesso modo, la razionalizzazione delle modalità di utilizzo dell’acqua - sistemi di pre-impregnazione delle microfibre, dosaggio controllato dei detergenti, utilizzo di attrezzature a basso consumo idrico - ha consentito di contenere in modo strutturale i consumi idrici del servizio, come rilevato attraverso sistemi di monitoraggio dedicati (contatori idrici e registrazione sistematica dei cicli di utilizzo), i cui effetti sono inclusi nei risultati ambientali complessivi misurati tramite l’analisi LCA.
Per quanto concerne poi la riduzione dei rifiuti e la minimizzazione dell’impatto ambientale del servizio, i medesimi studi documentano una riduzione significativa dei quantitativi di rifiuti destinati a smaltimento (–38% per i rifiuti non pericolosi e –85% per quelli pericolosi), accompagnata da un incremento marcato del recupero di materiali (+70%) e dell’impiego di materie prime secondarie (+500%). Sono dati che raccontano una trasformazione sia a monte – meno prodotti chimici critici, meno materiali usa e getta – che a valle, con flussi di raccolta differenziata più precisi e schemi di recupero che intercettano quantità crescenti di materiale. Tali risultati di attenuazione dell’incidenza dei rifiuti e di preservazione dell’ambiente sono da porre in relazione con l’adozione di prodotti con marchio Ecolabel, la riduzione degli imballaggi, l’introduzione di materiali riutilizzabili nonché con il ricorso a sistemi strutturati di raccolta differenziata e di monitoraggio dei flussi di rifiuti. Da considerare, a questo proposito, come successivamente alla prima certificazione EPD del 2018 abbia costituito una tappa di significativa progressione verso la sostenibilità dei servizi di cleaning la nascita della linea di prodotto ‘Green
Parametro Definizione
Parametri ambientali
GWP Global Warming Potential – Potenziale di riscaldamento globale (emissioni di gas serra)
ODP Ozone Depletion Potential – Potenziale di riduzione dello strato di ozono
ADPE Abiotic Depletion Potential – Elements –Consumo di risorse minerali
ADPF Abiotic Depletion Potential – Fossil – Consumo di risorse fossili
Energia e risorse
PERE Energia primaria rinnovabile utilizzata come materia prima
PERM Energia primaria rinnovabile utilizzata come combustibile
PERT Energia primaria rinnovabile totale
PENRE Energia primaria non rinnovabile utilizzata come combustibile
PENRM Energia primaria non rinnovabile utilizzata come materia prima
PENRT Energia primaria non rinnovabile totale
SM Materiali secondari (materie riciclate)
Rifiuti e recupero
HWD Rifiuti pericolosi destinati a smaltimento
NHWD Rifiuti non pericolosi destinati a smaltimento
RWD Rifiuti radioattivi destinati a smaltimento
MFR Materiali recuperati per riciclo
EEE Energia esportata (elettrica)
EET / ETE Energia esportata (termica)
Leaf by Coopservice’ la quale, nel 2020, ha ottenuto il marchio europeo di qualità ecologica Ecolabel.
Nel suo insieme, la comparazione degli indicatori riportati nei due diversi studi di Life Cycle Assessment tracciati nel tempo consente di rappresentare un’unica narrazione coerente: quella di una proposta di servizi di cleaning professionale che si è trasformata non solo nelle tecnologie e nei materiali, ma anche nel suo modo di essere progettata. Il ricorso alla metodologia LCA, in questo senso, oltre che uno strumento tecnico costituisce un dispositivo narrativo che permette di raccontare il cambiamento attraverso numeri che parlano da soli.
Ciò che emerge è un movimento costante verso la riduzione degli impatti e in direzione di una maggiore circolarità. Un percorso che Coopservice non solo documenta, ma rende replicabile, grazie a sistemi di monitoraggio che permettono di conoscere, controllare e migliorare ogni variabile ambientale del servizio, adattandola ai più disparati contesti di applicazione. È questo il vero lascito dell’analisi comparata dei due studi LCA: la disponibilità di un approccio e di una modalità gestionale che fa della sostenibilità non un’opzione, quanto una consolidata traiettoria di lungo periodo. www.coopservice.it
Unità di misura
Esito “old” Esito “new” Miglioramento
6,76E-06 9,88E-07 -85,38%
Unità Nome esteso (definizione tecnica)
kg CO2 eq.
kg CFC11-eq.
kg Sb-eq.
MJ
kg
Chilogrammi di anidride carbonica equivalente, espressi come potenziale di riscaldamento globale (GWP) su un orizzonte temporale di 100 anni
Chilogrammi di CFC11 equivalente, utilizzati come unità di riferimento per il potenziale di riduzione dello strato di ozono (ODP)
Chilogrammi di antimonio equivalente, unità di riferimento per il potenziale di esaurimento delle risorse abiotiche – elementi (ADPE)
Megajoule, unità di misura dell’energia primaria consumata
Chilogrammi di materiali o rifiuti generati
kWh Chilowattora di energia esportata o recuperata
TAXON SRL ha sviluppato, in collaborazione con PL Cleaning Innovation Srl, nuove linee di carrelli multifunzione pensate specificamente per le esigenze moderne: la linea UNIQO e UNIJ-K. Questi carrelli sono dei veri e propri eco-carrelli multifunzione e sono progettati e realizzati interamente dalla Taxon per rendere il lavoro di pulizia più semplice e veloce, offrendo strumenti flessibili, sicuri, rispettosi dell’ambiente e personalizzabili. Sono Made in Italy e certificati CAM. UNIQO, col suo sistema rivoluzionario per la sanificazione degli ambienti sanitari composto da carrello pulizie, frange e telaio è studiato per soddisfare la sempre più sentita esigenza di disinfezione e contenimento dei rischi da contaminazione incrociata negli ambienti ospedalieri e sanitari. Svolge il rivoluzionario processo di impregnazione a pressione delle speciali frange grazie allo speciale secchio Blu. Richiede un massimo di 20 secondi e può essere tarato sulla dimensione del locale, la tipologia dello sporco e della superficie da trattare.
I carrelli pulizia UNIQO sono programmabili con semplici comandi per impostare l’impregnazione delle frange in base a tre parametri. Sono dotati di un software gestionale che definisce le funzioni sulla base del cantiere e dei locali da sanificare. I suoi punti di forza sono molti, innanzitutto impregna le frange in pochi secondi ed elimina la fase strizzatura, semplificando e riducendo le attività, ottimizza i pesi da trasportare, elimina la fase di pre-impregnazione semplificando le operazioni degli operatori, c’è il massimo rispetto dell’ambiente e si riduce il rilascio di detergenti e il consumo di acqua. Il sistema di carrelli di pulizie professionali nasce con 2 serie di carrelli pulizia (serie 4 e serie 12) per un totale di 8 modelli, 2 frange e un telaio I carrelli per la pulizia della linea UNIJ-K rappresentano una soluzione completa e innovativa, combinando velocità di preparazione, semplicità d’uso, ampia scelta e personalizzazione, elevata maneggevolezza, grande praticità, solidità e un vantaggioso rapporto qualità/prezzo, il tutto con un forte orientamento alla sostenibilità ambientale e la garanzia del Made in Italy. In un’epoca in cui l’attenzione all’ambiente è sempre


più importante, i carrelli professionali della linea UNIJ-K si posiziona come una scelta ecologica. Sono verdissimi, realizzati in plastica riciclata in linea con le più rigide normative europee CAM (Criteri Ambientali Minimi). L’utilizzo di materiali riciclati non solo contribuisce alla riduzione dei rifiuti plastici, ma dimostra anche un impegno concreto verso pratiche sostenibili nel settore della pulizia. Scegliere un eco-carrello multifunzione UNIJ-K significa quindi optare

per una soluzione che coniuga efficienza operativa e rispetto per il pianeta. Che si tratti di un carrello pulizia per piccoli spazi o di carrelli pulizia per grandi strutture, sia la linea di carrelli UNIQO sia quella di UNIJ-K offrono opzioni per ogni esigenza. www.taxon.it






24. L’Ospedale Luigi Sacco si rinnova per una sanità più integrata e sicura [di Giovanna Serranò]
26. Qualità dei servizi ospedalieri: strategie e strumenti secondo Markas [di Giovanna Serranò]
28. RUP, il capro espiatorio perfetto [di Giovanni Coco]
32. Parità retributiva in dirittura d’arrivo: come adeguarsi? [di Simone Finotti]
34. Soft Facility Management, un nuovo standard per il monitoraggio [di Carlo Ortega]



38. Aggressioni in ospedale, servono approcci sistemici [di Giuseppe Fusto]
42. Dagli ospedali ai pronto soccorso: il presidio di sicurezza firmato Istituto di Vigilanza Coopservice [di Giovanna Serranò]
46. Rating di legalità: gli effetti del nuovo regolamento AGCM nel settore sanitario
[di Massimiliano Brugnoletti]
48. Dalle Alpi alla Sicilia, il procurement sanitario fa rete [dalla Redazione]
52. Exposanità 2026: sfide e opportunità della sanità digitale italiana [dalla Redazione]
54. Dermatite da Pyemotes, difficoltà diagnostiche e implicazioni nel pest management [di Lorenzo Donati]
58. TTR vs TNT, uno studio li mette a raffronto [di Umberto Marchi]
62. Quel rischio invisibile e (a volte) letale [di Simone Finotti]
66. Non solo automazione: il ruolo strategico della pulizia manuale in sanità [di Simone Finotti]
L’ospedale milanese avvia un profondo rinnovamento strutturale e organizzativo, puntando su integrazione con il territorio, formazione, telemedicina e percorsi condivisi. Centrale anche la sicurezza delle cure: rafforzato il controllo delle infezioni grazie a un approccio multidisciplinare, reti di professionisti e strategie basate sui dati. Ne parliamo con Maria Grazia Colombo, Direttrice Generale dell’ASST Fatebenefratelli Sacco di Milano.
di Giovanna Serranò

Maria Grazia Colombo è attualmente Direttrice Generale dell’ASST Fatebenefratelli Sacco di Milano, incarico che ricopre dal gennaio 2024 dopo aver svolto il ruolo di Commissario Straordinario nella stessa Azienda. In precedenza, è stata Direttore Amministrativo dell’ASST di Lecco dal 2019 al 2023, dove ha coordinato l’area amministrativa e gestionale, contribuendo al governo complessivo dell’Azienda e allo sviluppo dei processi organizzativi e di gestione delle risorse.
Ha maturato una lunga esperienza come Direttore Amministrativo in importanti realtà del sistema sanitario lombardo, tra cui l’ASST Santi Paolo e Carlo di Milano, l’Azienda Ospedaliera Ospedale di Circolo e Fondazione Macchi di Varese e l’Ospedale Luigi Sacco di Milano, dove ha ricoperto anche incarichi di direzione di strutture complesse e dipartimenti. Il suo percorso professionale in sanità ha inizio nei primi anni ’90 presso l’ASL Milano 1, sviluppandosi poi in modo continuativo fino a ricoprire ruoli apicali nella direzione strategica delle aziende sanitarie. Si è laureata in Scienze Politiche presso l’Università degli Studi di Milano e ha perfezionato la propria formazione manageriale in ambito sanitario, in

Maria Grazia Colombo
Direttrice Generale dell’ASST Fatebenefratelli Sacco di Milano
particolare presso SDA Bocconi e Polis Lombardia, con percorsi dedicati alla direzione e alla gestione delle aziende sanitarie. Ha collaborato con AGENAS per la aggiudicazione della procedura di gara per la Telemedicina a livello nazionale nell’ambito del finanziamento



PNRR. Svolge attività di docenza in ambito accademico e partecipa a iniziative scientifiche e formative, con contributi su temi legati all’organizzazione, alla gestione e agli acquisti in sanità.
Buongiorno dottoressa e grazie per l’intervista. Cominciamo con il rinnovamento organizzativo e strutturale dell’ospedale Sacco con i fondi del PPNR, ce ne parla?
“L’ospedale Luigi Sacco di Milano - Polo Universitario è uno storico nosocomio Milanese edificato nel 1931 quale centro dedicato al trattamento della Tubercolosi, ricopre un’area di 350.000mq e comprende un totale di 29 Corpi di Fabbrica (compreso il polo universitario). Con il finanziamento PNRR/PNC e con il contributo di Regione Lombardia per complessivi € 175 mil. l’Ospedale Luigi Sacco si rinnova per un ambiente di lavoro migliore per i dipendenti e per incrementare il comfort alberghiero per tutti i cittadini.
I Corpi di Fabbrica interessati da questo importante intervento di riqualificazione sono 13, il cui fine ultimo è avere a disposizione edifici più sicuri secondo gli indici di “umanizzazione”
previsti ossia la sicurezza strutturale, sicurezza antincendio ed antisismica, con il potenziamento degli impianti meccanici per garantire la produzione di aria climatizzata garantendo livelli ottimali di benessere, il risparmio energetico, con il miglioramento degli impianti elettrici secondo i nuovi standard antincendio, infine il rispetto dei criteri ambientali minimi (CAM). I lavori di riqualificazione sono attualmente in corso e procedono secondo le tempistiche dovute tanto che alcuni CF sono già stati consegnati agli operatori e ai cittadini e nei prossimi mesi si prevedono importanti inaugurazioni a testimonianza del fatto che l’Ospedale L. Sacco si rinnova per essere al fianco di ogni cittadino, per potenziare le strutture sanitarie e per garantire a tutti un ospedale sicuro e sostenibile”.
Che strategie avete adottato per rafforzare l’integrazione tra ospedale e territorio?
“La nostra strategia per rafforzare l’integrazione ospedale-territorio parte da un principio semplice: il territorio non è il luogo del “dopo”, ma un luogo essenziale di cura, capace di adattarsi al bisogno del paziente, dentro e fuori le Case di Comunità. Per questo lavoriamo su tre direttrici. La prima è la costruzione di canali stabili con la specialistica ospedaliera: gruppi di miglioramento, protocolli di intesa e percorsi condivisi per gestire in modo continuo le riacutizzazioni della cronicità, ma anche le nuove fragilità e la cronicità del paziente giovane. La seconda è il dialogo clinico-professionale: progetti innovativi come TEACH e il teleconsulto consentono ai professionisti del territorio e alla medicina generale di confrontarsi in tempo reale con gli specialisti, riducendo frammentazione e attese. La terza è la regia operativa: il protocollo delle dimissioni protette, fondato su Comune, polo ospedaliero e polo territoriale, e il ruolo delle Centrali Operative Territoriali assicurano continuità, appropriatezza e tracciabilità dei passaggi. In questo disegno, l’infermieristica di famiglia e comunità è parte attiva della presa in carico e della pianificazione. L’integrazione, per noi, non è una sommatoria di servizi: è un modello plastico, di prossimità, che porta la cura dove serve e ne misura gli esiti”.
Quali azioni avete implementato per ridurre le Infezioni Correlate all’Assistenza e come monitorate l’efficacia di questi interventi?
“Nella nostra Azienda crediamo fortemente che le Infezioni Correlate all’Assistenza (ICA) possono essere affrontate unicamente
attraverso uno sforzo multidisciplinare e multiprofessionale. Come l’abbiamo realizzato? Da un lato, abbiamo convogliato le migliori eccellenze dell’Ospedale Sacco, noto riferimento infettivologico, nel CIO Aziendale, in un contesto di pieno dialogo e condivisione di competenza tra infettivologi, microbiologi, infermieri, farmacisti, igienisti, e tante altre figure. Dall’altro, abbiamo costruito in tutta l’Azienda una rete capillare di professionisti interessati al tema delle ICA definiti “Link Professional”, che hanno diffuso la sensibilità sul tema in tutti i reparti.Inoltre, abbiamo implementato strategie data-driven tramite la raccolta puntuale dei dati sulle infezioni, l’analisi epidemiologica degli stessi e lo sviluppo di strategie su misura per l’epidemiologia locale di ogni reparto. Questo, unito all’introduzione di nuovi sistemi di segnalazione e sorveglianza e alla conduzione di audit nei reparti interessati da casi di ICA, ci ha permesso un miglioramento continuo delle strategie e una sempre maggior sicurezza delle cure per i nostri pazienti”.
La formazione del personale è una leva strategica importante per il contenimento e la riduzione delle ICA, come viene svolta all’interno della sua struttura?
“Ecco, leva strategica è la definizione giusta. Grazie alle risorse PNRR abbiamo implementato una campagna di formazione teorica di base che ha raggiunto quasi 3000 dei nostri dipendenti nel 2024, e una successiva formazione pratica più approfondita nel 2025 a più di 2000 operatori sanitari. Quest’ultima in particolare è stata una scommessa vinta. In una prima fase, la formazione è stata erogata da formatori aziendali esperti ai Link Professionals di cui ho parlato prima; successivamente, questi ultimi hanno trasferito le competenze ai colleghi dei rispettivi reparti attraverso strategie di apprendimento peer-to-peer. Parliamo di scommessa vinta perché i questionari raccolti a fine dell’evento formativo hanno manifestato un alto livello di soddisfazione.A fronte di questo successo, abbiamo deciso di sviluppare nel prossimo futuro una serie di ulteriori corsi per continuare a diffondere la cultura del contrasto alle ICA con iniziative di formazione sempre più mirate e specifiche, rivolte a temi emergenziali come sepsi e antibioticoresistenza. Non solo, abbiamo l’ambizione di supportare nella formazione anche i tanti altri Ospedali a cui già il Sacco fa consulenze infettivologiche, per fare sistema e vincere assieme questa importante sfida”.
Andrea Tezzele, Quality Health Safety & Environment Director
di Markas, racconta in questa intervista l‘approccio dell’azienda alla qualità dei servizi di pulizia e sanificazione sanitaria. Un modello che unisce formazione continua, digitalizzazione e dialogo con le strutture ospedaliere, affiancato da soluzioni innovative come dashboard intelligenti, sistemi di dosaggio automatizzato e cobotica.


Nelle aziende sanitarie la pulizia e la disinfezione sono elementi cruciali per la sicurezza di pazienti, operatori e visitatori. In ambienti ad alta complessità, come per esempio le sale operatorie o le terapie intensive, ogni dettaglio conta: la gestione dell’igiene diventa parte integrante del processo di cura. È proprio in questo contesto che realtà come Markas hanno sviluppato un know-how altamente specializzato: ne parliamo con Andrea Tezzele, Quality Health Safety & Environment Director di Markas, partendo proprio dal controllo della qualità dei servizi prestati.
Il codice degli appalti e il suo correttivo hanno ridefinito il ruolo, in particolare del RUP e del DEC; pertanto, i controlli da parte della committenza risultano più approfonditi e costanti. Come si applica concretamente il “plan-do-check-act” nel vostro siste-
ma di gestione della qualità nei molteplici servizi prestati?
“Come azienda leader di mercato nel settore HSQE, abbiamo sempre creduto in questo approccio e già dal 2013 abbiamo promosso l’importanza del RUP e del DEC. Col D.Lgs.n. 163/2006, il DPR del 2010, il D. Lgs 50/2016, il nuovo codice appalti e le recenti delibere ANAC, l’obbligo delle stazioni appaltanti di adottare sistemi di controllo del servizio con l’individuazione di correlati referenti, ha fatto sì che si coniugassero le esigenze della qualità nella sua accezione più ampia. Proprio in quanto “controllori” contrattuali, RUP e DEC sono invero garanti della qualità e rappresentano i nostri interlocutori principe nelle relative iniziative, dall’avvio appalto ai monitoraggi nel durante del rapporto contrattuale. Ciò instaura un processo “virtuoso” improntato al ciclo di Deming, ossia orientato alla misurabilità, tracciabilità e azioni conseguenti che generano una costante crescita qualitati-
va del servizio. In sintesi un “miglioramento continuo”. Una corretta gestione degli esiti dei controlli, applicata non solo alle pulizie, indirizza le risorse dove servono, con vantaggio per cliente e gestore e con prevenzione di contenziosi. D’altronde, specie nella sanità, è d’obbligo darsi standard elevati anche nelle attività che costellano il core business poiché al centro del nostro operato si pone il paziente


coi suoi bisogni e le sue specificità. In questo teniamo ad essere veri partner dei nostri clienti. Da ultimo e non certo per importanza, il sistema di controllo della qualità rappresenta una potente leva per qualificare il mercato nel suo complesso e, rispetto al quale, come assuntori del servizio, dobbiamo cercare di coglierne l’opportunità attuale e prospettica in continua evoluzione.
Come garantite la qualità del servizio di pulizia e disinfezione in ambito sanitario?
“La qualità “erogata” è frutto di un processo ampio e allo stesso tempo integrato di molti fattori che ne generano l’esito. Le attrezzature, i metodi, l’organizzazione, la stessa digitalizzazione e da ultimo, non certo per importanza, il fattore umano; questi sono gli aspetti fondanti. Nell’ambito dei servizi, e a maggior ragione in quello delle pulizie in ambito sanitario, il grado di preparazione delle operatrici e operatori nei reparti ha un
riflesso forse il più tangibile sul risultato finale del servizio. Malgrado l’ovvietà di questa affermazione, la sfida consiste proprio nel come restituire concretezza a tale azione, soprattutto in un contesto ove il solo turnover rappresenta una forte criticità alla garanzia di continuità sia essa qualitativa che quantitativa del lavoro svolto. Ecco che investire sulle persone con iniziative che restituiscano forza, rispetto, dignità e attenzione a questa fascia di risorse è assolutamente importante. Per garantire un servizio qualitativo all’altezza delle aspettative, le sole competenze “tecniche” non bastano. Esse devono essere integrate da iniziative di comunicazione bidirezionali che coniughino le esigenze qualitative dell’ospedale in un dialogo costante. Mi riferisco in particolare alla parte sanitaria dei nostri clienti ove spesso si individuano quei percorsi di miglioramento concreti che agevolano e instaurano anche quel giusto clima di fiducia. La tecnologia e le attrezzature di ultima generazione sono quindi il completamento ad un’azione organizzativa di ampia portata verso la qualità”.
Che tecnologie innovative utilizzate per migliorare ulteriormente la qualità degli ambienti sanitari?
“Il nostro approccio all’innovazione si articola su più livelli. Per quanto riguarda il servizio di pulizia e sanificazione, mettiamo a disposizione del cliente dashboard intelligenti che permettono di monitorare l’appalto in tempo reale, con KPI aggiornati e report immediati e certificabili. Questo approccio garantisce piena trasparenza, riduce gli errori e consente una gestione proattiva del servizio. Utilizziamo inoltre attrezzature smart come i sistemi di dosaggio automatico dei prodotti, che se da un lato permettono un maggior controllo sui consumi, dall’altra assicurano la correttezza dei dosaggi; aspetto questo quantomai “cruciale” e, giustamente attenzionato, nel mondo ospedaliero. Affianchiamo infine al personale sistemi di cobotica che si occupano delle attività più ripetitive, potenziando il lavoro delle persone e liberando tempo per attività a maggior valore aggiunto. Sul fronte della logistica ospedaliera, il nostro sistema SmartLogistics, basato sull’intelligenza artificiale, monitora in tempo reale lo stato di avanzamento del servizio. Il programma garantisce inoltre un trasporto intraospedaliero puntuale ed efficiente, assicurando agli operatori il percorso ottimale per il trasferimento dei pazienti in sicurezza tra i reparti”.
La cobotica è diventata un pilastro strategico per Markas: quali sono i principali vantaggi che offre in termini di qualità del servizio?
“Il vantaggio più immediato riguarda la costanza della qualità. I robot collaborativi garantiscono uniformità di esecuzione nelle attività ripetitive come il lavaggio dei pavimenti, eliminando le variazioni legate alla fatica o alla rotazione del personale. Il risultato è un livello di pulizia più stabile e prevedibile nel tempo. Altrettanto rilevante è la ridistribuzione del lavoro umano. Liberati dalle mansioni più routinarie, gli operatori possono concentrarsi sui controlli di qualità, sulle urgenze e sulle aree che richiedono maggiore attenzione. Questo si accompagna a un percorso di crescita professionale che, dal 2026, includerà anche una Masterclass Robotica all’interno della nostra “Cleaning Masterclass”. I cobot offrono inoltre tracciabilità e trasparenza. I dati raccolti durante le operazioni sono accessibili al cliente e integrabili con le informazioni ambientali provenienti dai sensori IoT, offrendo una visione completa e certificabile del servizio erogato”.
Lei prima ha accennato alla formazione come leva importante quale strumento utilizzato per il raggiungimento degli obiettivi qualitativi: come viene realizzata in Markas?
“In Markas la formazione è un requisito fondamentale e, per ciascuno dei nostri collaboratori, sono previsti dei programmi dedicati. Operare in ambienti sanitari richiede infatti competenze specifiche e aggiornate come la conoscenza dei materiali e delle superfici o l’utilizzo consapevole dei prodotti chimici. Il percorso formativo si sviluppa su più livelli: dalle formazioni obbligatorie in materia di salute e sicurezza sul lavoro, alle formazioni sulle specifiche metodologie operative, fino all’aggiornamento continuo “on the job” attraverso l’affiancamento di tutor esperti. Ogni fase è modulata in base al grado di rischio del reparto in cui viene svolto il servizio, per garantire che gli operatori siano sempre consapevoli e aggiornati sui metodi e sulle tecniche di pulizia più all’avanguardia. Da ultimo e non meno importante, la verifica di efficacia della formazione. Affianchiamo alla tradizionale compilazione di test una verifica diretta durante l’esecuzione dei processi in reparto. Questa modalità integrata di verifica consente realmente di attestare l’efficacia della formazione “ad personam”, intervenendo in modo mirato là dove richiesto”.

Nel nuovo Codice dei contratti il Responsabile Unico del Progetto diventa il perno delle decisioni pubbliche, ma in assenza di adeguate garanzie il confine tra scelta discrezionale e rischio penale e amministrativo resta drammaticamente incerto.
di Giovanni Coco
direttore UOC Provveditorato ARNAS Civico Palermo
Tratto da TEME 1-2/2026
Nel Servizio Sanitario Nazionale la firma del RUP vale sempre più di un atto amministrativo: è diventata un atto di coraggio. Il Responsabile Unico del Progetto – oggi figura cardine dell’attività negoziale delle amministrazioni, ridefinita dall’art. 15 del d.lgs. 36/2023 – si muove ogni giorno in uno spazio stretto, schiacciato tra l’imperativo politico-gestionale di “fare presto e bene” e lo spettro di un avviso di garanzia per reati contro la pubblica amministrazione. L’ospedale che deve aggiudicare in tempi rapidi una gara per farmaci salvavita, l’azienda sanitaria che corre per non perdere i fondi PNRR, il dirigente che firma una perizia in variante: in tutti questi casi il RUP è il volto visibile di una macchina complessa, ma an-
che il primo bersaglio mediatico e giudiziario quando qualcosa non funziona o semplicemente viene contestato.
La genesi del RUP
Per capire come si è arrivati a questa tensione occorre tornare alla genesi della figura. Con la legge 241/1990 nasce il responsabile del procedimento, una figura essenzialmente procedurale, incaricata di garantire che l’iter amministrativo si svolga nei tempi e nei modi stabiliti dalla legge.
Nel settore dei contratti pubblici il salto avviene con la legge Merloni del 1994 e poi con i codici del 2006 e del 2016, che consolidano il RUP come regista della procedura di gara. Ma è il d.lgs. 36/2023 a cambiare davvero
la prospettiva: il RUP diventa Responsabile
Unico del Progetto, titolare della responsabilità sull’intero ciclo di vita dell’intervento, dalla programmazione alla esecuzione.
Il principio del risultato nel nuovo codice
Questo mutamento lessicale non è solo formale. Il nuovo codice, costruito attorno al principio del risultato, riconosce al RUP una discrezionalità sostanziale: non è più un mero garante della correttezza formale dell’iter, ma un gestore di obiettivi – tempi, costi, qualità – chiamato a scegliere i mezzi più idonei per conseguirli, modulando criteri di aggiudicazione, valutazioni di congruità, gestione dell’esecuzione contrattuale. L’art. 1 del d.lgs. 36/2023 consacra il principio del risultato come stella polare del nuovo Co-

Il risultato è un paradosso: al RUP si chiede di osare per raggiungere il risultato, ma si trasmette il messaggio che ogni deviazione dallo standard più prudente potrebbe diventare il punto di partenza di un fascicolo penale.
Dall’abolizione dell’abuso d’ufficio al nuovo art. 314-bis
Per anni il simbolo di questa tensione è stato l’art. 323 c.p., il reato di abuso d’ufficio. Nella sua formulazione originaria, la norma ha funzionato come una “clausola generale penale” capace di inglobare una vasta gamma di comportamenti amministrativi discutibili, spesso più vicini a vizi di legittimità che a condotte realmente criminose. Le riforme del 1990, 1997, 2012 e il ridimensionamento del 2020 hanno tentato di precisare e re-

dice dei contratti: conta l’efficacia dell’azione amministrativa, non il feticcio del formalismo procedurale. In teoria, un cambio di paradigma capace di liberare il RUP dalla “paura della firma” e di responsabilizzarlo sugli esiti concreti delle decisioni. In pratica, però, questo ampliamento dei margini decisionali si innesta in un ordinamento penale che continua a guardare con sospetto alla discrezionalità amministrativa. Ogni scelta valutativa del RUP – dalla ponderazione dei requisiti di partecipazione alla modulazione dei punteggi qualitativi, fino alla gestione di sospensioni e varianti in corso d’esecuzione – può essere riletta ex post come favoritismo, sviamento, o addirittura come sintomo di una dinamica corruttiva.

stringere il campo di applicazione, ancorando l’abuso a violazioni specifiche e a danni o vantaggi di rilevante gravità. Ma il sospetto di indeterminatezza non è mai stato davvero superato, soprattutto nella prassi investigativa, dove l’abuso ha continuato a essere utilizzato come grimaldello per entrare nelle scelte discrezionali.
L’abrogazione integrale dell’art. 323 c.p. con la legge 114/2024 è stata salutata da molti come una “liberazione” per amministratori e funzionari. In realtà, come segnala la dottrina, il vero effetto è stato più complesso: da un lato l’abolitio criminis ha chiuso migliaia di procedimenti; dall’altro il legislatore ha introdotto l’art. 314-bis c.p., che punisce l’esercizio di poteri “chiaramente esorbitanti” dalle attribuzioni.
Questa nuova figura, nata per colmare il presunto vuoto, rischia di riprodurre – sotto altra etichetta – le ambiguità dell’abuso d’ufficio. Che cosa significa, infatti, “chiaramente esorbitante”? Dove finisce l’errore di valutazione, fisiologico in ogni attività discrezionale, e dove inizia la deviazione penalmente rilevante? Le risposte sono affidate, di fatto, all’interpretazione giurisprudenziale, con il rischio di spostare il baricentro del controllo dalle aule dei TAR alle procure della Repubblica. Sul piano sistemico, il quadro è quello che una parte della dottrina ha definito “paradosso di Trocadero”: una proliferazione di norme penali, spesso simboliche, che non si traduce in maggiore chiarezza né in vera deterrenza, ma alimenta incertezza e paralisi. Mentre viene cancellato l’abuso d’ufficio, altre fattispecie – dalla corruzione propria ai delitti di peculato e concussione – conoscono un progressivo inasprimento sanzionatorio. La logica è chiara: mostrare severità esemplare verso i reati contro la PA, rassicurare l’opinione pubblica sulla lotta alla corruzione, rispondere alle sollecitazioni europee.
Incertezza normativa e timore di responsabilità
Ma, come ricordano gli studi di criminologia, non è la severità astratta della pena a incidere sui comportamenti, bensì la sua certezza. In un contesto normativo ipertrofico, dove i confini tra illecito disciplinare, violazione amministrativa e reato non sono sempre nitidi, il messaggio che arriva al funzionario è un altro: meglio non decidere, meglio non firmare. Per il RUP del SSN – chiamato a bandire gare complesse, talvolta urgenti, in un mercato iper-regolato e sotto i riflettori della Corte dei conti, dell’ANAC, delle procure e dei media – questo paradosso si traduce in una forma di “burocrazia difensiva” permanente. Su questo sfondo normativo si innesta la crisi del garantismo processuale. Se sulla carta la presunzione di innocenza è un principio intangibile, nella prassi dei reati contro la PA è spesso rovesciata: l’iscrizione nel registro degli indagati viene letta come una quasi-condanna, l’applicazione di misure cautelari anticipate a simbolo di colpevolezza, le intercettazioni selezionate diventano titoli di apertura dei talk show.
Il peso delle inchieste penali nel settore sanitario
L’arresto di un direttore generale, l’indagine su un RUP per una gara di dispositivi medici, la perquisizione in un ufficio acquisti: ogni episodio alimenta la percezione di una “sanità marcia”, a prescindere dall’esito finale dei processi. La Corte costituzionale, con la sentenza
n. 132/2024, ha colto con chiarezza il rischio sistemico: l’esposizione costante dei dipendenti pubblici a procedimenti penali, anche quando si concludono senza condanna, produce una delegittimazione di status che danneggia l’intera amministrazione e scoraggia le professionalità migliori dall’assumere ruoli di responsabilità. Per il RUP del SSN, questo significa vivere in un equilibrio precario tra dovere di decidere e istinto di autotutela.
Lo scudo erariale
In questo contesto prende forma lo “scudo erariale”, nato con il decreto semplificazioni del 2020 e più volte prorogato, che limita – per un periodo determinato – la responsabilità per danno erariale ai soli casi di dolo, almeno per gli atti commissivi connessi alla gestione di fondi e procedure strategiche.
L’obiettivo dichiarato è proprio quello di contrastare la paralisi decisionale e la paura della firma, riconoscendo che l’errore di valutazione, anche grave, in un quadro normativo complesso non può automaticamente tradursi in responsabilità contabile. La giurisprudenza e la dottrina hanno sottolineato, peraltro, la legittimazione costituzionale di questa scelta, richiamando il principio di buon andamento (art. 97 Cost.) e la necessità di proteggere l’e-
sercizio della discrezionalità amministrativa. Tuttavia, si tratta di uno strumento parziale e temporaneo. Non tocca direttamente il versante penale, non incide sul processo mediatico, non risolve l’ambiguità di fondo: che cosa è davvero rimproverabile, e su quale piano? Disciplinare, amministrativo, contabile, penale? Per il RUP, la sensazione è spesso quella di muoversi con un ombrello aperto solo a metà, sotto un temporale normativo che continua a intensificarsi.
La confusione, spesso implicita, tra etica amministrativa e rilevanza penale
Non ogni scelta discutibile, non ogni carenza di motivazione, non ogni preferenza sbagliata per un criterio di gara costituisce un reato; eppure, la tendenza dell’ultimo trentennio è stata quella di usare il diritto penale come strumento di controllo generalizzato dell’azione amministrativa.
Nel SSN, dove il RUP deve bilanciare interessi eterogenei – qualità delle prestazioni, sostenibilità economica, urgenza delle forniture, equità di accesso – l’idea di ridurre tutto a una logica binaria “lecito/illecito penale” è fuorviante. Esiste uno spazio fisiologico di conflitto, di errore, di scelte opinabili che dovrebbe essere presidiato dal diritto amministrativo, dal giudice contabile, dai procedimenti disciplinari, non dal codice penale.

lose, da punire con rigore sul piano penale;
• errori, negligenze, scelte opinabili, da ricondurre nell’alveo della responsabilità amministrativa, contabile o disciplinare;
• scelte discrezionali legittime, che non possono essere giudicate ex post alla luce di esiti indesiderati o di pressioni mediatiche.
Le proposte che emergono nella dottrina e nella giurisprudenza vanno in direzione di:
• definire con maggiore precisione le fattispecie penali contro la PA, evitando clausole generali che assorbono il contendibile amministrativo;
• ricondurre la colpa grave in responsabilità amministrativa a criteri tipizzati, superando formule elastiche che espongono a valutazioni imprevedibili;
• rafforzare e stabilizzare strumenti come lo scudo erariale, legandoli a meccanismi di regressione nei confronti del dipendente solo in presenza di dolo o colpa davvero macroscopica;
• disciplinare in modo più rigoroso la comunicazione istituzionale su indagini e procedimenti, per ridurre gli effetti distorsivi del processo mediatico.
Quando, invece, ogni scostamento dalla regola più prudente viene anticipato come potenziale ipotesi di corruzione o peculato, la razionalità organizzativa spinge verso l’inerzia: il massimo della tutela personale coincide con il minimo della capacità decisionale dell’ente. Da qui l’esigenza – ormai non più eludibile –di una revisione strutturale del sistema delle tutele per funzionari e dirigenti pubblici, ed in particolare per i RUP del SSN. Il nodo non è “proteggere i corrotti”, ma distinguere in modo chiaro tra:
• violazioni gravi e do-
Alla fine, la questione è anche culturale. Finché il dipendente pubblico verrà percepito come potenziale colpevole in attesa di processo, anziché come presidio dell’interesse generale, nessuna riforma normativa potrà davvero restituire serenità alla discrezionalità amministrativa. Nel SSN, la figura del RUP incarna perfettamente questa contraddizione: si pretende da lui capacità manageriale, rapidità decisionale, innovazione negli affidamenti e nella gestione dei progetti; allo stesso tempo lo si lascia esposto a un sistema di controllo penale e mediatico che trasforma ogni decisione in un rischio personale elevatissimo. Ripensare il sistema delle tutele significa riconoscere che senza spazi reali di autonomia – garantiti sul piano penale, contabile e reputazionale – il principio del risultato resta uno slogan vuoto. Continuerà a non esserci vera efficienza nella spesa pubblica, né nel SSN né altrove, se il messaggio che colgono i RUP continuerà a essere: “decidere è pericoloso, meglio non decidere”.

Sta per concludersi il cammino verso il recepimento della Direttiva
UE 2023/970: il termine è il prossimo 7 giugno. Una conquista di civiltà ma anche una sfida non semplice da affrontare. Ecco impatti, obblighi e sanzioni per chi non rivede il proprio sistema di gestione del personale. Anche in sanità.
di Simone Finotti

retributiva e contrasto al divario di genere entrano in una fase decisiva. Il 7 giugno 2026 segna infatti il termine entro cui gli Stati membri dovranno recepire la Direttiva (UE) 2023/970, provvedimento che rafforza in modo strutturale il principio della parità di retribuzione per una stessa occupazione o per un lavoro di eguale livello tra donne e uomini.
Non un intervento simbolico, ma un provvedimento concreto Attenzione: non si tratta solo di un intervento simbolico, perché la direttiva introduce obblighi operativi stringenti, nuovi diritti informativi per i lavoratori e un regime sanzionatorio incisivo che impatterà in modo significativo sull’intera organizzazione aziendale nel suo complesso, anche nel settore sanitario. La portata delle nuove norme, fra l’altro, va ben oltre il tradizionale confronto uomo-donna: la trasparenza retributiva, intesa in un’ottica più ampia, diventa un principio generale che impone chiarezza nei criteri di determinazione dei salari per tutti i dipendenti che svolgono mansioni equivalenti, riducendo le
aree di discrezionalità e opacità che in passato hanno favorito squilibri a volte difficili da individuare.
Qualche dato sul gender pay gap (presente anche nel settore sanitario)
Questo rafforzamento normativo nasce da un dato strutturale che continua a caratterizzare il mercato del lavoro europeo. Secondo le più recenti rilevazioni di Eurostat, il divario retributivo medio non corretto tra uomini e donne nell’Unione Europea si attesta intorno al 12-13%, con differenze significative tra Stati membri e settori produttivi. Un gender pay gap che tende ad ampliarsi nei comparti a maggiore segregazione occupazionale e nelle posizioni apicali, e che non lascia indenne nemmeno il comparto sanitario, specie nel privato, nelle premialità e laddove la contrattazione collettiva lascia maggiori margini di discrezionalità.
Cosa accade in Italia?
E nello specifico del nostro Paese? Ebbene, in Italia il divario medio risulta inferiore alla
media UE, ma il dato è influenzato da una minore partecipazione femminile al mercato del lavoro e da una forte incidenza del cosiddetto “part-time involontario”, che deriva dalle occupazioni non a tempo pieno non per scelta del lavoratore, costretto di fatto ad accettare una riduzione oraria per mancanza di alternative “full time”. Come accennavamo, le differenze retributive emergono inoltre in modo più evidente nelle progressioni di carriera, nei premi di risultato e nelle indennità accessorie, guarda caso gli ambiti in cui i margini di discrezionalità sono maggiori. La direttiva interviene anche su questi aspetti strutturali, puntando a rendere verificabili e comparabili i criteri di inquadramento e remunerazione.
I diritti dei lavoratori e l’accesso alla tutela giudiziaria
Andando con ordine, uno dei pilastri della nuova disciplina riguarda il rafforzamento degli strumenti di tutela individuale. In questo senso interviene il disposto dell’articolo 14, laddove stabilisce che i lavoratori che ritengano violato il principio di parità retri-
butiva debbano poter accedere a procedure giudiziarie efficaci e facilmente accessibili, anche dopo la cessazione del rapporto di lavoro.
Si allevia l’onere probatorio
Ciò comporta un ampliamento delle possibilità di ricorso e un alleggerimento dell’onere probatorio a carico del lavoratore, che potrà avvalersi delle informazioni retributive rese disponibili grazie agli obblighi di trasparenza. La direttiva riconosce inoltre un ruolo attivo a rappresentanti dei lavoratori, organismi per la parità e associazioni, che potranno promuovere azioni legali in nome o a sostegno delle presunte vittime di discriminazione salariale. Questo meccanismo rafforza la dimensione collettiva della tutela e aumenta l’esposizione delle imprese a contenziosi strutturati.
Trasparenza salariale: cosa cambia per le imprese
Per le aziende si apre dunque una fase di profonda revisione delle politiche retributive e dei sistemi di gestione del personale: innanzitutto le differenze salariali dovranno essere giustificate sulla base di criteri oggettivi, neutri rispetto al genere e verificabili, superando prassi informali o trattamenti discrezionali difficilmente documentabili. Ma non è tutto, visto che la trasparenza interviene già nella fase di selezione: i candidati avranno diritto a conoscere la fascia retributiva prevista per la posizione offerta e non potranno essere interrogati sulla storia salariale pregressa, misura pensata per evitare il trascinamento “per inerzia” di disuguaglianze maturate in precedenti esperienze lavorative.
Trasparenza in fase di selezione e gestione delle carriere
Anche la gestione delle carriere dovrà rispondere a criteri chiari e pubblici. I parametri per promozioni, progressioni economiche e riconoscimento dei premi dovranno essere formalizzati e comunicabili, il che riduce il rischio di trattamenti differenziati immotivati o non giustificabili. Un cambiamento culturale rilevante riguarda inoltre il superamento delle clausole di riservatezza sulle retribuzioni: i dipendenti potranno discutere liberamente del proprio stipendio e richiedere informazioni sui livelli retributivi medi distinti per genere e categoria professionale. Non è poco, se si considera che stiamo parlando di quello che, almeno dalle nostre parti, è sempre stato considerato alla stregua di un vero e proprio tabù.
Obblighi di reportistica e meccanismi correttivi
La direttiva introduce anche obblighi periodici di rendicontazione per le imprese di maggiori dimensioni: queste ultime dovranno raccogliere e trasmettere dati sul divario retributivo di genere, includendo informazioni su salari base, componenti variabili e benefici accessori. In presenza di scostamenti significativi non giustificati, sarà necessario attivare valutazioni congiunte con i rappresentanti dei lavoratori e predisporre piani di correzione. Non si tratta di un mero adempimento formale: la reportistica diventa uno strumento di monitoraggio continuo che impone alle organizzazioni di conoscere in profondità la propria struttura retributiva e di intervenire tempestivamente in caso di criticità.
Impatti sui settori ad alta intensità di manodopera
E andiamo al dunque: le implicazioni risultano particolarmente rilevanti per i comparti labour intensive, e in quelli - come quello sanitario - in cui si registra un’elevata presenza femminile, fattore che espone maggiormente le aziende e i datori di lavoro al rischio di rilievi sul divario retributivo. Per questo si tratta di un tema da monitorare con grande attenzione e senza superficialità.
Necessari interventi coordinati, occhio alle superficialità
A ciò si aggiunge la complessità organizzativa aziendale, che rende più onerosa la mappatura dei ruoli e la valutazione oggettiva delle mansioni. Sistemi premianti non strutturati, indennità o trattamenti differenziati tra appalti possono generare disallineamenti difficili da giustificare secondo i nuovi criteri europei. Adeguarsi richiede un intervento coordinato che coinvolga perlomeno direzione aziendale, risorse umane, area legale. Diventa essenziale classificare correttamente le posizioni, adottare metodologie oggettive di valutazione del lavoro e costruire politiche retributive coerenti e documentabili.
Un cambio di paradigma nella gestione del personale
La nuova disciplina impone un salto di qualità culturale prima ancora che organizzativo. Non basta adeguarsi formalmente: occorre adottare una gestione del personale improntata a equità, tracciabilità delle decisioni e coerenza tra ruoli, responsabilità e compensi. La trasparenza diventa un elemento reputazionale.
Il regime sanzionatorio e il monitoraggio della Commissione L’efficacia della direttiva è rafforzata da un apparato sanzionatorio che non lascia spazio a “distrazioni”. L’articolo 23 impone infatti agli Stati membri di introdurre sanzioni efficaci, proporzionate e dissuasive, che includano sanzioni pecuniarie e misure accessorie. La Commissione eserciterà un monitoraggio costante sull’adeguamento delle normative nazionali e sull’effettiva applicazione delle misure. Particolare attenzione è riservata alla reiterazione delle violazioni: i soggetti che persistano nel mancato rispetto della parità retributiva o degli obblighi di trasparenza potranno essere soggetti a provvedimenti sempre più severi.
Prepararsi per tempo per evitare criticità
Il conto alla rovescia verso il 7 giugno 2026 sta arrivando alla fine, e il percorso di adeguamento richiede tempi tecnici non brevi. Le aziende sono chiamate ad analizzare la propria struttura organizzativa, verificare l’equità dei sistemi retributivi, aggiornare regolamenti interni e rafforzare i sistemi di raccolta e analisi dei dati. Anticipare i tempi significa ridurre il rischio di contenziosi e sanzioni e trasformare un obbligo normativo in un’opportunità di miglioramento. La piena trasparenza retributiva segna un’importante conquista di civiltà ma, al contempo, rappresenta una sfida complessa: ignorarla significherebbe esporsi a rischi economici, legali e reputazionali che, inutile ribadirlo, occorre assolutamente evitare. Foss’anche per un “semplice” fatto etico e deontologico.

Finalmente una Prassi di Riferimento per i servizi di Soft Facility Management: la PdR 188, promossa da Fondazione Scuola Nazionale Servizi in collaborazione con UNI, definisce un modello strutturato, trasparente e condiviso per il monitoraggio in fase di esecuzione dei contratti. Obiettivo: garantire la qualità dei servizi.
di Carlo Ortega
Nelpanorama dei servizi pubblici, il Soft Facility Management - vale a dire quell’insieme di servizi di supporto alla gestione di un edificio o di un’organizzazione che riguardano il benessere, la sicurezza e il comfort delle persone che vi operano, a partire dai servizi di pulizia e manutenzione - ha assunto negli anni un ruolo sempre più strategico per il funzionamento delle organizzazioni complesse.
Una crescente centralità
Attività come pulizia e sanificazione, ristorazione collettiva, logistica interna, lavanolo, gestione dei rifiuti, portierato e vigilanza non armata incidono direttamente sulla sicurezza degli ambienti, sulla tutela della salute, sul benessere delle persone e sulla continuità operativa dei servizi essenziali. E qui iniziano i problemi, perché a questa crescente centralità non è sempre corrisposta un’evoluzione altrettanto strutturata degli strumenti di governo della fase esecutiva dei contratti. In molti contesti, anzi, i controlli continuano
a essere percepiti come attività episodiche o meramente formali, talvolta attivate solo in presenza di criticità o di situazioni straordinarie. Quello dei controlli in fase di esecuzione, d’altra parte, rappresenta un annoso problema che da sempre viene evidenziato in numerose sedi.
Finalmente uno strumento di monitoraggio
Ne deriva, nell’ordinario, un sistema frammentato, caratterizzato da prassi disomogenee e da livelli di qualità che possono variare sensibilmente tra territori, stazioni appaltanti e singoli contratti. Il che in un contesto come quello sanitario non è certo auspicabile. È precisamente in questo scenario che si inserisce la UNI/PdR 188:2026, neonata Prassi di Riferimento promossa dalla Fondazione Scuola Nazionale Servizi in collaborazione con UNI, con l’obiettivo di definire un modello strutturato, trasparente e condiviso per il monitoraggio e la verifica dei contratti di Soft Facility Management durante la loro esecuzione.

Una prassi che nasce dall’esperienza
Entriamo subito nel vivo: uno degli elementi distintivi della Prassi di Riferimento 188 è la sua origine fortemente operativa. Non si tratta di un documento concepito per introdurre nuovi adempimenti o per irrigidire il quadro regolatorio, bensì di uno strumento costruito a partire dalle esigenze concrete di chi gestisce quotidianamente servizi complessi, sia dal lato della committenza pubblica sia da quello delle imprese.
Il Tavolo di lavoro
Per perseguire questo obiettivo, il Tavolo di lavoro coordinato da UNI ha coinvolto competenze multidisciplinari provenienti da amministrazioni pubbliche, aziende sanitarie, università, imprese di servizi, produttori e consulenti legali e tecnici. Il coordinamento scientifico è stato affidato a Maurizio Vetrò (FMSpecialist Srl), affiancato da Maria Luigia Barone (ASST Ovest Milanese e vice presidente FARE), Umberto Cout (USL Valle d’Aosta - FARE), Angelo Baggiani (Università di Pisa), Massi-

miliano Brugnoletti e Paolo Cavallo (Studio Brugnoletti & Associati), Lorenzo Di Vita e Salvatore Inglese (AFIDAMP), Rosa Draisci (esperta del settore chimico e consulente ISS), Luigi Fratini (Ecochem), Francesco Venneri (Regione Toscana), Claudio Campion (FMSpecialist), oltre ai rappresentanti della Fondazione Scuola Nazionale Servizi Cesare Grassi e Vittorio Serafini.
Mettere a sistema prassi esistenti Dal confronto fra i vari attori del Tavolo di lavoro dedicato è emersa una consapevolezza condivisa: i controlli nei servizi pubblici non sono assenti, ma spesso mancano di uniformità metodologica. Le verifiche sono già previste dai contratti, dal quadro normativo vigente e dalle responsabilità attribuite ai soggetti della stazione appaltante; ciò che risulta carente è un sistema che renda tali controlli coerenti, misurabili e realmente funzionali al governo del servizio. Era dunque improcrastinabile sistematizzare e rendere omogenee pratiche esistenti, non per aggiungere livelli di complessità.
La centralità dell’esecuzione (e del risultato)
D’altra parte, l’evoluzione del contesto normativo ha rafforzato l’importanza della fase di esecuzione dei contratti pubblici. Il dlgs 36/23, nuovo Codice dei contratti, ha posto al centro il principio del risultato e la responsabilità della stazione appaltante nel garantire che le prestazioni contrattuali producano benefici concreti per la collettività. Il cambio di prospettiva è evidente: l’aggiudicazione non rappresenta più il momento conclusivo del processo, ma l’inizio di una fase gestionale che richiede controllo costante, tracciabilità delle decisioni e capacità di intervento tempestivo.
Il ruolo di ANAC
In parallelo, l’azione dell’Autorità Nazionale Anticorruzione ha posto crescente attenzione sulla qualità dei controlli in fase esecutiva. Le più recenti deliberazioni sottolineano la necessità di verifiche effettive e documentabili, coerenza tra atti di gara ed esecuzione e responsabilizzazione delle figure tecniche coinvolte nella gestione dei contratti. In que-

sto contesto, la Prassi si configura come uno strumento operativo che aiuta le amministrazioni a dimostrare, in modo strutturato e difendibile, di aver esercitato correttamente il proprio ruolo di governo del contratto, riducendo il rischio di contenziosi e rilievi. I sette “principi capitali”
Alla base vi è un impianto culturale fondato su principi che orientano l’intero sistema dei controlli. Il modello promuove in effetti un superamento della visione meramente formale delle verifiche e introduce una logica orientata ai risultati, alla qualità effettiva delle prestazioni e alla tutela degli utenti finali, basandosi su sette “principi cardinali”: innanzitutto la centralità del risultato (è importante verificare l’esito effettivo, non solo gli adempimenti formali); l’oggettività e misurabilità, grazie a criteri predefiniti, condivisi e quantificabili; la trasparenza e responsabilità (i processi devono essere tracciabili e documentabili).
Coerenza normativa e flessibilità Ancora, è importante la coerenza normativa - integrazione con il quadro ordinamentale esistente -, così come (e non poteva essere altrimenti) la sostenibilità, con un uso efficiente delle risorse e riduzione degli impatti, la flessibilità (“esportabilità”, vale a dire adattabilità a contesti e servizi diversi) e la valorizzazione del facility management. In particolare, vengono valorizzate l’oggettività delle verifiche, che devono basarsi su criteri misurabili e replicabili, e la collaborazione tra committenza e impresa, intesa come condizione essenziale per prevenire conflitti e favorire il miglioramento continuo. Questa impostazione segna un cambio di paradigma: il controllo non è più concepito come atto ispettivo o sanzionatorio, ma come leva di governo e strumento di garanzia della qualità complessiva del servizio.
Ruoli e responsabilità per una governance chiara
Un ulteriore elemento qualificante della PdR riguarda la definizione puntuale dei soggetti coinvolti e delle relative responsabilità. Il modello chiarisce il ruolo della stazione appaltante (PA), delle figure tecniche incaricate della gestione del contratto e dell’operatore economi -
La metodologia in quattro fasi
co, promuovendo una chiara attribuzione dei compiti lungo l’intero ciclo di vita del servizio. In particolare, si fa riferimento al RUP, Responsabile unico di progetto, che coordina le attività, approva il Manuale delle verifiche e nomina il DEC; quest’ultimo - Direttore dell’esecuzione del contratto - verifica l’esecuzione, coordina le ispezioni, redige i verbali; ci sono poi i Referenti tecnici locali, incaricati delle verifiche quotidiane, della segnalazione di anomalie e della checklist. Lato impresa appaltatrice troviamo il Contract manager, che fa da referente ufficiale, e il Supervisore operativo.
Distinguere le figure per evitare sovrapposizioni operative
La distinzione delle responsabilità evita sovrapposizioni operative e riduce le aree di ambiguità decisionale, favorendo una gestione più efficiente e trasparente dei controlli. L’individuazione dei livelli decisionali e delle funzioni operative contribuisce inoltre a rendere il sistema verificabile anche da soggetti esterni, rafforzando la legittimità dell’azione amministrativa.

Il Manuale delle attività di monitoraggio
Il cuore metodologico della PdR 188 è rappresentato dal Manuale delle attività di monitoraggio e verifica, documento operativo che traduce i principi generali in procedure applicative concrete. Il Manuale non costituisce un allegato formale, ma uno strumento condiviso tra committenza e impresa, preferibilmente elaborato all’avvio del contratto. La sua funzione è duplice: da un lato chiarire come la stazione appaltante eserciterà le proprie funzioni di controllo; dall’altro, definire le modalità attraverso cui l’impresa potrà dimostrare la qualità delle prestazioni erogate. Il Manuale mette in relazione capitolato, offerta tecnica e sistemi di autocontrollo, armonizzandoli in un quadro unitario.
Uno strumento dinamico
Particolare rilievo assumono la mappatura dei servizi, l’analisi dei rischi, la pianificazione dei controlli e la definizione di indicatori misurabili. La raccolta delle evidenze - attraverso checklist, dati strumentali, registrazioni e documentazione fotografica - consente di rendere le verifiche oggettive e tracciabili. La gestione delle non conformità è orientata alla risoluzione tempestiva delle criticità e al miglioramento progressivo delle prestazioni, evitando automatismi sanzionatori non proporzionati. Il Manuale si configura così come uno strumento dinamico, aggiornabile nel tempo, capace di accompagnare l’intero ciclo del contratto e favorire un dialogo costante tra le parti.
Un ciclo strutturato di pianificazione e miglioramento
Per il controllo, la PdR introduce una metodologia organica che razionalizza l’attività attraverso un processo ciclico articolato in fasi integrate. Il modello di approccio strutturato segue il noto ciclo PDCA (PlanDo-Check-Act). La pianificazione iniziale consente di individuare priorità e aree di rischio, evitando dispersioni di risorse in verifiche indifferenziate. Segue la fase esecutiva dei controlli, svolti secondo modalità condivise e criteri oggettivi. L’analisi sistematica dei dati raccolti permette di individuare criticità ricorrenti e tendenze, mentre la fase finale di miglioramento traduce le evidenze emerse in azioni correttive e preventive. Questo approccio favorisce una gestione più consapevole del contratto e consente di trasformare il controllo in uno strumento di programmazione e prevenzione.
FM pubblico verso una nuova maturità
La UNI/PdR 188 nasce insomma dalla consapevolezza che il governo dei contratti di servizi non possa più basarsi su interventi episodici o modelli disomogenei. In un contesto normativo che richiede responsabilità, tracciabilità e orientamento al risultato, la Prassi offre alle amministrazioni uno strumento concreto, proporzionato e immediatamente applicabile e, di riflesso, è utile anche per i fornitori di servizi. Non introduce nuovi aggravi burocratici, ma organizza (e ottimizza) pratiche già esistenti,
rendendole coerenti e tracciabili. Il controllo si trasforma così da obbligo formale a leva gestionale capace di garantire qualità, continuità e trasparenza nell’erogazione dei servizi pubblici. In questa prospettiva, la PdR 188 rappresenta un passaggio significativo nel percorso di maturazione del settore del Facility Management, contribuendo a rinsaldare il rapporto di fiducia tra amministrazioni, operatori economici e fruitori finali.

Il tema della sicurezza degli operatori sanitari è oggi al centro di un acceso dibattito. Le aggressioni sono all’ordine del giorno, e dopo il Covid i numeri sono schizzati alle stelle, con casi anche molto gravi. Qui una sintesi del quadro nazionale e un focus su una best practice: l’impegno concreto della Regione Toscana per prevenire e affrontare il problema.
di Giuseppe Fusto
Loavevamo anticipato proprio su queste pagine diversi mesi fa, e oggi ci troviamo di fronte a una vera e propria esplosione del problema: le aggressioni in ospedale, a partire dal reparto “di frontiera” per eccellenza, vale a dire il Pronto Soccorso, stanno superando la soglia di guardia. Anzi, dati alla mano lo hanno già fatto per numero, intensità e gravità degli episodi.
Una priorità per il sistema sanitario
Così, negli ultimi anni - soprattutto dopo la stagione pandemica - la sicurezza degli operatori sanitari e socio-sanitari è diventata una priorità imprescindibile per il sistema sanitario italiano. Va detto, in premessa, che le aggressioni nei luoghi di cura rappresentano un fenomeno che produce conseguenze profonde non solo sulla salute psicofisica dei professionisti coinvolti, ma anche sull’efficienza dei servizi, sulla qualità dell’assistenza e sull’equilibrio organizzativo delle strutture sanitarie: ne va, insomma, della salute di tutti. La tutela del personale, pertanto, non riguarda soltanto la sfera individuale del lavoratore, ma incide direttamente sulla capacità del sistema sanitario di garantire cure tempestive ed efficaci ai cittadini. D’altra parte come si fa a lavorare sereni, e a svolgere in tranquillità una professione tanto complicata, se ci si sente perennemente minacciati?
I dati nazionali: la fotografia del fenomeno
Del resto, i dati, come sempre, dicono più di mille parole. Un quadro aggiornato della situazione emerge dalla Relazione annuale pubblicata dal Ministero della Salute in occasione della Giornata nazionale di educazione e prevenzione contro la violenza nei confronti degli operatori sanitari e socio-sanitari del 12 marzo scorso. Il documento, elaborato dall’Onseps - Osservatorio nazionale sulla sicurezza degli esercenti le professioni sanitarie e socio-sanitarie - istituito per legge proprio con l’obiettivo di assicurare un lavoro sinergico da parte delle istituzioni - mette in evidenza come nel 2025 siano state registrate quasi 18mila aggressioni a danno del personale sanitario e socio-sanitario. Gli operatori coinvolti superano le 23mila unità (per la precisione 23.367), dato che uno stesso episodio può colpire più persone.
Un’emergenza in crescita
Allarmanti sono le parole con cui inizia la relazione: “La crescita esponenziale e preoccupante di episodi di violenza nei confronti degli esercenti le professioni sanitarie e socio-sanitarie ha portato le diverse istituzioni operanti nel sistema a realizzare nel tempo specifici monitoraggi, documenti, raccomandazioni con finalità diverse. Spesso si tratta di forme di violenza provenienti dagli stessi pazienti o

dai loro caregiver, che si traducono in aggressioni fisiche, verbali o di comportamento”. Una fotografia della realtà che non manca di far riflettere.
Stabilità delle segnalazioni e aumento degli operatori coinvolti
Ma torniamo ai numeri: il totale complessivo delle segnalazioni risulta sostanzialmente stabile rispetto all’anno precedente, quando erano stati rilevati 18.392 episodi. Cresce però il totale degli operatori coinvolti, che passa dai circa 22mila del 2024 agli oltre 23mila nel 2025, come abbiamo appena visto. Questo dato suggerisce una maggiore esposizione del personale a eventi che coinvolgono più professionisti contemporaneamente, e apre uno squarcio sulla crescente intensità, portata e gravità degli episodi di violenza.
Identikit delle aggressioni
La relazione mette in luce anche le caratteristiche principali del fenomeno. Gli aggressori sono prevalentemente pazienti, seguiti da familiari o caregiver. Se fino a qualche anno fa si trattava di fenomeni relativamente contenuti, oggi stanno purtroppo diventando una brutta “regola”. Le forme di violenza risultano per lo più verbali, rappresentando il 69% dei casi, ma non lasciamoci ingannare: le aggressioni fisiche costituiscono ben il 25% (una su quattro) e gli atti contro beni e

strutture il restante 6%. Le donne sono le più colpite, con percentuali che nella maggior parte delle regioni superano il 60% delle vittime.
Le professioni più esposte
Dal punto di vista professionale, le categorie maggiormente esposte sono gli infermieri, che rappresentano il 55% dei casi segnalati, seguiti dai medici con il 16% e dagli operatori socio-sanitari con l’11%. Un ulteriore 12% delle aggressioni riguarda altre figure professionali, tra cui personale non sanitario, addetti al front office, vigilanti, soccorritori e operatori dei servizi di supporto. Nessuno, insomma, può veramente sentirsi al sicuro.
I contesti più a rischio
Per quanto riguarda i luoghi in cui gli episodi si verificano con maggiore frequenza, il contesto ospedaliero risulta il più esposto. In particolare, le aree maggiormente interessate sono i Pronto Soccorso, i Servizi Psichiatrici di Diagnosi e Cura e, poi, i reparti di degenza. Rimangono invece sostanzialmente stabili le segnalazioni negli istituti penitenziari, che nel 2025 registrano 428 episodi contro i 433 dell’anno precedente. La relazione sottolinea inoltre che l’incremento delle segnalazioni può essere collegato anche a una crescente diffusione della cultura della denuncia, più che a un effettivo aumento degli episodi di violenza: stando a questa lettura, ciò che un tempo veniva sostanzialmente “accettato” ora non lo è più.
L’aggiornamento della Raccomandazione ministeriale
Veniamo però alla pars construens. È chiaro infatti che, qualunque ne sia la ragione, una situazione del genere non può passare sotto silenzio. In tale ottica, per rafforzare la sicurezza nei luoghi di cura, il Ministero della Salute ha aggiornato la Raccomandazione ministeriale n. 8 sulla prevenzione degli atti di violenza contro gli operatori sanitari e socio-sanitari, ampliandone il campo di applicazione. Le nuove


indicazioni estendono infatti la tutela non soltanto al personale sanitario e socio-sanitario in senso stretto, ma anche a tutti gli operatori coinvolti nell’assistenza e nei servizi di supporto, come il personale di front office e dei centri unici di prenotazione. Ed è già un passo avanti.
Prevenzione, formazione e supporto psicologico
Il documento - in continuità con quanto sta di fatto avvenendo - pone particolare attenzione alla promozione della cultura della segnalazione degli episodi di violenza e all’analisi dei contesti lavorativi per individuare fattori di rischio e situazioni di vulnerabilità. Vengono inoltre previste misure organizzative e preventive, tra cui il supporto psicologico ai dipendenti vittime di aggressione e specifiche attività formative per aiutare il personale a riconoscere e gestire situazioni potenzialmente critiche.
Collaborazione con le Forze dell’ordine e sicurezza tecnologica
Un ulteriore ambito di intervento riguarda la collaborazione con le Forze dell’ordine. Le recenti disposizioni normative prevedono infatti la possibile istituzione di presidi di polizia nelle strutture sanitarie dotate di reparti di emergenza-urgenza e rafforzano
il coordinamento operativo per migliorare le strategie di prevenzione e gestione delle situazioni a rischio. Si tratta di una sinergia di cui abbiamo già parlato diversi numeri fa su questa rivista, mettendo in luce alcune prassi virtuose (si parlava fra le altre cose di figure educative di raccordo fra visitatori e personale nelle aree di maggiore tensione: antesignani del Facilitatore che vedremo tra poco).
Soluzioni infrastrutturali
Non basta. La Raccomandazione ministeriale indica inoltre diverse soluzioni tecnologiche e infrastrutturali per ridurre i fattori di rischio, come l’installazione di pulsanti antipanico e allarmi portatili nelle aree più esposte, l’attivazione di sistemi di videosorveglianza operativi 24 ore su 24 nel rispetto della normativa sulla privacy, l’impiego di metal detector fissi o portatili e, nei contesti più critici, l’utilizzo di dispositivi audio-video e body-cam per il personale maggiormente esposto.
Ridurre lo stress dell’utenza per prevenire i conflitti
Notevole attenzione viene dedicata anche alla riduzione dei fattori di stress per gli utenti, riconosciuti come possibili elementi scatenanti di tensioni. Tra le misure suggerite
figurano la creazione di spazi di accoglienza più confortevoli, l’adozione di sistemi informativi che aggiornino i pazienti su tempi di attesa e situazioni di sovraffollamento e l’installazione di segnaletica che ricordi ai cittadini come gli atti di violenza costituiscano reato.
All’interno di questo quadro nazionale si inserisce il percorso strutturato avviato dalla Regione Toscana, che già dal luglio 2018 ha intrapreso un programma organico di prevenzione e contrasto alle aggressioni contro il personale sanitario e socio-sanitario. In particolare, la Regione ha promosso l’adozione di misure uniformi da parte delle aziende del Servizio Sanitario Regionale e ha istituito un Osservatorio regionale con funzioni di monitoraggio e indirizzo.
Monitoraggio costante e coinvolgimento dei professionisti
L’Osservatorio raccoglie sistematicamente le segnalazioni degli episodi di violenza, indipendentemente dalla loro gravità, analizza i dati in forma aggregata, verifica l’attuazione delle misure preventive e propone azioni di miglioramento dei livelli di sicurezza. Il coordinamento è affidato alla Regione e coinvolge professionisti impegnati nella sicurezza sul lavoro, tra cui responsabili dei servizi di prevenzione e protezione, medici competenti e rappresentanti dei lavoratori per la sicurezza, valorizzando così l’esperienza diretta maturata nelle strutture sanitarie.
Linee di indirizzo regionali e strategie condivise
Nel tempo sono state elaborate specifiche Linee di indirizzo regionali, aggiornate nel 2025, con l’obiettivo di rendere omogenee le procedure di prevenzione e gestione degli episodi di violenza, uniformare la presa in carico degli operatori aggrediti e migliorare i sistemi di segnalazione. Un gruppo di lavoro multidisciplinare regionale contribuisce inoltre alla definizione di strategie preventive condivise e all’aggiornamento costante delle misure di sicurezza.
Investimenti in infrastrutture, tecnologia e formazione
Accanto agli strumenti organizzativi, la Regione Toscana ha investito in modo significativo nel potenziamento delle infrastrutture e delle tecnologie di protezione, affiancando a tali interventi programmi di formazione
del personale e iniziative di comunicazione rivolte alla cittadinanza per promuovere una cultura del rispetto nei confronti degli operatori sanitari. Si tratta dunque di un intervento “a tutto tondo”, che prevede di operare su più fronti.
Alcuni esempi
Entrando più nel concreto, fra le principali misure adottate rientrano l’installazione di sistemi di videosorveglianza interni ed esterni, l’attivazione di pulsanti di emergenza collegati a centrali operative, l’introduzione di sistemi di controllo degli accessi tramite badge elettronici e la sperimentazione di dispositivi indossabili dotati di geolocalizzazione per le chiamate di emergenza. Per sostenere queste azioni sono stati stanziati oltre 2,1 milioni di euro, distribuiti tra le aziende sanitarie regionali in base alle specifiche esigenze organizzative e alle valutazioni del rischio presenti nei diversi contesti operativi.
Tutela legale e protezione istituzionale degli operatori
Particolare rilievo è stato attribuito anche alla tutela legale del personale aggredito. Le aziende sanitarie sono state infatti indirizzate ad adottare procedure formali per la gestione delle segnalazioni, prevedendo la valutazione della rilevanza penale degli episodi da parte degli uffici legali, la presentazione di denunce o querele nei casi più gravi, la possibilità di costituirsi parte civile nei procedimenti penali e l’eventuale avvio di azioni civili per il risarcimento dei danni, compresi quelli d’immagine. È inoltre promossa la definizione di protocolli operativi con le forze di polizia per garantire interventi tempestivi nelle situazioni di emergenza.
Un modello innovativo: il
Facilitatore relazionale
Tra le iniziative più innovative avviate a livello regionale si distingue infine l’introduzione sperimentale della figura del Facilitatore relazionale nei Pronto Soccorso delle strutture sanitarie con maggiore affluenza. Si tratta di un professionista non sanitario che svolge funzioni di mediazione tra pazienti, familiari e operatori, mantenendo una posizione di neutralità rispetto ai percorsi clinico-assistenziali.
Una figura specifica
Questa figura possiede competenze comunicative e psicologiche specifiche per la gestione dei conflitti, è in grado di riconoscere precocemente i segnali di tensione e applica
tecniche di de-escalation per prevenire l’insorgere di situazioni critiche, contribuendo a creare un clima più sereno e collaborativo all’interno dei reparti di emergenza. Il progetto, della durata di un anno, prevede l’impiego complessivo di 48 facilitatori ed è finanziato con uno stanziamento di 1,5 milioni di euro.
Verso una cultura condivisa della sicurezza
Considerate nel loro insieme, le iniziative promosse a livello nazionale e regionale delineano un approccio integrato e lungimiran-
te alla sicurezza, fondato sulla prevenzione organizzativa, sull’innovazione tecnologica, sulla formazione continua, sulla sensibilizzazione dei cittadini, sulla tutela legale degli operatori e sulla gestione delle dinamiche relazionali nei contesti ad alta tensione. Proteggere medici, infermieri e operatori socio-sanitari significa infatti salvaguardare il cuore del servizio sanitario pubblico e garantire ai cittadini cure più sicure, efficaci e umane. Le buone prassi non mancano, per la serenità e la tranquillità di tutti.

Negli ultimi anni la domanda di sicurezza in Italia è cresciuta, spinta da un lato dall’aumento di alcuni reati, dall’altro dal senso di insicurezza percepito dall’opinione pubblica. Il settore della vigilanza privata, complementare alle forze dell’ordine, è diventato un attore centrale nella protezione di imprese e nella PA.


Secondo il Rapporto Univ-Censis 2025, in Italia sono attive quasi 1.700 imprese di vigilanza e servizi collegati, con circa 94.000 addetti. Un comparto che sta investendo in formazione degli addetti e nuove tecnologie. A dare rilievo al ruolo della vigilanza privata è anche il sentimento degli italiani, rilevato dallo stesso rapporto: quasi il 65% ritiene che lo Stato non sia in grado di garantire da solo la sicurezza, e oltre il 74% considera la vigilanza privata indispensabile. Circa 12 milioni di italiani hanno avuto contatti con operatori di sicurezza privata, spesso ricevendo assistenza concreta in situazioni di aggressioni, furti o violenze.
L’Istituto di Vigilanza Coopservice S.p.A. rappresenta un punto di riferimento per i servizi di vigilanza e sicurezza nel panorama italiano: dispone di 10 centrali operative attive 24 ore su 24, 7 giorni su 7, che gestiscono ogni anno oltre 470.000 allarmi
e monitorano le immagini di più di 9.600 telecamere di videosorveglianza. Rilevanti anche i numeri del pronto intervento sul territorio: circa 86.500 uscite annue delle pattuglie in risposta alle segnalazioni. Due delle centrali hanno ottenuto la certificazione CEI EN 50518:2020, uno standard europeo che attesta l’elevato livello di sicurezza e la dotazione tecnologica delle infrastrutture. La sua attività si caratterizza per i servizi prestati alla pubblica amministrazione, al comparto sanitario (Pronto Soccorso) e alle imprese di ogni dimensione. Nel settore sanitario presta i propri servizi di vigilanza in 31 Ospedali e Policlinici di tutta Italia e in 30 Pronto Soccorso ospedalieri. L’azienda ha un organico di circa 4.000 persone, di cui 2.550 guardie giurate. Anche per il 2026 sono previste numerose assunzioni, anche tramite i Recruiting Day organizzati con i centri per l’impiego territoriali. Ne parliamo con il direttore commerciale Sabino Fort.

L’Istituto di Vigilanza Coopservice è oggi tra i principali player del settore: quali sono stati i fattori chiave di questa crescita?
“La crescita di IVC deriva da oltre 40 anni di presenza sul mercato, prima come divisione interna di Coopservice e ora come S.p.A. Anni in cui l’azienda ha saputo investire in modo intelligente su diversi asset: dalle acquisizioni all’ampliamento dei servizi, dalla formazione continua degli operatori all’innovazione tecnologica, integrandola al meglio con la componente umana. Questi elementi hanno fatto sì che Istituto di Vigilanza Coopservice divenisse sinonimo di un servizio eccellente, riconosciuto da oltre 15 mila clienti tra enti pubblici, imprese, esercizi commerciali e privati cittadini. L’azienda ha investito in un modello capace di anticipare le esigenze dei clienti con soluzioni integrate, centrali operative all’avanguardia e operatori di grandissima professionalità. Inoltre,
l’attenzione alle persone, all’etica del lavoro, all’ambiente, al territorio, ha consolidato la reputazione di IVC nel settore della vigilanza privata”.
Gestite oltre 470.000 allarmi l’anno: quali sono le principali problematiche per volumi così elevati?
“La principale complessità è distinguere rapidamente i falsi allarmi da quelli reali, garantendo tempi di reazione immediati. La gestione richiede sistemi tecnologici evoluti, capacità di analisi, operatori formati e aggiornati e un coordinamento costante tra centrali operative e pattuglie. Il volume elevato impone processi rigorosi e un’infrastruttura tecnologica affidabile che supporti monitoraggio continuo e interventi tempestivi. Fortunatamente l’intelligenza artificiale applicata, ad esempio, alla videosorveglianza, consente oggi di diminuire drasticamente i falsi positivi, efficientando il servizio in
maniera importante. Operatori di centrale e pattuglie possono così concentrarsi su attività realmente critiche e intervenire di conseguenza. Un’ulteriore evoluzione riguarda l’utilizzo di software di correlazione in grado di assegnare una priorità agli eventi (in base agli orari di ricezione, delle aree di generazione e del numero degli eventi) in modo da essere proattivi e concentrati sugli alert ritenuti critici, eliminando il cosiddetto rumore di fondo degli eventi meno importanti”.
Che importanza ha l’utilizzo delle nuove tecnologie nelle attività di vigilanza e quali sono?
“La tecnologia è un fattore abilitante per la qualità del servizio: videosorveglianza e video ronde con AI, ad esempio, permettono interventi più veloci, mirati ed efficienti e, come detto in precedenza, mitigano i falsi allarmi consentendo agli operatori di concentrarsi sugli eventi critici. Questo rende il servizio di vigilanza anche ecosostenibile: diminuendo gli interventi delle pattuglie diminuisce anche l’impatto dell’inquinamento generato dalle autovetture.
Inoltre, con le innovazioni attuali i servizi di security sono sempre più orientati ad un’analisi predittiva, in grado di leggere determinati segnali per prevenire il verificarsi di situazioni di rischio. Se ci pensiamo bene è un vero e proprio cambio di paradigma: si passa dalla “reazione” ad un evento alla “prevenzione” dello stesso”.
Ospedali e pronto soccorso sono ambienti sempre più complessi: come si gestiscono situazioni critiche come emergenze, tensioni o accessi non autorizzati?
“Secondo l’Osservatorio nazionale sulla sicurezza degli esercenti le professioni sanitarie, nel 2025 ci sono state oltre 18 mila aggressioni che hanno coinvolto più di 23mila professionisti sanitari e socio-sanitari.
È chiaro che in questi contesti è necessario integrare più elementi ma di certo sono fondamentali l’esperienza e la preparazione delle Guardie Particolari Giurate e degli au-


siliari alla sicurezza, la cui sensibilità e capacità di comprensione della situazione risulta decisiva per mediare o intervenire. Parliamo di situazioni in cui l’emotività dei pazienti o dei familiari può portare a superare i normali limiti e operatori preparati possono fare la differenza. Esistono poi tecnologie utili ad aumentare il livello di protezione, come la videosorveglianza, i pulsanti antipanico o l’audio detection, che permette di attivare alert in base a situazioni di pericolo, mentre sistemi di deterrenza vocale possono emettere messaggi di avviso automatici in risposta ad eventi rilevati dalle telecamere. Ci sono poi le bodycam, fornite sia alle GPG che al
personale sanitario. Sono tutte soluzioni che vanno integrate in un “ecosistema” di sicurezza per essere efficaci riducendo i tempi di reazione o prevenendo le criticità”.
Che tipo di formazione ricevono le guardie giurate destinate ai contesti sanitari?
“Chi opera in ambito sanitario necessita di una formazione specifica per gestire situazioni di aggressività, emergenze improvvise, accessi non autorizzati. In Istituto di Vigilanza Coopservice crediamo fermamente nella formazione continua come valore aggiunto nell’erogazione del servizio e facciamo
in modo che le nostre Guardie Particolari Giurate siano preparate a gestire in maniera ineccepibile ogni circostanza. Particolare attenzione, nella formazione, viene dedicata alla gestione delle aggressioni, verbali e fisiche, basata su prevenzione, de-escalation verbale e sicurezza fisica ed alla mediazione culturale. La formazione viene erogata attraverso Security & Training S.r.l. società del Gruppo Coopservice”.
Quando scatta un allarme, quanto conta ancora il fattore umano rispetto alla tecnologia?
“La tecnologia interviene oggi con un grado di precisione crescente, ma il fattore umano resta decisivo: è la persona a valutare il contesto, interpretare situazioni non codificabili dall’AI e decidere l’intervento più appropriato. L’intelligenza artificiale non esclude del tutto i falsi positivi, dunque è sempre la persona a determinare le azioni seguenti all’alert. L’integrazione virtuosa tra sistemi intelligenti e operatori qualificati è ciò che garantisce affidabilità e qualità al servizio”.
Cosa rende Istituto di Vigilanza Coopservice unico rispetto al resto del mercato?
“Istituto di Vigilanza Coopservice si pone come Security Services Provider, unica realtà che offre un modello integrato che coniuga tecnologie avanzate, un’ampia presenza territoriale con ben dieci centrali operative e una cultura aziendale fortemente orientata all’etica e qualità del lavoro, come testimoniato dalle numerose certificazioni conseguite. IVC è un partner privilegiato che può offrire una gamma di servizi che rendono la security un asset aziendale in grado di creare valore per l’impresa. La nostra è una nuova visione della sicurezza, dove l’obiettivo è anticipare il rischio e garantire alle imprese affidabilità ed efficienza con interventi rapidi e mirati, sviluppando anche delle soluzioni che integrano ambiti di safety e di sicurezza informatica. L’esempio più recente è la Smart Video Box, una periferica video interamente sviluppata dalla nostra Divisione Innovation&Technology grazie alla quale il rischio di attacchi cyber verso l’azienda cliente è ridotto al minimo rispetto alle comuni tecnologie offerte dagli altri operatori. Di recente abbiamo lanciato sul mercato altri servizi esclusivi come i droni di terra guidati dall’AI e le Video ronde randomiche volte a ridurre il numero di passaggi ispettivi”.


Nel settore sanitario, il procurement è da sempre una delle aree più critiche, per volumi di spesa e complessità di forniture e servizi.
Introdurre un sistema di rating cambia le regole della competizione: non conta più solo l’offerta economica, ma anche la qualità della governance interna dell’impresa, che diventa così un fattore competitivo.
di Massimiliano Brugnoletti
Studio Legale Brugnoletti e Associati
Premessa
Il rating di legalità rappresenta uno degli strumenti più rilevanti, introdotti negli ultimi anni nel sistema italiano, per promuovere comportamenti imprenditoriali improntati a trasparenza, correttezza e rispetto delle regole. Con la delibera n. 31812 del 27 gennaio 2026, l’Autorità Garante della Concorrenza e del Mercato ha adottato il nuovo Regolamento, pubblicato in Gazzetta il 10 febbraio ed entrato in vigore il 16 marzo. La riforma introduce modifiche significative, volte a rafforzare l’efficacia del rating, adattandolo alle esigenze attuali del sistema economico.
Il rating di legalità costituisce un indicatore reputazionale delle imprese, riconosciuto a quelle che dimostrano il rispetto a standard di legalità, correttezza gestionale e compliance normativa. Esso è stato introdotto dall’art. 5-ter del d.l. n. 1/2012, con l’obiettivo di promuovere comportamenti virtuosi nel tessuto imprenditoriale e rafforzare la fiducia nei rapporti tra imprese, pubbliche amministrazioni e sistema bancario. Il rating ha assunto nel tempo una funzione sempre più rilevante per l’accesso al credito, la partecipazione alle gare pubbliche e la valutazione dell’affidabilità delle imprese.
Il nuovo Regolamento
Il Regolamento entrato in vigore il 16 marzo imprime una revisione significativa alla disciplina, mirando a rafforzare la credibilità e l’efficacia del rating come strumento di valutazione dell’affidabilità delle imprese. Una delle novità più significative riguarda l’estensione della durata del rating, che passa da due a tre anni; riducendo così gli oneri amministrativi e la frequenza delle procedure di rinnovo. La maggiore durata contribuisce a rafforzare la stabilità del sistema di valutazione. Il Regolamento introduce poi meccanismi premiali per le imprese che
mantengono nel tempo elevati standard di legalità: è previsto un punteggio aggiuntivo per l’operatore economico che, al momento del rinnovo, abbia mantenuto il rating per almeno tre cicli consecutivi; incentivando così comportamenti virtuosi di lungo periodo. Un ulteriore elemento riguarda il rafforzamento dei controlli e l’ampliamento delle cause ostative all’attribuzione del rating: si prevedono nuove fattispecie ostative, l’ampliamento dei soggetti rilevanti e conseguenze più severe in caso di violazione degli obblighi informativi. Accanto ai controlli, il nuovo Regolamento valorizza elementi che contribuiscono all’incremento del punteggio: tra questi assume rilievo la concreta (non formale) attuazione del Modello Organizzativo 231/2001 e la redazione di un bilancio di sostenibilità o sociale; indicatori questi di buona governance e responsabilità d’impresa.
Il nuovo Regolamento in sanità
La “sanità” rappresenta un contesto complesso, nel quale coesistono logiche di mercato e finalità pubblicistiche: strutture private accreditate, fornitori ed imprese operano in stretto rapporto con il Servizio sanitario nazionale. In questo contesto, il rating di legalità assume un ruolo rilevante, come indicatore di affidabilità delle imprese che interloquiscono con la Sanità pubblica: più che un semplice indicatore reputazionale, il rating assume sempre più il ruolo di leva “silenziosa” di trasformazione dei mercati. La recente revisione del Regolamento si muove in questa direzione: incidere sui comportamenti nel lungo periodo.
In sanità, il punto non è solo premiare imprese virtuose, ma interrogarsi su cosa significhi “affidabilità” quando sono in gioco interessi pubblici, risorse collettive e diritti fondamentali. Il rating di legalità rischia infatti di essere letto e “vissuto” come un elemento formale, non incisivo; mentre la sua evoluzione suggerisce una lettura diversa: il rating è uno strumento capace di spostare l’attenzione dalla conformità episodica alla qualità strutturale dell’organizzazione. In ambito sanitario questo passaggio è rilevante, laddove il procurement è tradizionalmente il punto più esposto a criticità per i grandi volumi di spesa e la complessità tecnica delle forniture e dei servizi acquisiti: inserire il rating in questo contesto significa introdurre una logica di competizione diversa, in cui la governance interna dell’impresa diventa un fattore competitivo. Il vero interrogativo è se il sistema sanitario sia pronto a utilizzare il rating in questa chiave evolutiva. Se ridotto a criterio accessorio rischia di perdere forza; se integrato nei processi decisionali può contribuire a ridisegnare gli equilibri tra pubblico e privato. C’è poi un profilo culturale: la legalità non è più solo limite esterno, ma si configura come componente interna della qualità aziendale. In sanità questo significa avvicinare compliance, sicurezza, etica e fiducia. In definitiva, il rating di legalità si configura come uno strumento che agisce a monte, riducendo le condizioni di rischio.
Conclusioni
Il nuovo Regolamento sul rating di legalità adottato dall’AGCM rafforza il ruolo di questo strumento come indicatore di affidabilità delle imprese e leva di promozione della legalità economica. Le innovazioni introdotte contribuiscono a rendere lo strumento più efficace e coerente con le esigenze attuali del mercato.


Il2026 si preannuncia come un anno decisivo per il futuro della sanità pubblica italiana. Non si tratta di nuove riforme e nemmeno - stavolta lo diciamo con un sospiro di sollievo - di emergenze improvvise, ma di un cambiamento più silenzioso e profondo che riguarda il modo in cui il sistema sanitario sceglie, acquista e investe le proprie risorse. Al centro di questa trasformazione c’è il procurement sanitario, oggi sempre meno funzione
Il 2026 segna la svolta targata FARE: in programma a Bari, il 15 e 16 ottobre, il primo Convegno della Federazione. Un grande laboratorio nazionale dove gli acquisti diventano cura. Ma ci sono anche altri appuntamenti da segnare in agenda, dal Nord al Sud della Penisola. A maggio sarà il Piemonte a ospitare il 6° Congresso promosso da APE – Associazione Economi e Provveditori Piemonte e Valle d’Aosta, a giugno il testimone passerà alla Sicilia con il primo congresso organizzato da AREPS – Associazione Regionale Economi e Provveditori Siciliani. Edicom è la segreteria organizzativa.
dalla Redazione
amministrativa e sempre più leva strategica per garantire qualità delle cure, equità di accesso e sostenibilità del sistema.
Un intenso percorso di riflessione In questo scenario la FARE - Federazione delle Associazioni Regionali degli Economi e Provveditori della Sanità - non poteva certo restare alla finestra. Per questo propone, lungo tutto l’arco dell’anno, un percorso di
riflessione che attraverserà l’Italia da nord a sud snodandosi in tre attesi convegni che culmineranno nell’appuntamento destinato a diventare un punto di riferimento per il settore: il I° Convegno Nazionale FARE, in programma il 15 e 16 ottobre a Bari.
Per due giorni, Bari capitale degli acquisti sanitari
Sarà dunque il capoluogo pugliese a ospita-
re il momento di sintesi di un dibattito che coinvolge professionisti, dirigenti e decisori pubblici chiamati a ripensare il valore degli acquisti in sanità in un’epoca di rapide innovazioni tecnologiche e risorse sempre più limitate. La sede scelta è il The Nicolaus Hotel, che per due giorni diventerà il centro nevralgico del procurement sanitario italiano. Qui convergeranno economi e provveditori, buyer ospedalieri, farmacisti, ingegneri clinici, direzioni strategiche delle aziende sanitarie, centrali di committenza e soggetti aggregatori provenienti da tutto il Paese.
Acquistare bene per garantire salute
Il titolo del convegno è già di per sé una dichiarazione di intenti: “Acquistiamo salute! Il procurement sanitario tra innovazione, equità e sostenibilità. Il valore delle scelte per la cura dei pazienti.” Non uno slogan, ma il claim di un vero cambio di paradigma culturale. Perché oggi acquistare dispositivi medici, tecnologie, servizi e forniture non significa soltanto rispettare procedure e vincoli di bilancio: vuol dire incidere direttamente sulla qualità della vita dei pazienti, sulla rapidità delle diagnosi, sull’efficacia delle terapie e sull’accessibilità dei servizi assistenziali. In altre parole, ogni decisione d’acquisto diventa una scelta di salute pubblica.
Il procurement come leva strategica della sanità del futuro
Il convegno nasce con un obiettivo preciso: ridefinire il ruolo strategico del procurement nel Servizio Sanitario Nazionale. Un sistema che non può più permettersi sprechi, duplicazioni o investimenti inefficaci, ma che allo stesso tempo deve saper integrare innovazione tecnologica, sostenibilità economica e tutela dei diritti dei cittadini. In quest’ottica l’evento propone una riflessione sul ruolo strategico del procurement sanitario come leva determinante per la qualità delle cure, ponendo al centro il paziente come destinatario finale delle scelte. L’attenzione è rivolta all’impatto concreto che i modelli di acquisto producono sui percorsi di cura, sull’accesso ai servizi e sulla tutela della salute, tenendo conto delle indicazioni nazionali sulla presa in carico dei pazienti.
I lavori del Convegno Nazionale
Durante le quattro sessioni plenarie (che si alterneranno a un ricco programma di seminari tematici paralleli) emergeranno le grandi direttrici del cambiamento. Si parlerà - prima sessione - di procurement strategico, tema che
chiama in causa la capacità dei decisori pubblici di bilanciare rigidità normative, responsabilità amministrative e priorità cliniche. Un equilibrio complesso, in cui l’obiettivo non è soltanto la correttezza formale delle procedure, ma l’efficacia sostanziale della spesa sanitaria. Grande attenzione, nella II sessione, sarà dedicata all’impatto dell’intelligenza artificiale nei processi di gara. Le nuove tecnologie promettono di velocizzare analisi, valutazioni e
comparazioni, ma aprono interrogativi cruciali sul piano etico, organizzativo e giuridico: trasparenza degli algoritmi, responsabilità delle decisioni automatizzate, protezione dei dati sensibili.
Servizi ad alto valore ed evoluzione normativa
Un altro asse centrale del confronto (III sessione) riguarderà la scelta di servizi ad alto valore per l’assistenza territoriale e domiciliare, tema strettamente connesso alla riorganizzazione della sanità di prossimità. La progressiva transizione dall’ospedale al territorio impone



modelli di acquisto capaci di sostenere cure domiciliari, telemedicina, presa in carico continuativa e integrazione socio-sanitaria. Infine, nella IV sessione, ampio spazio sarà dedicato all’evoluzione normativa e al dialogo tra codici e giurisprudenza, per comprendere se le recenti riforme e i correttivi al Codice degli appalti rappresentino strumenti realmente in grado di semplificare e rendere più efficaci i processi di acquisto pubblici.
Il paziente al centro delle scelte di acquisto
Ben chiaro il filo conduttore dell’evento: superare la logica dell’acquisto come adempimento burocratico per abbracciare una visione orientata agli esiti di salute. Ciò significa innanzitutto misurare il valore di un bene o di un servizio non solo in termini di costo, ma in relazione ai benefici clinici, alla qualità dei percorsi assistenziali e all’impatto sulla vita dei pazienti: un cambio di prospettiva che ridefinisce anche le competenze richieste ai professionisti del settore, chiamati a integrare conoscenze economiche, giuridiche, tecnologiche e sanitarie in un processo decisionale sempre più complesso e multidisciplinare. Il procurement sanitario diventa così un crocevia tra governance pubblica, innovazione industriale e bisogni reali delle persone.
Le tappe che preparano il confronto nazionale
Ma quello barese non è l’unico save the date da segnare in agenda. Il percorso di avvici-
namento al grande appuntamento autunnale prenderà il via già nei mesi precedenti, con due eventi regionali che rappresentano altrettante importanti tappe del dibattito. A maggio sarà il Piemonte a ospitare il 6° Congresso promosso da APE – Associazione Economi e Provveditori Piemonte e Valle d’Aosta (che festeggia il suo 55° anniversario), occasione di confronto su digitalizzazione, intelligenza artificiale e modelli innovativi di gestione degli appalti pubblici. Il Congresso, in programma il 21 e 22 maggio presso La Porta delle Langhe a Cherasco, è dedicato ai temi dell’innovazione e dell’evoluzione del procurement nella sanità pubblica, con particolare attenzione alla digitalizzazione dei processi, ai modelli di acquisto basati sul valore e alla gestione operativa degli appalti.
Value-Based procurement e pubblico-privato
Dopo l’apertura istituzionale, i lavori entreranno nel vivo con una sessione dedicata alla digitalizzazione e all’intelligenza artificiale applicate ai processi di acquisto sanitari. Una tavola rotonda approfondirà il tema del Value Based Procurement, modello orientato a valorizzare gli acquisti pubblici in funzione degli esiti clinici e dei benefici per il paziente, superando la logica del prezzo. Il secondo giorno ospiterà un focus sugli appalti innovativi e sulle opportunità offerte dal partenariato pubblico-privato. L’ultima sessione sarà dedicata alla fase esecutiva dei contratti pubblici, con un approfondimento sul ruolo del Responsabile Unico del Procedimento,
del Direttore dell’Esecuzione del Contratto e delle altre figure tecniche coinvolte nella gestione operativa degli appalti.
A proposito di RUP: a giugno il testimone passerà invece alla Sicilia con il primo congresso organizzato da AREPS – Associazione Regionale Economi e Provveditori Siciliani. L’evento accenderà i riflettori proprio sul ruolo del Responsabile Unico del Procedimento, figura centrale nei contratti pubblici, analizzandone responsabilità, competenze e funzioni alla luce delle nuove sfide poste dall’innovazione tecnologica e dall’evoluzione normativa. L’evento nasce con l’obiettivo di offrire un momento di confronto qualificato sulle questioni di maggiore attualità legate alla gestione degli acquisti in sanità, al ruolo delle figure tecniche coinvolte e all’evoluzione normativa e tecnologica del settore.
Le tematiche nel dettaglio
Fra i temi che verranno trattati: gli strumenti a supporto del RUP e del farmacista nella costruzione del fabbisogno; il ruolo del RUP e dell’ingegnere clinico nell’ambito dell’intelligenza artificiale, dell’innovazione tecnologica e della cybersicurezza; le gare ad esiti di efficacia clinica e l’applicazione del Value Based Procurement; le diverse forme di responsabilità, dalla fase di programmazione a quella di esecuzione dei contratti.
Acquistare bene per curare meglio
Ciò che è innegabile è che sta emergendo con forza una nuova identità professionale: economi e provveditori non sono più soltanto funzionari chiamati a gestire gare e capitolati, ma attori strategici delle politiche sanitarie. Le loro decisioni incidono infatti, in misura sempre maggiore, sull’introduzione di tecnologie innovative, sulla qualità delle forniture, sull’efficienza dei servizi ospedalieri e territoriali e, in ultima analisi, sulla tutela del diritto alla salute. Perché acquistare bene significa, davvero, curare meglio.


Lamanifestazione, che da sempre rappresenta un osservatorio privilegiato sulle innovazioni del settore, quest’anno pone al centro dell’attenzione l’Intelligenza Artificiale e le tecnologie hi-tech, con l’obiettivo di delineare quale sanità ci attende nel prossimo futuro. Suddivisa in cinque Saloni espositivi, offre una panoramica completa sul knowhow più innovativo nel mondo della sanità e della sua gestione amministrativa e organizzativa. L’apporto delle nuove tecnologie alla medicina è ormai indiscutibile. Dal supporto diagnostico alle applicazioni cliniche più avanzate, dalla gestione organizzativa dei processi alla valorizzazione del ruolo dei professionisti e dei pazienti, l’Information & Communication Technology (ICT) si configura come una leva fondamentale per migliorare qualità, efficacia e sostenibilità del servizio sanitario. Exposanità 2026 – “Planning Solutions” dedica a queste tematiche i saloni: Horus, Hospital, Diagnostica, Sanità
Digitale e Terza Età, esplorando sfide e opportunità della trasformazione digitale. Convegno inaugurale e iniziative speciali
Ad aprire la manifestazione sarà il convegno inaugurale dal titolo Sfide socio-sanitarie e soluzioni tech. Nuove risposte per garantire il diritto alla cura (22 aprile, ore 10.30, Sala Concerto). L’evento propone un confronto critico sul ruolo del digitale nella sanità, interrogandosi su una domanda centrale: il digitale ci salverà? La sfida è ambiziosa, perché il sistema sanitario si trova a dover affrontare pressioni molteplici: invecchiamento della popolazione, carenza di personale qualificato, sostenibilità economica e complessità nella territorializzazione delle cure. L’innovazione tecnologica non è vista come una bacchetta magica, ma come uno strumento per garantire la salute come diritto universale, come sancito dalla Costituzione. Tra le iniziative speciali, spiccano tre wor-
Exposanità è un appuntamento ormai imprescindibile per chi segue l’evoluzione del Servizio Sanitario nazionale e delle tecnologie che lo supportano. GSA è media partner dell’evento e vi aspetta al PAD 22, Stand 90.
dalla Redazione
kshop dedicati all’uso dell’IA in ambito sanitario, ospitati nel salone Sanità Digitale. Il primo è focalizzato sulla cardiologia, affrontando esperienze, potenzialità e criticità dell’IA nella diagnosi assistita, nella medicina personalizzata e nell’analisi predittiva. In questo contesto, ingegneri clinici e direzioni dei servizi informatici condividono le loro competenze sull’integrazione di dispositivi biomedici e sistemi digitali in un ecosistema unico.
Il secondo workshop si concentra sull’onco-

logia, presentando tre case study significativi che dimostrano il valore della collaborazione interdisciplinare. Infine, il terzo incontro affronta il ruolo dell’IA a supporto delle direzioni sanitarie, esplorando strumenti per ottimizzare l’allocazione della spesa, ridurre le liste d’attesa e migliorare la qualità dell’esperienza di pazienti e operatori. Non manca il tema cruciale della sicurezza informatica, con focus sulla gestione sicura dei dati sanitari e sulle soluzioni tecnologiche per proteggerli.
Intelligenza Artificiale e tecnologie hi-tech
L’innovazione tecnologica richiede investimenti importanti, come sottolinea la dottoressa Chiara Gibertoni, medico e direttore generale dell’IRCCS Policlinico di Sant’Orsola di Bologna: “Dobbiamo fare una premessa: tutte le strutture pubbliche del Servizio sanitario nazionale hanno storicamente difficoltà a realizzare investimenti, perché mancano fondi di finanziamento adeguati e, soprattutto, continui nel tempo. In particolare, nell’ambito delle tecnologie biomediche e informatiche è sempre stata una battaglia riuscire a mantenere le strutture pubbliche aggiornate rispetto alle opportunità che via via si rendono disponibili. C’è però un aspetto distintivo del nostro sistema: quando un’innovazione arriva, arriva per tutti. A differenza di altri Paesi considerati all’avanguardia, il fatto di poter accedere alle innovazioni senza distinzioni di reddito è un elemento che ci caratterizza e ci nobilita. Il PNRR ci ha certamente permesso di realizzare una serie di aggiornamenti, soprattutto


sulle tecnologie più “pesanti” come TAC e risonanze magnetiche, creando i presupposti per l’utilizzo di software più evoluti. Ricordiamoci che l’intelligenza artificiale è anche questo: la possibilità di ottenere ricostruzioni di immagini estremamente sofisticate, distinguere con maggiore precisione i tessuti patologici da quelli sani, oppure personalizzare – attraverso gli acceleratori lineari in radioterapia – il piano terapeutico con un livello di accuratezza superiore all’occhio umano. Grazie all’iniezione di fondi straordinari siamo riusciti a realizzare cambiamenti profondi e radicali sul piano dell’innovazione. Al Sant’Orsola li abbiamo sfruttati fino in fondo, con aggiornamenti tecnologici che aspettavamo da tempo e che non avrebbero avuto altre fonti di finanziamento.”
Quali sono invece i rischi o i limiti da superare?
“Il rischio principale - prosegue Gibertoni - è legato alla cybersecurity. Le aziende sanitarie sono luoghi estremamente sensibili da questo punto di vista e oggi gli attacchi informatici rappresentano una vera e propria strategia globale di destabilizzazione, non più soltanto l’azione di singoli hacker. Il tema degli attacchi cibernetici alle aziende sanitarie ci preoccupa molto. Proteggere un patrimonio così prezioso come le nostre banche dati richiede investimenti enormi in sicurezza, che iniziano ad avere un peso rilevante sui bilanci”.
Che cosa servirebbe?
Servirebbe un approccio più integrato: dall’analisi dei punti di vulnerabilità alla formazione del personale per prevenire fenomeni come il phishing tramite mail o messaggi. Il rischio è altissimo, perché più ci digitalizziamo, più diventiamo vulnerabili. È in arrivo una normativa molto stringente, che entra in vigore proprio in questi mesi, ma che è altrettanto difficile da applicare, sia in termini di investimenti sia di fruibilità del dato nella pratica clinica. Quando si parla di salute, ogni software di supporto deve essere certificato, allenato, garantito e soprattutto reso sicuro. Tutto questo richiede investimenti enormi che, al momento, come aziende pubbliche, fatichiamo a intravedere”, conclude.
GSA e le altre testate del gruppo vi aspettano a Exposanità, Health – Care – Innovation, al PAD. 22, Stand 90.
NEL PEST MANAGEMENT

Gli acari del genere Pyemotes sono noti da inizio ‘900 come causa di dermatiti ma le segnalazioni ai nostri giorni sono molto scarse, tanto da far pensare che questa problematica sia stata dimenticata. I casi però non mancano, almeno dall’osservatorio del mondo del pest management e, anche se il loro riconoscimento può essere problematico, un operatore sanitario attento può riuscirvi con una indagine scrupolosa.
di Lorenzo Donati
L’acaro incriminato è Pyemotes ventricosus, anche se ne esiste almeno un secondo, estremamente simile morfologicamente ed ecologicamente - P. tritici - che causa le medesime problematiche in ambito agrario ed in vari punti della filiera dei cereali. Si tratti dell’uno o dell’altro l’approccio è il medesimo. P. ventricosus è un acaro predatore di varie larve e pupe di insetti legati alle derrate alimentari (come il lepidottero Sitotroga cerealella) e di tarli del legno (in particolare il coleottero Anobium punctatum). Una delle difficoltà nel collegarlo alle dermatiti che causa è la sua dimensione: è praticamente invisibile ad occhio nudo, i maschi sono lunghi appena 0,16 millimetri di media mentre le femmine circa 0,22 millimetri (ma anche fino a 2 millimetri quando gravide). Proprio queste ultime vanno incontro a grossi cambiamenti


Fig.1: femmina di P. ventricosus non gravida (a sinistra); femmina gravida (a destra). (fonte: Del Giudice et al. (2008), Pyemotes ventricosus Dermatitis, Southeastern France; Zelina t al. (2021) Pyemotes ventricosus dermatitis: ‘comet sign’).
morfologici dopo l’accoppiamento con una grande dilatazione dell’addome che contiene le uova e successivamente le forme giovanili degli acari. Quando queste maturano (una temperatura di 24-26°C risulta ottimale) fuoriescono già adulti dall’addome della madre e si accoppiano immediatamente per poi disperdersi rapidamente in cerca di cibo, attratti dall’emissione di anidride carbonica. È stato stimato che, in assenza di un nuovo ospite da parassitizzare, questi acari possano sopravvivere anche 48 ore.
Segni e sintomi
Il meccanismo patogenetico nell’uomo non è totalmente noto ma probabilmente è dovuto alla morfologia dell’apparato boccale che è composto da due cheliceri stilettiformi. L’acaro li infligge ripetutamente nella cute nel tentativo di paralizzare l’ospite e di nutrirsi. Il morso è indolore e i segni si manifestano dopo qualche ora. Il risultato è un’eruzione cutanea estremamente pruriginosa, eritematosa con maculopapule con una microvescicola centrale, localizzate tipicamente su tronco, arti (braccia e gambe) collo e spalle dei pazienti. In circa il 30% dei casi si riscontra anche una lesione patognomica detta “comet sign” ovvero un tratto maculare eritematoso lineare. Queste lesioni risultano essere molto invasive per il paziente che faticherà a dormire per il solo contatto delle lenzuola sulle lesioni, la sensazione di calore associata al forte prurito ed eventuali lesioni secondarie dovute al grattamento. Molto più raramente possono presentarsi febbre, vomito e mal di testa. È stato anche descritto un case report in cui un paziente trentenne presentava segni simili ad una infezione da poxvirus ma la presenza di questo tipo di lesioni è estre -
mamente inusuale. In linea generale queste manifestazioni si risolvono in 7-21 giorni a patto di rimuovere gli acari e i loro focolai di infestazione dagli ambienti frequentati dai pazienti. Diversamente segni e sintomi possono permanere per settimane.
Il problema della diagnosi e qualche suggerimento
La diagnosi non è sempre semplice, oltre ai segni e sintomi, è bene tenere presenti una serie di informazioni aggiuntive e alcuni fattori di rischio. Per prima cosa il periodo: di norma questi casi avvengono tra maggio e ottobre, con un picco nei mesi estivi. I morsi sono generalmente indolori anche se – scrivo per esperienza diretta – questi possono essere avvertiti come punture da piccoli aghi. È compito del medico escludere eziologie diverse da quella infettiva ma qualora si sospetti una infezione, un’anamnesi approfondita, formulando le seguenti domande, potrebbe essere utile per giungere alla diagnosi:
Ha prurito?
Si: possibile dermatite da P. ventricosus. No: escludere P. ventricosus.
Che tipo di lesioni presenta?
Un’eruzione cutanea pruriginosa, eritematosa con maculopapule con una microvescicola centrale: possibile dermatite da P. ventricosus. Come sopra e “Comet sign”: dermatite da P. ventricosus.
Cunicoli sottopelle: valutare lesioni da Sarcoptes scabiei
Dove sono localizzate le lesioni?
Tronco, arti (braccia e gambe), collo, spalle: possibile dermatite da P. ventricosus.
Girovita, caviglie, inguine (dove gli abiti sono occlusivi): valutare lesioni da Trombicula autumnalis (questo acaro vive sulla vegetazione).
Spazi interdigitali o nelle zone flessorie degli arti: valutare lesioni da Sarcoptes scabiei
Ha sentito i morsi/punture dolorosi, da qualche ora a circa 24 ore prima della comparsa dei pomfi?
Si: valutare altri artropodi (vespe, api, ragni, scleroderma, etc).
No / come piccoli aghi: possibile dermatite da P. ventricosus.
Qual è il suo impiego?
La dermatite da P. ventricosus è tipica negli agricoltori (specie in raccolta/post raccolta di grano o altri cereali), nei mugnai, nei restauratori di manufatti lignei, spesso tarlati e dove si accumula molto materiale ligneo. Qualche ora prima della comparsa dei segni sulla pelle ha sostato in prossimità di grandi depositi di grano (es.: molini, mangimifici)?
L’aver sostato o lavorato all’interno di strutture molitorie o mangimifici può determinare l’insorgenza della dermatite da P. ventricosus che è un parassita di insetti legati alle derrate alimentari della filiera cerealicola.
Fig. 2: Fotografie di 5 persone con lesioni cutanee da dermatite da P. ventricosus. Si notino le microvescicole centrali, le ulcerazioni o le croste e alcune lesioni con segno della cometa (evidenti in B, D ed E). (fonte: Del Giudice et al. (2008), Pyemotes ventricosus Dermatitis, Southeastern France).



Fig. 3: due esempi domestici di materiale tarlato utile per lo sviluppo di P. ventricosus. Un mobile la cui schiena presenta tracce di fori di tarlo e legna da ardere evidentemente tarlata.
Ha dormito/soggiornato in una casa vacanze?
Il soggiornare e dormire in case vacanze, spesso chiuse per mesi e con pulizie saltuarie, con mobilio possibilmente tarlato è una situazione tipica per l’insorgenza di dermatite da P. ventricosus
Ha mobili tarlati a casa o al lavoro?
Ha legna da ardere tarlata (es. in abitazione privata, sul luogo di lavoro)?
P. ventricosus è un parassita di larve di tarlo per cui i mobili tarlati e la legna da ardere sono un possibile focolaio di infestazione degli ambienti, specie in concomitanza con lo sfarfallamento dei tarli nella stagione primaverile-estiva.
Ha fatto effettuare una analisi diretta delle polveri ambientali?
L’analisi diretta delle polveri ambientali, effettuata da personale specializzato, è in grado di rilevare la presenza di P. ventricosus e di stimarne il tasso di infestazione, la vitalità e il grado di riproduzione. Effettuata la diagnosi è necessario lavorare su più fronti per una risoluzione rapida del problema. La problematica è autolimitante – nel giro di 1-3 settimane – e di norma viene gestita con terapie sintomatiche con antistaminici e corticosteroidi topici ma a patto che vengano bonificati gli ambienti di vita e lavoro del paziente. È infatti la rimozione della fonte di infestazione che determina nel breve tempo la risoluzione dell’acarosi sulle persone.
L’importanza del sopralluogo e della gestione degli ambienti Tenendo da parte il problema legato ai cereali, che richiede una disinfestazione della massa del cereale (per via dell’infestante primario e poi dell’acaro) e degli ambienti in cui questi sono stoccati, la principale fonte di infestazione nelle abitazioni private o sul posto di lavoro è il legno tarlato. Per determinare se un mobile sospetto (o altri materiali o manufatti lignei) è tarlato o meno si deve per prima cosa verificare che ci sia la presenza di fori. Nel caso del tarlo del legno A. punctatum il foro sui manufatti è circolare, di diametro 1,5 millimetri circa. Se i fori sono presenti occorre poi verificare che “siano attivi” ovvero che la larva del tarlo – preda di P. ventricosus - sia viva. Per farlo si può inserire sotto il mobile/manufatto un foglio di carta bianco e controllare se dopo qualche giorno vi si è depositato sopra della polvere di legno chiara, segno della attività di rosura della larva. I tarli non attaccano mobili impiallacciati, in truciolare o con alti contenuti di colle ma il legno massello, anche se non sempre i fori sono facili da individuare. Conviene analizzare bene nel sopralluogo anche le parti meno visibili del mobile come i piedi e la schiena (la parte contro il muro, spesso grezza) e farsi accompagnare da uno specialista delle disinfestazioni o del restauro. L’analisi delle polveri ambientali resta una ipotesi percorribile per determinare la presenza di P. ventricosus. A questo punto possono aprirsi diversi scenari. Se il problema




Fig.4: varie tipologie di trattamento del legno da parte di professionisti: fumigazione con acido cianidrico (HCN), trattamento con elevate temperature, trattamento con MAP, impiego di microonde.
deriva dalla legna da ardere basterà stoccarla all’esterno e portare all’interno solo il quantitativo immediatamente necessario ed eventualmente nebulizzare sulla catasta degli acaricidi liquidi per contenere la popolazione ed evitare di essere morsi quando si
preleva la legna. Se il problema invece origina da un mobile, un manufatto o un’opera d’arte occorre consultare un restauratore o un disinfestatore per il trattamento del manufatto, asportandolo. L’ultimo caso, il più complicato, è quello in cui sia il legno in opera ad essere tarlato come travi, capriate, etc. Negli ultimi due casi l’obiettivo è quello di risolvere l’infestazione da tarli e abbattere la popolazione degli acari per evitare continue recrudescenze dell’infestazione. Esistono diversi modi per intervenire in maniera professionale: con gas tossici, con atmosfere modificate, con microonde, con calore, con infrarossi o con insetticidi liquidi. I primi cinque metodi devono essere necessariamente eseguiti da un operatore professionale e garantiscono – se ben condotti – l’eliminazione totale di ogni forma vivente sia del tarlo (uova, larva, pupa e adulto se presenti sul mobile) che dell’acaro (uova, larva, ninfa e adulto). L’impiego di gas tossici come, ad esempio, l’acido cianidrico (per ambienti non residenziali), per via delle pericolosità intrinseca delle sostanze impiegate, è sottoposto ad una rigida normativa e il fumigatore professionale – in possesso di tutte le patenti del caso - dovrà valutare la fattibilità del lavoro e la possibilità di poterlo eseguire in sicurezza. Questo prevede la necessità della richiesta per tempo delle licenze alle autorità competenti e rendere gli ambienti sotto trattamento off limits per chiunque non sia impegnato nelle operazioni. Il trattamento di manufatti, mobili od opere d’arte può essere effettuato anche in speciali bolle all’interno delle quali viene modificata la composizione dell’atmosfera, portando l’ossigeno vicino allo 0% e inserendo altri gas inerti come l’azoto, funziona con il principio dell’anossia. È una tecnica molto valida in caso di manufatti di pregio o elevato valore artistico. Le microonde possono essere applicate su piccoli manufatti (immettendoli direttamente dentro stanze ad hoc dette camere di Faraday) purchè non siano manufatti d’arte o delicati (come quelli intarsiati) oppure essere impiegate su legno in opera con speciali macchinari che trasmettono le microonde su una porzione per volta della superficie da trattare ma questa seconda applicazione può presentare alcune criticità: non devono essere sottoposti a trattamento materiali diversi dal legno (ad esempio: cavi elettrici, chiodi o altro materiale che scherma le microonde o genera scintille) inoltre occorre che chi le applica deve valutare accuratamente le potenziali conseguenze della possibile rifrazione di queste microonde ne-
gli ambienti (ad esempio sugli allarmi antincendio, su persone portatrici di pacemaker, ecc.). L’impiego delle elevate temperature è una quarta via, molto pratica per manufatti di piccole e medie dimensioni che vengono stoccate in una camera nella quale la temperatura viene innalzata fino ad arrivare alla temperatura letale per i tarli nel cuore del legno. Per il legno in opera questo metodo potrebbe risultare complicato da applicare. Una variante di questa tecnica è l’impiego di speciali coperte termiche a infrarossi che vengono applicate o come camera o direttamente sul legno in opera per scaldarlo fino
ad eliminare gli infestanti. Il metodo più tradizionale – e meno specializzato - è con prodotti insetticidi liquidi pronto uso o in gel da spalmare. Questi agiscono per ingestione sulle larve e per contatto sugli adulti ma la capacità di penetrazione nel legno dove vive la larva è di pochi millimetri e per questo va ripetuta più volte (accompagnandola a dei trattamenti ambientali per eliminare gli eventuali acari vaganti). Ad ogni modo la lotta ai tarli - e quindi agli acari - è cosa professionale: il consiglio in questo caso è sempre quello di affidarsi a personale competente e specializzato.


Ebli, Ente Bilaterale del settore lavanderie industriali, centrali di sterilizzazione e servizi medici affini, ha incaricato
Ambiente Italia di realizzare uno studio di comparazione dettagliata degli impatti ambientali ed economici dei tessuti utilizzati nelle sale operatorie in ambito sanitario. Si tratta di una delle analisi più approfondite mai prodotte sul tema.
di Umberto Marchi
Qualisono gli impatti ambientali ed economici dei tessuti impiegati in sala operatoria? Si può instaurare un raffronto in questo senso fra il Tessuto non Tessuto (TNT) e i materiali riutilizzabili (TTR, Tessuto Tecnico Riutilizzabile)?
La domanda… non è scontata
La domanda non è affatto banale, perché proprio su questo tema si gioca una partita importante in ambito sanitario. A questo proposito entra in scena un recente studio promosso da Ebli, Ente Bilaterale del settore lavanderie industriali, centrali di sterilizzazione e servizi medici affini, che rappresen-
ta una delle più approfondite analisi tecnico-comparative finora realizzate in Italia sul tema della sostenibilità dei dispositivi tessili impiegati in sala operatoria.
Un’analisi comparativa
L’iniziativa, dal titolo “TTR vs TNT in sala operatoria. Analisi ambientale (Lca) ed economica (Lcc) comparativa dei tessuti riutilizzabili e monouso” nasce dall’esigenza di mettere a disposizione degli operatori della filiera sanitaria strumenti oggettivi di valutazione che consentano di orientare le scelte di approvvigionamento verso soluzioni capaci di coniugare sicurezza clinica, efficienza gestionale e sostenibilità ambientale.

Un gruppo di lavoro multidisciplinare
Per la realizzazione dello studio, Ebli ha affidato l’incarico ad Ambiente Italia, istituto specializzato nelle analisi ambientali di sistema, che ha coordinato un gruppo di lavoro multidisciplinare composto da esperti di processi industriali, valutazioni ambientali, economia sanitaria e gestione dei servizi ospedalieri. Il lavoro ha beneficiato della collaborazione di Assosistema Confindustria, di imprese associate operanti nel settore del lavanolo e della sterilizzazione, di aziende produttrici di tessuti tecnici e di rilevanti realtà del Servizio Sanitario Nazionale, tra cui ASST Bergamo Est,
Azienda Ospedaliera Universitaria di Parma e ASL Toscana Sud Est, che hanno fornito dati operativi rappresentativi delle procedure di gara, dei fabbisogni reali e dei modelli organizzativi adottati dalle stazioni appaltanti.
Sala operatoria osservatorio privilegiato
L’indagine - circa 70 pagine ricche di notizie, indicazioni, dati, schemi e infografiche - si inserisce nel quadro delle politiche nazionali che promuovono la sostenibilità ambientale negli acquisti pubblici, con particolare riferimento all’introduzione dei Criteri Ambientali Minimi per le forniture tessili e i servizi di lavag-
gio e sterilizzazione in ambito sanitario. In questo contesto, la sala operatoria costituisce un osservatorio privilegiato, poiché concentra elevati livelli di consumo di materiali, energia e dispositivi monouso, generando al tempo stesso quantità rilevanti di rifiuti sanitari speciali. La gestione dei tessili assume quindi un ruolo strategico non solo sotto il profilo igienico-sanitario e prestazionale, ma anche in termini di impatto ambientale complessivo del sistema ospedaliero.
Camici e teli operatori
Lo studio ha analizzato in particolare camici chirurgici e teli operatori, selezionati tra le
tipologie più diffuse nelle procedure ospedaliere. I dispositivi monouso sono realizzati in Tessuto Non Tessuto a base di polipropilene e polietilene, con componenti multistrato e trattamenti superficiali funzionali a garantire impermeabilità e barriera microbiologica. I dispositivi riutilizzabili sono invece costituiti da tessuti tecnici ad alte prestazioni con struttura multistrato, membrane traspiranti e trattamenti idrorepellenti, progettati per mantenere nel tempo le caratteristiche di protezione e resistenza meccanica anche dopo numerosi cicli di lavaggio industriale e sterilizzazione.
Le basi del raffronto
Il confronto è stato impostato su basi metodologiche rigorose attraverso la definizione di un’unità funzionale omogenea, che consente di paragonare le due soluzioni in termini di servizio effettivamente reso. In particolare, un singolo dispositivo riutiliz-
zabile è stato considerato equivalente a sessanta dispositivi monouso, ipotizzando per il tessuto tecnico riutilizzabile una vita utile di sessanta cicli certificati di impiego, senza decadimento delle prestazioni di sicurezza, integrità strutturale e funzionalità barriera. Tale impostazione ha permesso di neutralizzare le differenze legate alla durata dei prodotti e di concentrare l’analisi sugli impatti complessivi generati lungo l’intero ciclo di vita.
L’Analisi del Ciclo di Vita è stata condotta secondo gli standard internazionali ISO, adottando un approccio “dalla culla alla tomba” che considera tutte le fasi del processo produttivo e di utilizzo. Sono stati inclusi l’estrazione e la lavorazione delle materie prime, la produzione dei filati e dei tessuti, la confezione dei dispositivi, la fabbricazione degli imbal-


laggi, i trasporti intermedi e finali, l’utilizzo in ambito ospedaliero, i processi di lavaggio industriale e sterilizzazione per i dispositivi riutilizzabili e le operazioni di smaltimento o recupero a fine vita.
I principali flussi
Per ciascuna fase sono stati analizzati i principali flussi di materia ed energia, includendo il consumo di combustibili fossili, l’utilizzo di energia elettrica, il fabbisogno idrico, l’impiego di detergenti e prodotti chimici di processo, la produzione di rifiuti solidi e le emissioni in atmosfera, acqua e suolo. Particolare attenzione è stata dedicata alla valutazione dell’impronta climatica, misurata in termini di emissioni di gas a effetto serra espresse in anidride carbonica equivalente, e agli indicatori aggregati che sintetizzano diverse categorie di impatto ambientale in un unico valore comparabile.
Ma ora veniamo alle evidenze: l’analisi dei risultati evidenzia differenze strutturali nella distribuzione degli impatti tra le due tipologie di prodotti. Nei dispositivi riutilizzabili la fase predominante è costituita dal lavaggio e dalla sterilizzazione (85% sull’impatto), processi che richiedono energia termica ed elettrica, consumo di acqua e utilizzo di detergenti specializzati, seguita da trasporto (12%). Tuttavia, l’elevato numero di riutilizzi consente di ripartire gli impatti della produzione su un lungo periodo di vita utile, riducendone drasticamente il peso percentuale sul bilancio complessivo. Nei dispositivi monouso, invece, la produzione delle materie prime polimeriche e la fabbricazione industriale incidono in misura nettamente superiore (69%), poiché ogni utilizzo richiede la realizzazione di un nuovo prodotto, con conseguente moltiplicazione dei consumi energetici e delle emissioni associate ai processi manifatturieri.

L’impatto del “fine vita”
Ulteriori differenze emergono nella fase di fine vita. I tessili riutilizzabili, al termine del ciclo di impiego, possono essere avviati a diversi percorsi di recupero, tra cui il riciclo meccanico e il riciclo chimico delle fibre sintetiche, oltre allo smaltimento tramite termovalorizzazione o conferimento in discarica (2,5% dell’impatto totale). Nei tessili monouso, la contaminazione biologica e la composizione multistrato rendono invece prevalente il ricorso all’incenerimento, con produzione di emissioni climalteranti e residui solidi (29% dell’impatto). La possibilità di adottare filiere di recupero per i prodotti riutilizzabili contribuisce quindi a ridurre sensibilmente il peso ambientale della fase conclusiva del ciclo di vita.
Le restituzioni quantitative
I risultati quantitativi mostrano che, a parità di servizio reso, i dispositivi riutilizzabili determinano una riduzione significativa delle emissioni climalteranti rispetto ai monouso, con percentuali di miglioramento che si mantengono elevate anche negli scenari di smaltimento meno favorevoli. Analoghe tendenze emergono considerando gli indicatori ambientali aggregati, che evidenziano un abbattimento complessivo degli impatti superiore alla metà per diverse categorie di prodotti analizzati.
I costi del ciclo di vita
Parallelamente, l’Analisi dei Costi del Ciclo di Vita ha permesso di integrare la dimensione ambientale con quella economico-gestionale, prendendo in considerazione i costi di acquisizione dei dispositivi, le spese di logistica e stoccaggio, i costi energetici e idrici dei processi di sanificazione, la manutenzione dei tessili riutilizzabili e gli oneri connessi allo smaltimento finale. L’elaborazione dei dati ha evidenziato che la maggiore durata operativa dei dispositivi riutilizzabili consente di compensare ampiamente i costi legati ai processi di lavaggio e sterilizzazione, determinando risparmi complessivi significativi nel ciclo di vita rispetto alle alternative monouso (si parla di 15 kg Co2 per un camice XL riutilizzabile a fronte di 23 per un TNT, mentre nei teli si passa da 27 kg per TTR a 39 per TNT).
I “costi… nascosti”
Un ulteriore livello di analisi ha riguardato la monetizzazione delle esternalità ambientali, ossia la traduzione in termini economici dei danni prodotti dalle emissioni climalteranti e dall’inquinamento. Questo approccio consente di stimare i costi indiretti che ricadono sulla collettività sotto forma di impatti sanitari, degrado
ambientale e consumo di risorse naturali. Anche sotto questo profilo, i dispositivi riutilizzabili mostrano prestazioni nettamente migliori, poiché la minore impronta emissiva riduce il carico di costi ambientali trasferiti alla società.
Uno studio unico nel suo genere
L’indagine, che rappresenta ad oggi un unicum nel suo genere, fornisce un quadro tecnico integrato di elevato dettaglio, basato su dati primari di filiera e su metodologie di valutazione riconosciute a livello internazionale. I risultati mettono a disposizione delle amministrazioni sanitarie, imprese di lavaggio industriale, dei
fornitori di tessuti tecnici, uno strumento decisionale fondato su evidenze scientifiche, capace di supportare scelte orientate all’efficienza economica e alla sostenibilità ambientale. Stando ai risultati, l’adozione di dispositivi tessili riutilizzabili emerge così non solo come una soluzione tecnologicamente affidabile sotto il profilo sanitario, ma anche come una leva strategica per ridurre l’impronta ecologica del sistema ospedaliero e ottimizzare l’impiego delle risorse pubbliche.


Parliamo di controllo
della Legionella negli impianti idrici e aeraulici di ospedali e strutture sanitarie: la prevenzione parte dalla corretta gestione e manutenzione. La buona notizia è che contenere (e in alcuni casi addirittura azzerare) il rischio si può. Basta mettere in campo le giuste competenze.
di Simone Finotti
Torniamo a parlare di Legionella: un vero e proprio “incubo” che fin dagli anni Settanta (l’origine del nome è del 1976) minaccia gli ospiti di strutture dotate di impianti aeraulici. Un tema che, purtroppo, non passa mai di moda, visti i numeri impressionanti di vittime nel mondo e in Italia: nel 2022, ultimo anno di cui si hanno dati completi, nel nostro Paese si sono registrati oltre 3mila casi (la letalità in condizioni normali si attesta intorno al 10%), con un’incidenza che appare in crescita, il che comporta i costi sociali ed economici che ben sappiamo.
Un rischio microbiologico che nasce negli impianti
Eppure, per contenere il rischio i mezzi non mancano: bisogna innanzitutto conoscere il “nemico”. La legionella pneumophila, come ab-
biamo più volte ricordato in queste pagine, è un batterio naturalmente presente negli ambienti acquatici, ma che diventa rapidamente un problema sanitario quando trova condizioni favorevoli negli impianti idrici o aeraulici artificiali, come accade in contesto sanitario. In queste situazioni può colonizzare tubazioni, serbatoi e dispositivi terminali, diffondersi attraverso aerosol contaminato e provocare la legionellosi, una forma di polmonite che può avere conseguenze severe soprattutto nei soggetti più fragili, come appunto i pazienti ospedalizzati.
Un rischio diffuso anche in ospedale
Non si tratta infatti di un rischio limitato alle grandi strutture industriali o alle torri di raffreddamento. Qualsiasi edificio dotato

di una rete idrica complessa può offrire condizioni favorevoli allo sviluppo del batterio: uffici, hotel, scuole, palestre, strutture residenziali e naturalmente ospedali. In molti casi la contaminazione non è il risultato di un evento improvviso, ma l’esito di una serie di fattori tecnici e gestionali che, nel tempo, creano un ambiente ideale per la proliferazione microbica.
Le condizioni che favoriscono la proliferazione: dalla temperatura… Il meccanismo è ben noto: la Legionella può entrare negli impianti attraverso l’acqua di alimentazione e colonizzare progressivamente la rete di distribuzione. Il batterio si sviluppa in modo particolare quando la temperatura dell’acqua si colloca tra i 25°C e i 45°C, con un optimum di crescita intorno ai 35–37°C. Al di sotto dei 20°C la proliferazione si riduce, mentre temperature superiori ai 60°C risultano generalmente letali per il microrganismo.
… alla presenza di biofilm
Oltre alla temperatura, altri fattori contribuiscono alla colonizzazione dell’impianto: la presenza di biofilm sulle superfici interne

delle tubazioni, depositi calcarei, sedimenti e materiali organici che possono accumularsi nel tempo. In queste condizioni la Legionella può trovare protezione all’interno di protozoi e amebe presenti nel biofilm, che ne favoriscono la sopravvivenza e la moltiplicazione.
La trasmissione all’essere umano
La trasmissione all’uomo avviene principalmente attraverso l’inalazione di aerosol contaminato. Docce, rubinetti, sistemi di
raffreddamento evaporativo, umidificatori e altre apparecchiature che generano acqua nebulizzata possono quindi diventare vettori di diffusione del batterio quando l’impianto non è gestito in modo adeguato. E qui sta il punto.
Se il problema nasce in fase di progetto: il rischio dei “rami morti”
Una volta compreso come funziona il meccanismo di proliferazione del microrganismo
e della sua trasmissione all’uomo, vediamo cosa si può fare per contenere il rischio: iniziamo con il dire che molte criticità legate alla Legionella trovano origine nella fase di progettazione degli impianti. Determinate configurazioni tecniche possono infatti favorire ristagni idrici o una distribuzione non uniforme delle temperature. Un caso frequente è rappresentato dai cosiddetti “rami morti”, ovvero tratti di tubazione che rimangono collegati alla rete ma non sono più utilizzati dopo modifiche o ristrutturazioni degli edifici. In queste sezioni l’acqua ristagna, il disinfettante residuo si degrada e il biofilm può svilupparsi senza interferenze.
E dei “ricircoli”
Anche un sistema di ricircolo dell’acqua calda sanitaria non correttamente dimensionato può contribuire alla formazione di zone
terminante nel controllo del rischio. Alcune pratiche diffuse nella gestione degli edifici possono infatti contribuire involontariamente alla proliferazione della Legionella. Un esempio riguarda la riduzione della temperatura dell’acqua calda sanitaria per contenere i consumi energetici durante i periodi di bassa occupazione: una scelta di questo tipo può portare l’impianto proprio nella fascia termica favorevole allo sviluppo del batterio.
Occhio ai punti di prelievo poco usati
Allo stesso modo, i punti di prelievo poco utilizzati rappresentano aree tipiche di ristagno. Rubinetti o docce utilizzati raramente consentono all’acqua di permanere nelle tubazioni per lunghi periodi, favorendo la perdita del disinfettante residuo e la crescita del biofilm.
da patologie croniche, condizioni che aumentano la vulnerabilità alla legionellosi. Nei casi di infezione acquisita in ambito ospedaliero, il tasso di letalità può arrivare fino al 30%, rendendo la prevenzione una priorità nella gestione della sicurezza sanitaria.
Strategie preventive
In tali casi le strategie di prevenzione devono quindi essere calibrate anche in base alla tipologia di pazienti presenti. Nei reparti che ospitano soggetti ad altissimo rischio (come, ad esempio, quelli destinati a trapianti o a pazienti oncologici ed ematologici), è necessario garantire livelli estremamente bassi o assenza del batterio nell’acqua utilizzata. In altri reparti, come geriatria, pneumologia o neonatologia, il controllo rimane comunque essenziale perché una contaminazione potrebbe essere molto pericolosa.

critiche. Se la circolazione non è adeguata, la temperatura dell’acqua può scendere nelle porzioni più distanti dell’impianto, entrando nella fascia termica favorevole alla proliferazione del batterio. Un ulteriore elemento di criticità è rappresentato dal sovradimensionamento dei serbatoi di accumulo, che aumenta il tempo di permanenza dell’acqua e favorisce la perdita dell’azione disinfettante residua.
La gestione quotidiana degli impianti
Oltre agli aspetti progettuali, la gestione operativa degli impianti gioca un ruolo de-
Un ruolo importante è svolto anche dalla manutenzione dei dispositivi terminali: aeratori, soffioni doccia e rompigetto tendono ad accumulare rapidamente calcare e materiale organico, creando microambienti ideali per la colonizzazione batterica.
Il caso delle strutture sanitarie: un tasso di letalità allarmante
Ma adesso addentriamoci ancor di più nel problema, con particolare riferimento alle strutture sanitarie. Se il rischio è presente in molti edifici civili, in ospedali e simili assume una dimensione particolarmente critica. I pazienti ricoverati sono spesso immunodepressi o affetti
Il monitoraggio microbiologico rappresenta uno degli strumenti principali per controllare la presenza della Legionella negli impianti idrici. Nelle strutture sanitarie i campionamenti vengono generalmente effettuati con frequenza trimestrale nei reparti ad alto rischio e almeno semestrale negli altri reparti. I punti di campionamento devono essere scelti in modo da rappresentare le aree più significative dell’impianto, ma l’interpretazione dei risultati richiede sempre cautela. La concentrazione del batterio può infatti variare sensibilmente da un punto all’altro della rete idrica e un risultato negati-
vo non esclude necessariamente la presenza di contaminazioni in altre zone dell’impianto.
Manutenzione e prevenzione: le azioni-chiave
Il controllo del rischio Legionella si basa su un insieme di attività tecniche e organizzative che devono essere accuratamente pianificate e documentate. Il monitoraggio delle temperature dell’acqua, il flussaggio periodico dei punti di utilizzo poco frequentati e la sostituzione programmata dei dispositivi terminali rappresentano alcune delle misure preventive più efficaci. In molte strutture - ed è una buona prassi - viene mantenuto un registro delle attività di manutenzione, che consente di tracciare gli interventi effettuati e le eventuali azioni correttive. Nei reparti con pazienti particolarmente vulnerabili possono inoltre essere installati filtri antibatterici terminali su docce e lavelli, per ridurre il rischio di esposizione all’aerosol contaminato.
Cosa fare in caso di contaminazione
Quando le analisi microbiologiche rilevano la presenza della Legionella, è necessario attivare misure correttive proporzionate al livello di contaminazione. Gli interventi possono includere disinfezioni shock dell’impianto, mediante iperclorazione o l’impiego di altri agenti disinfettanti come biossido di cloro, monoclorammina o perossido di idrogeno. In alcuni casi può essere necessario procedere anche alla pulizia e disincrostazione di serbatoi e tubazioni per rimuovere depositi minerali e materiali organici che potrebbero limitare l’efficacia dei trattamenti. Dopo l’intervento viene normalmente effettuato un nuovo campionamento microbiologico per verificare l’efficacia della bonifica.
Punto di partenza, la valutazione del rischio
Alla base di qualsiasi strategia di prevenzione vi è comunque la valutazione del rischio Legionella: occorre analizzare, attraverso questo documento tecnico, la configurazione dell’impianto, le modalità di gestione e manutenzione, le caratteristiche dell’acqua e la tipologia di utenti esposti. Questa analisi consente di individuare i punti critici della rete idrica e di definire un piano di controllo e monitoraggio adeguato alle specifiche caratteristiche della struttura.
Una prassi sistemica
Negli edifici complessi e, in particolare, nelle strutture sanitarie, la prevenzione della legionellosi non può essere considerata un
intervento occasionale. Deve invece diventare parte integrante della gestione ordinaria degli impianti idrici, attraverso un approccio sistemico che integri progettazione, manutenzione e monitoraggio microbiologico.
Contenere i rischi si può!
Chi gestisce un edificio, che sia un direttore sanitario, facility manager, responsabile della sicurezza, proprietario, ha una responsabilità precisa nei confronti delle persone che lo frequentano. Un impianto idrico non gestito correttamente non è solo un problema
tecnico: è un’esposizione al rischio normativo, reputazionale e, soprattutto, sanitario. La buona notizia è che il rischio Legionella è gestibile. Con le giuste competenze, con un piano strutturato e controlli periodici documentati, è possibile mantenere l’impianto in condizioni di sicurezza nel tempo, non reagendo alle emergenze, ma prevenendole.


Siparla spesso di automazione, meccanizzazione e robotica applicata anche alla pulizia professionale. L’evoluzione tecnologica ha infatti introdotto macchine sempre più sofisticate: lavasciuga automatiche, sistemi di dosaggio intelligente, robot autonomi per la pulizia dei pavimenti, piattaforme digitali di monitoraggio delle attività e via discorrendo. Non tutto, però, è automatizzabile: in un settore che si sta spingendo sempre più verso soluzioni evolute, ci sono ancora molti ambienti in cui il lavaggio manuale risulta imprescindibile.
Non tutte le pulizie sono automatizzabili
La ragione è semplice: tali contesti spesso presentano caratteristiche operative, strutturali o organizzative che rendono difficile
o inefficiente l’utilizzo esclusivo di macchine automatiche. Corridoi stretti, spazi ingombrati da arredi, superfici frammentate ma soprattutto la necessità di interventi mirati su aree con determinate caratteristiche richiedono ancora l’intervento diretto dell’operatore. In questi casi il lavaggio manuale, se eseguito con strumenti adeguati e secondo protocolli strutturati, rappresenta una soluzione estremamente efficace e controllabile.
In sanità, ad esempio… Prendiamo la sanità, ad esempio: il settore ospedaliero, inteso lato sensu, è uno degli esempi più evidenti di questa realtà. Ospedali, cliniche e strutture assistenziali sono ambienti complessi, caratterizzati da un’elevata frequentazione e dalla presenza costante di microrganismi potenzialmente patogeni che
Ci sono contesti, come quello sanitario, in cui la pulizia manuale gioca ancora un ruolo essenziale nel mantenimento di quell’igiene profonda essenziale per la sicurezza di tutti. E anche se non si parla di automazione, robotica o IA, la ricerca tecnologica ha moltissimo da dire. Addentriamoci dunque nel mondo di sistemi di lavaggio, carrelli e prodotti per una corretta gestione della pulizia manuale in ambito ospedaliero.
di Simone Finotti


vengono spesso trasportati dall’ambiente esterno. Si pensa spesso alle zone ad alto e altissimo rischio, ma anche nelle aree classificate a rischio basso (come corridoi, aree comuni, zone di degenza ordinaria, uffici o spazi di servizio) il controllo della contaminazione microbica deve essere continuo e sistematico.
Operazioni fondamentali per il controllo delle ICA
Si tratta di contesti in cui la gestione dell’igiene dei pavimenti non è solo un fatto estetico, ma anzi è parte integrante delle strategie di prevenzione delle infezioni correlate all’assistenza (le cosiddette ICA, chiamate anche infezioni nosocomiali, che sono ancora un vero flagello in Italia, numeri alla mano). È proprio in queste aree, come dicevamo, che i sistemi di lavaggio manuale assumono un ruolo centrale.
Il ruolo della tecnologia: dalle frange…
D’altra parte, sarebbe scorretto affermare che la tecnologia non vi ha nessun ruolo. Anzi, è vero l’esatto contrario: è proprio la ricerca tecnologica che, nonostante non si parli di automazione, robotica e intelligenza artificiale, ha permesso una rapida evoluzione del settore. Oggi il mercato offre moltissimi strumenti pensati ad hoc per la pulizia manuale di questi ambienti: l’utilizzo di frange, telai e sistemi di impregnazione controllata consente ad esempio di effettuare interventi frequenti, rapidi e mirati, mantenendo un elevato livello di igiene senza interferire con le normali attività sanitarie.
… a carrelli sempre più evoluti: piattaforme organizzative mobili
Non solo: a supporto di queste operazioni entrano in gioco i carrelli, veri e propri “si-
stemi organizzativi” mobili progettati per ottimizzare il lavoro degli operatori e garantire il rispetto delle procedure di sanificazione. I carrelli professionali destinati agli ambienti sanitari sono progettati per tenere separati in modo evidente i materiali puliti da quelli sporchi, riducendo il rischio di contaminazione crociata e di infezioni correlate alla degenza.
Funzionalità e sicurezza
Molti carrelli (quasi tutti, per la verità, quelli impiegati in ambito ospedaliero) sono dotati di scomparti dedicati per frange pulite, contenitori per quelle già utilizzate, supporti per sacchi rifiuti e spazi per i prodotti chimici a garanzia della massima funzionalità e sicurezza. In diversi sistemi attuali è prevista anche la gestione dei materiali pre-impregnati, che permette di utilizzare per ogni ambiente un panno già dosato con la quantità corretta di soluzione detergente o disinfettante. Questa modalità di lavoro migliora l’organizzazione e la standardizzazione delle operazioni e limita l’utilizzo eccessivo di acqua e prodotti chimici.
Il connubio con i prodotti chimici
Su questi ultimi occorre soffermarsi con attenzione, perché il connubio tra sistemi di lavaggio manuale e prodotti chimici idonei rappresenta un elemento-chiave per garantire risultati efficaci. Detergenti e disinfettanti specificamente formulati per l’ambito sanitario permettono di ridurre la carica microbica delle superfici, contribuendo al controllo della diffusione degli agenti patogeni. La corretta scelta del prodotto, insieme al rispetto delle corrette procedure operative, è fondamentale affinché l’intervento di pulizia non si limiti a un’azione meccanica ma diventi un vero processo di sanificazione (termine che, anche se spesso usato a sproposito, propriamente indica il connubio fra pulizia e disinfezione).
Cosa dice il mercato?
In questo scenario, dunque, il lavaggio manuale non deve essere interpretato come una pratica tradizionale destinata a essere superata dalle nuove tecnologie, ma come una modalità affidabile e spesso indispensabile - oltrechè altrettanto evoluta tecnologicamente - per affrontare le sfide del contesto sanitario, dove il mantenimento di un’igiene profonda è requisito essenziale per la sicurezza dei pazienti, degli operatori e dei visitatori. Ma ora lasciamo che siano i player del mercato a dire la loro.

Specifico per la pulizia di pavimenti e particolarmente indicato per superfici in gres porcellanato con l’ausilio di macchine lavapavimenti, Gres Whitener di Allegrini è un detergente a schiuma controllata pensato per la pulizia di pavimentazioni molto trafficate. Ad elevato potere sgrassante, rimuove in profondità ogni tipo di sporco, anche quello più ostinato e resistente. Il notevole potere sbiancante permette inoltre di ripristinare l’aspetto originale delle piastrelle ingrigite dal tempo. Ideale sia per la pulizia ordinaria sia per quella straordinaria. www.allegrinitopclean.com

IPER 4 Germicida Balsamico è un disinfettante detergente cationico ad alta efficacia germicida e battericida, registrato al Ministero della Salute con il n.2485. Grazie alla sua profumazione balsamica, svolge anche un’azione deodorante negli ambienti. Indicato per la disinfezione di superfici in ambito civile e professionale, come abitazioni, luoghi di ritrovo e industrie alimentari. In soluzione al 10% assicura un’igiene profonda senza danneggiare i materiali. Non macchia e rispetta gomma e plastica. Ideale per applicazioni manuali o a spruzzo, con asciugatura spontanea. www.bettaridetergenti.it

Sistema di lavaggio RFC di Rekola: un metodo di pulizia “Residue Free Cleaning” che permette di igienizzare superfici anche senza l’uso di detergenti, riducendo tempi e residui. Il sistema è composto dal tergipavimento Power Squeegee e dai panni in ultra microfibra MopCloth H. È certificato con risultati di rimozione fino al 99,95% dei batteri e del 93,8% dello sporco con un solo passaggio del panno e per la ridotta dispersione di microplastiche durante i lavaggi in lavatrice (classe A). Il sistema garantisce quindi elevati standard igienici e sostenibilità, unendo efficacia di pulizia, ridotto impatto ambientale e ottimizzazione dei consumi. www.calitalia.com

Dianos propone una linea di detergenti a base cloro specifici per l’igiene in ambito sanitario: Igiencloro Hospital.
Il sodio ipoclorito ha un ampio spettro d’azione e un elevato potere battericida ed è stato approvato come principio attivo biocida. Diactive Hospital. Detergente igienizzante alcalino clorattivo non schiumogeno, indicato per la pulizia di pavimenti, pareti e superfici. Specificatamente consigliato per il settore ospedaliero e le case di cura. Indicato per il lavaggio meccanico di pavimenti e superfici, oltre che per uso manuale.
In ottemperanza al regolamento 528/2012 (Biocidal Product Regulation) Dianos ha presentato, entro i termini previsti, il dossier per i prodotti biocidi a base di sodio ipoclorito. www.dianos.net
Nei contesti sanitari, il lavaggio manuale dei pavimenti resta uno strumento essenziale per il controllo delle contaminazioni ambientali. In questo scenario si inserisce il sistema PCHS® (Probiotic Cleaning Hygiene System), che utilizza detergenti probiotici capaci di agire per biocompetizione contro i microrganismi patogeni. A differenza dei detergenti chimici tradizionali, l’effetto igienizzante è stabile e prolungato fino a 24 ore, rafforzandosi progressivamente nel tempo. Studi scientifici indipendenti ne confermano sicurezza per la salute e minore impatto rispetto alla chimica convenzionale. www.pchs.it

Con Kubi Kid la sicurezza dei carrelli incontra la fantasia dei bambini. Kubi Kid di Falpi nasce infatti per portare la praticità del carrello Kubi negli spazi dedicati ai bambini, come ospedali pediatrici, scuole dell’infanzia e centri educativi. Conserva la compattezza, l’ergonomia e la versatilità della linea originale, ma aggiunge una componente ludica e un tono più accogliente grazie a stickers personalizzabili con temi diversi. La struttura chiusa aiuta a proteggere contenuti e attrezzature, limitando l’accesso dei più piccoli e contribuendo a mantenere ordine e sicurezza. www.falpi.com

Nelle aree sanitarie a basso rischio, l’efficacia del lavaggio manuale dei pavimenti dipende dalla corretta integrazione tra attrezzature e detergenti specifici. Il Disinfettante Multisuperfici Fulcron (Reg. Min. Sal. N° 21109), disponibile nei formati 5 l e 750 ml, è una soluzione pronta all’uso a base di sali quaternari d’ammonio che elimina il 99,9% di virus, funghi e batteri da tutte le superfici lavabili, inclusi i pavimenti. Presidio Medico Chirurgico e idoneo ai piani HACCP, assicura un’azione detergente e disinfettante efficace, risultando indicato per strutture sanitarie, ambienti professionali e altri contesti dove l’igiene quotidiana è fondamentale. www.fulcronpro.it

Nei reparti ospedalieri e nelle aree di passaggio è essenziale utilizzare detergenti efficaci e a rapida asciugatura. Icefloor Star è un detergente liquido concentrato studiato per la pulizia e l’igiene di superfici in ceramica, anche porose, superfici resilienti trattate, non richiede risciacquo. La formula idroalcolica favorisce una rapida evaporazione, assicurando un’igiene profonda senza intaccare i materiali più delicati. In un solo passaggio rimuove lo sporco, non lascia residui né aloni e dona brillantezza alle superfici, diffondendo un gradevole profumo di lavanda. Prodotto professionale disponibile in taniche da 5 litri. www.icefor.com

Premiato con “Ecolabel Award 2021”, è il consolidato sistema di pulizia delle superfici, praticato mediante mops e panni in microfibra, noleggiati e ricondizionati dopo ogni impiego. I dispositivi vengono forniti asciutti, preimpregnati a secco con la corretta quantità di principio attivo detergente. Dopo ciascun utilizzo, la rimozione di sporco e microrganismi è praticata all’interno di stabilimenti di lavanderia industriali, seguendo protocolli di ricondizionamento certificati RABC UNI EN 14065:2016, assicurando l’interruzione di ogni potenziale catena infettiva. Così facendo, l’operatore può dedicarsi esclusivamente alla sanificazione delle superfici. www.limlavanderia.it


In ambito detergenza Paredes ha più gamme da offrire ai suoi clienti. Per rispondere al meglio alle necessità delle gare d’appalto e i requisiti del GPP, propone la linea Paredes - alla base di queste nuove gamme di produzione europea un minor consumo di energia e una gestione consapevole dei rifiuti con packaging unimateriale e un ottimo rapporto qualità prezzo. Gamme complete per l’igiene delle cucine, del bucato, della persona e delle superfici vanno ad affiancarsi ai prodotti biotecnologici di alta gamma, tutti con codice colore per una gestione facilitata. www.paredes.it

Pavixan è un detergente concentrato multifunzione della linea Oxycare® raccomandato per aree a basso rischio all’interno di strutture sanitarie.
Prodotto che svolge le seguenti funzioni: detergente, brillantante, igienizzante, previene lo sviluppo di muffe e combatte i cattivi odori.
Oltre alla funzione di lavapavimenti che può svolgere sia tramite applicazione manuale che in macchina lavasciuga, può essere diluito per la pulizia e l’igiene quotidiana di tutte le superfici lavabili in aree a basso rischio. www.sochilchimica.it

Antisapril e Kastel, ora proprietà del Gruppo Sutter, offrono soluzioni efficaci e certificate per il lavaggio e la disinfezione anche nelle aree a basso rischio. In aggiunta i formati tanica 5 kg vantano la certificazione Plastica Seconda Vita (95% riciclata) e la CFP calcolata secondo ISO 14067. Le formulazioni superano le principali norme EN di attività battericida, fungicida, virucida e sporicida. Kastel Disinfettante è PMC n. 17498; Antisapril Disinfettante PMC n. 99/41; Antisapril Disinfettante Detergente PMC n. 18210. Una gamma affidabile, sostenibile e conforme ai più rigorosi protocolli sanitari. www.antisapril.it

Mikroraso: i ricambi Taxon della linea per il lavaggio e la disinfezione dei pavimenti sono prodotti con materiali selezionati per permettere i massimi risultati in termini di sanificazione degli ambienti. Frangia in microfibra bianca con base in poliestere per aggancio con sistema gancio uncino. Può essere utilizzata a secco per lo spolvero o umido per il lavaggio giornaliero di pavimenti interni (alberghi, uffici, ospedali, stazioni, aeroporti, industrie, magazzini) con basso livello di sporco. L’etichetta in 4 colori permette di evitare la contaminazione incrociata coi vari colori per ambiente. www.taxon.it

Anche nelle aree a basso rischio, ottimizzare le operazioni di cleaning senza compromettere gli standard igienici è fondamentale. Il sistema Touch Free, integrato in RenovaLoop™, consente di gestire la frangia senza contatto diretto con le mani, riducendo il rischio di contaminazione tra le diverse zone operative. Una soluzione che migliora l’efficienza del lavoro quotidiano, mantenendo costante il livello di sicurezza e qualità in ogni ambiente, perché un sistema efficace garantisce sempre lo stesso standard. www.vdm.it


Tanet SR 15 di Werner & Mertz Professional è un detergente di manutenzione studiato per garantire elevate prestazioni nella pulizia quotidiana di pavimenti e superfici lavabili. Grazie all’elevato potere bagnante, agisce efficacemente anche su superfici porose o idrorepellenti, rimuovendo sporco e grasso senza lasciare aloni. Utilizzabile a basse concentrazioni, consente di ottimizzare tempi e consumi. La formulazione, basata in gran parte su materie prime da fonti rinnovabili, riflette l’impegno dell’azienda nello sviluppo di soluzioni professionali efficaci e al tempo stesso attente alla sostenibilità ambientale.
www.wmprof.com


Città per e in salute: Ecomondo 2026 ci porta nel futuro dell’urban health
L’evento di IEG mette al centro la città salubre e sostenibile nel distretto dedicato “Circular Healthy City”. Nature-based solutions, qualità dell’aria, parchi della salute, edilizia sostenibile, tecnologie intelligenti per città che curano. All’interno di Ecomondo 2026, l’evento di Italian Exhibition Group divenuto il punto di riferimento in Europa e nel bacino del Mediterraneo per la green, blue e circular economy, va in scena per il 3° anno il Circular Healthy City district. Si tratta di un’area espositiva e convegnistica dedicata all’evoluzione degli ambienti urbani in ottica “One Health”, integrando i principi della circolarità ambientale con quelli della salute umana. Decisori pubblici, progettisti e stakeholder in ambito sanitario e urbano troveranno negli spazi della Fiera di Rimini dal 3 al 6 novembre un hub dove confrontarsi su soluzioni concrete e casi studio in
ambito green constructions, rigenerazione e riforestazione del territorio, tecnologie AI e IoT, gestione circolare delle risorse. Il progetto è coordinato da un Comitato Tecnico Scientifico di eccellenza, composto tra gli altri da esponenti di UniBo, CINECA, FBK, Unesco Chair on Urban Health e Green Building Council Italia, per un evento utile a integrare best practices e direttive europee. www.ecomondo.com
Negli ambienti ospedalieri, il controllo della contaminazione rappresenta una delle sfide più critiche per garantire sicurezza e qualità del servizio. Le attrezzature utilizzate nelle operazioni di pulizia, se non adeguatamente progettate e gestite, possono diventare
esse stesse un potenziale veicolo di diffusione batterica, compromettendo l’efficacia dei protocolli di sanificazione. Per questo oggi non è più sufficiente scegliere singoli prodotti, ma adottare un approccio integrato basato su sistemi progettati per controllare ogni fase del processo di cleaning. RenovaLoop™ nasce con questo obiettivo: un sistema sviluppato per le strutture sanitarie che integra carrelli modulari, microfibra certificata, processi di pre-impregnazione controllata e materiali con protezione antibatterica, contribuendo a ridurre il rischio di contaminazione crociata e migliorare l’efficienza operativa.
A questo si affianca un approccio orientato alla sostenibilità, basato sull’utilizzo di materiali riciclati e su un modello di recupero, rigenerazione e riutilizzo delle attrezzature lungo il loro ciclo di vita. Un sistema che rende il cleaning più sicuro, controllato e responsabile, in linea con le esigenze delle strutture ospedaliere moderne. www.vdm.it


crescita europea e impegno sostenibile
Paredes Italia, ramo italiano del Groupe Paredes Orapi (GPO), opera da oltre 80 anni nel settore dell’igiene e della pulizia professionale. Da sempre specializzata nell’asciugatura e nell’igiene delle mani, l’azienda ha progressivamente ampliato la propria offerta, diventando un fornitore di prodotti e servizi a 360° e affermandosi oggi come uno dei principali punti di riferimento in Europa. Paredes ha registrato una crescita significativa a seguito dell’acquisizione di Orapi nel 2023 e punta ora a posizionarsi tra i primi tre player in Europa. In questa prospettiva, il progetto si è recentemente ampliato con l’acquisizione di Toussaint Francia e Redelux, consolidando il ruolo di GPO come numero uno in Francia e rafforzandone la presenza anche nel Benelux.
Oltre alla solidità e al rilievo del Gruppo, Paredes Italia si distingue per i valori di af-
è una consolidata realtà produttiva e commerciale specializzata nella fornitura di un’ampia gamma di prodotti per la disinfezione e la detersione di strumenti chirurgici, ambiente e superfici. I prodotti Amedics oltre a disinfettare sono quindi in grado di svolgere un’azione detergente, con il vantaggio di una ottimizzazione dei tempi e di una maggiore sicurezza ambientale. Le nuove normative e una maggiore sensibilità, da parte degli operatori e dei loro clienti alle problematiche igienico sanitarie, stanno cambiando significativamente le modalità con le quali vengono disinfettati ambienti e superfici. Amedics è focalizzata nella formulazione e nella produzione di prodotti destinati all’impiego su strumenti chirurgici che se non correttamente trattati possono trasferire microorganismi patogeni pericolosi per la salute (come per es. studi medico-dentistici, RSA, centri estetici e spa). I prodotti Amedics garantiscono efficacia e sicurezza; la presenza all’interno delle

fidabilità e partnership che offre ai propri clienti, tra cui imprese di pulizia, industrie, collettività e strutture sanitarie. È proprio in ambito sanitario che l’azienda ha conosciuto uno sviluppo particolarmente significativo, arrivando oggi a servire oltre 200 ospedali in Italia. Grazie a una copertura capillare su tutto il territorio nazionale, basata su un hub logistico centrale e su magazzini locali, è in grado di garantire consegne rapide dei prodotti e interventi tempestivi del proprio servizio tecnico. Un altro elemento distintivo


è rappresentato dalla Responsabilità Sociale d’Impresa, confermata dalla recente valutazione EcoVadis Platino, che riflette pienamente i pilastri della missione di Paredes: accompagnare i propri clienti nel rendere il mondo professionale più pulito, più sicuro e più rispettoso dell’ambiente. www.paredes.it

formulazioni di attivi disinfettanti permettono un adeguato e completo rispetto di protocolli creati per proteggere e soddisfare una clientela sempre più attenta. I consumatori e i pazienti si sentono più sicuri nell’utilizzare servizi medici e strutture collegate all’ospitalità, che garantiscono un’igiene di alto livello. I formulati Amedics sono tutti registrati come Dispositivi medici e PMC, hanno quindi una comprovata efficacia, garantita da test approvati a livello Europeo. L’Azienda, presente da oltre vent’anni sul mercato, è diventata sem-
pre più un punto di riferimento per i suoi clienti mettendo a disposizione la grande esperienza maturata nel settore della disinfezione, ha inoltre continuamente ampliato e aggiornato il suo catalogo con lo scopo di mettere a disposizione degli operatori tutto ciò che serve per la pulizia e la disinfezione delle loro strutture, supportandoli anche con corsi di formazione ed aggiornamento, al fine di proporre gli strumenti idonei per arginare rischi di potenziali contaminazioni. www.amedics.eu
L’igiene è un elemento chiave per la prevenzione delle infezioni, attraverso la riduzione del rischio di contaminazione. La pulizia delle superfici ad alta frequenza di contatto (come letti ospedalieri, maniglie, carrelli e dispositivi medici) è oggi considerata un fattore determinante nella prevenzione delle infezioni correlate all’assistenza. L’utilizzo di disinfettanti ad ampio spettro, combinato con protocolli rigorosi e sistemi di controllo qualità, è essenziale per garantire la sicurezza dei pazienti e degli operatori. In questo contesto, Sochil agisce su più fronti: la
pulizia e la disinfezione di ambienti e superfici attraverso la gamma MEDCleaning e in parallelo le proposte dedicate alla cura della biancheria attraverso i programmi a basse temperature SafeLaundry, con l’obiettivo di rispondere alle esigenze del mercato con soluzioni certificate e performanti, destinate ad incrementarsi con il tempo. Il portafoglio dei disinfettanti MEDCleaning include attualmente i seguenti P.M.C. e Biocidi: SOQUAT [P.M.C.]: P.M.C. deter-disinfettante con Sali quaternari, deodorante concentrato, raccomandato per pavimenti e superfici lavabili (Imprese/sanitario).
IGIESAN [P.M.C. Biocida]: P.M.C. Biocida deter-disinfettante con Sali quaternari, inodore concentrato raccomandato per pavimenti e superfici lavabili (imprese/alimentare/sanitario).
IGIESAN RTU [P.M.C. Biocida]: P.M.C. Biocida deter-disinfettante con Sali quaternari, inodore concentrato per superfici lavabili (Imprese/ alimentare/ sanitario).

ALCOVIR [P.M.C.]: disinfettante a base alcolica pronto all’uso per superfici lavabili (alimentare/sanitario).
ALCOVIR GEL [P.M.C.]: disinfettante a base alcolica per la disinfezione delle mani (igiene personale).
KLINOX/05 [in fase di approvazione Biocida]: disinfettante candeggiante a base di acido peracetico per la disinfezione della biancheria (lavanderia).
SANITIX [in fase di approvazione Biocida]: disinfettante per industria alimentare (alimentare). www.sochilchimica.it
settore sanitario, dove l’igiene è una priorità assoluta, Nilfisk si propone come partner strategico per tutte le strutture che vogliono coniugare standard elevati di pulizia, sostenibilità e innovazione tecnologica. L’obiettivo è chiaro: garantire risultati di pulizia affidabili e costanti, soprattutto nelle aree ad alto rischio, riducendo al contempo l’impatto ambientale e la complessità operativa. Le soluzioni Nilfisk sono progettate secondo un principio di controllo intelligente delle risorse. Sistemi avanzati consentono di adattare l’azione di pulizia alle diverse superfici e condizioni operative. Questo approccio permette di ottenere prestazioni elevate utilizzando solo le risorse realmente necessarie, supportando concretamente le strategie di sostenibilità delle strutture sanitarie. Grande attenzione è riservata anche al comfort di pazienti e operatori. Attrezzature silenziose permettono di operare in modo discreto, riducendo al minimo le interferenze con le attività cliniche e contribuendo a creare ambienti più tranquilli e favorevoli alla cura. La visione Nilfisk va oltre la singola macchina. Grazie a soluzioni di connettività in cloud, le strutture possono monitorare le flotte da remoto, accedere a report operativi e migliorare il controllo dei processi. Un supporto che si completa con servizi di assistenza e formule di noleggio personalizzate, pensate per offrire una visione chiara del Total Cost of Ownership e semplificare la pianificazione economica. Affidabilità, sostenibilità e innovazione guidano l’impegno di Nilfisk nel supportare ospedali e case di cura nella creazione di ambienti più sicuri, efficienti e pronti alle sfide future. www.nilfisk.com/it-it/

nei prodotti chimici per l’igiene
Christeyns è un’azienda fortemente impegnata nella sostenibilità ambientale, integrando criteri ecologici in tutte le fasi del ciclo di vita dei suoi prodotti chimici per l’igiene. Dalla progettazione alla produzione, fino alla distribuzione e al riciclo, ogni passaggio viene attentamente valutato per ridurre l’impatto ambientale senza compromettere la qualità e l’efficacia. Durante la fase di sviluppo, Christeyns sceglie ingredienti biodegradabili e riduce al minimo l’uso di sostanze nocive. Anche il processo produttivo è ottimizzato per limitare emissioni di CO2 e consumo di risorse naturali, mentre la logistica è organizzata per massimizzare l’efficienza nei trasporti. L’attenzione si estende anche all’uso finale dei prodotti, supportando i clienti nel risparmio idrico ed energetico, e al fine vita, promuovendo soluzioni di riciclo e riutilizzo per ridurre i rifiuti. L’impegno di Christeyns è dimostrato dalla certificazione ecologica del
un’offerta completa per l’igiene degli ambienti di lavoro
La Casalinda opera da oltre quarant’anni nel settore del cleaning professionale, proponendosi come partner strutturato per aziende e operatori che necessitano di soluzioni affidabili per l’igiene, la pulizia e la sanificazione degli ambienti e delle attrezzature. L’approccio dell’azienda unisce consulenza, fornitura e servizio, accompagnando il cliente nella scelta dei prodotti, dei macchinari e dei sistemi più idonei alle specifiche esigenze operative, con particolare attenzione all’efficacia e alla sostenibilità ambientale. Grazie a un’esperienza consolidata e a un’offerta ampia e costantemente aggiornata, La Casalinda è in grado di rispondere in modo efficace alle esigenze di molteplici settori professionali.

12% della sua produzione totale e dall’ampia gamma di oltre 100 prodotti con etichette ambientali riconosciute, tra cui Ecolabel UE, Nordic Swan ed Ecocert. Questo impegno è stato premiato nel 2022, quando Christeyns ha ottenuto il riconoscimento come azienda con il maggior numero di licenze Ecolabel UE, consolidando il suo ruolo di leader nella chimica sostenibile.
Il logo aziendale, caratterizzato dai colori verde e blu, riflette la filosofia di Christeyns: innovare nel rispetto dell’ambiente. Con una visione basata sulla circolarità e sulla responsabilità ambientale, l’azienda continua a sviluppare soluzioni che combinano efficienza e sostenibilità, contribuendo a un futuro più pulito e sicuro per tutti.
www.christeyns.com/it
Gli ambiti di applicazione nei quali opera comprendono:

SANITÀ: da oltre 40 anni serve ASL, grandi ospedali e strutture private. È specializzata nella fornitura di prodotti per la cura della persona e degli ambienti in ambito sanitario e assistenziale, garantendo elevati standard di sicurezza tramite sistemi certificati di pulizia e sanificazione, prodotti CAM ed ECOLABEL, attrezzature antibatteriche e macchinari professionali. Propone inoltre soluzioni per la sanificazione di superfici e aria e materiale monouso per la conservazione degli alimenti.

IMPRESE DI PULIZIA: attraverso consulenza tecnica e una gamma completa di macchine per la pulizia civile e industriale, lavasciuga, spazzatrici, aspiratori industriali monofase e trifase, accessori e prodotti studiati per differenti superfici.

INDUSTRIA: con soluzioni orientate alla pulizia professionale di ambienti produttivi, all’aspirazione industriale anche in contesti complessi e all’impiego di attrezzature e prodotti ad alte prestazioni.

MePA: iscritta e presente ai Bandi Materiale Igienico Sanitario; Bandi Beni Raccolta Rifiuti, Sacchi e Attivatori; Bandi Arredi e Complementi di Arredo; Bandi Beni e Servizi per la Sanità; Bandi Prodotti, Materiali e Strumenti per Manutenzioni; Bandi Cancelleria ad uso Ufficio e Didattico.
Con un’organizzazione logistica efficiente consente consegne e interventi tempestivi su tutto il territorio nazionale, rafforzando il posizionamento dell’azienda come interlocutore unico per il cleaning professionale.

www.lacasalinda.com

